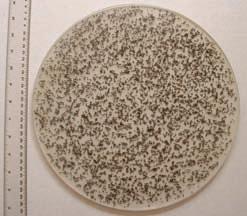

RADIO
CLUB OF AMERICA
Proceedings
Looking back. Moving forward.
In this issue we highlight RCA’s fall 2022 and early 2023 events and invite you to our forthcoming activities.






IN THIS ISSUE:
RCA’s 2023 Banquet and Technical Symposium Details Paradigms, Cell Phones, and the Contributions of RCA Members to the World RCA Interview with Dr. Marty Cooper



NASA and HAARP Conclude Asteroid Experiment RADIO CLUB OF AMERICA
VOLUME 94, NUMBER 1 | SPRING 2023




PROCEEDINGS • SPRING 2023 WWW.RADIOCLUBOFAMERICA.ORG 2
2023 BOARD OF DIRECTORS
PRESIDENT
David P. Bart*
EXECUTIVE VICE PRESIDENT
Don Root*
VICE PRESIDENT
Rich Berliner*
VICE PRESIDENT/COUNSEL
Chester “Barney” Scholl, Jr.*
VICE PRESIDENT/CO-COUNSEL
Edward Ryan*
TREASURER
Ronald J. Jakubowski*
SECRETARY
Margaret J. Lyons, PE, PMP*
DIRECTORS
JonPaul Beauchamp
Ernie Blair
Dr. James Breakall
Karen Clark
Verle “V.G.” Duvall
Michael Kalter
Charles Kirmuss
PRESIDENTS EMERITI
Steven L. Aldinger
Denis Marin
Bruce Mcintyre
Carole Perry
Stanley Reubenstein
Paul Scutieri
Dr. Julio Urbina
Mal Gurian
Sandra Black Carroll Hollingsworth*
Philip Casciano
Mercy Contreras
Timothy Duffy
John Facella P.E.
STAFF
Bruce McIntyre
Stan Reubenstein
Anthony Sabino, Jr.
Amy Beckham, Administrative Director
Kathy Sheridan, Membership & Order Fulfillment
Maria Olaez, Bookkeeper
COMMITTEE CHAIRPERSONS
Awards & Fellows: Bruce McIntyre
Banquet: Margaret Lyons* / Denis Marin
Bequests & Legacy Giving: Open
Constitution & By-Laws: Chester “Barney” Scholl, Jr.*
Education: Julio Urbina
Fellows: Bruce McIntyre
Finance: Phil Casciano / Ron Jakubowski*
Fundraising: Jane Winter* / Karen Clark
Historical/Museums & Archives: Carroll Hollingsworth*
Interview & Networking Series: Tim Duffy / John Facella*
Marketing: Jon Paul Beauchamp
Onboarding: Barney Scholl
Mentoring Project: Paul Scutieri
Membership: Margaret Lyons* / Don Root
Member Services, Women in Wireless: Ellen O’Hara

Member Services, Young Professionals: Open
Member Services, Mid-Career: Keith Kazmarek
Member Service, Senior Career & Retired: Don Root
Nominations & Elections: Rich Berliner
Operations Handbook: Bruce McIntyre
Publications: David P. Bart*
RCA Radio Amateur Club License: Ed Ryan*
RCA Regional Conferences: Ernie Blair
Rocky Mountain Section: Karen Clark /Mercy Contreras
Scholarship Fund: Alan Spindel
Sponsors: Jane Winter* / Karen Clark
Strategic Planning: David Bart*
Technical Symposium: Jim Breakall
Website: Amy Beckham / John Facella*
Youth Activities: Carole Perry
*Executive Committee Member
TECHNICAL EDITOR
John S. “Jack” Belrose, Ph.D., VE2CV 811-1081 Ambleside Dr. Ottawa, ON K2B 8C8, Canada (613) 721-7587; jsbelrose@gmail.com
EDITORIAL DIRECTOR
David P. Bart 8512 Kedvale Ave. Skokie, IL 60076 (847) 542-9873; jbart1964@gmail.com
ADVERTISING CONTACT
Amy Beckham (612) 430-6995; Amy@radioclubofAmerica.org
PRODUCTION
Sapphyre Group
PROCEEDINGS SCIENTIFIC ADVISOR
Nathan “Chip” Cohen, Ph.D.
PROCEEDINGS • SPRING 2023 WWW.RADIOCLUBOFAMERICA.ORG 3 VOLUME 94, NUMBER 1 SPRING 2023 HEADQUARTERS OFFICE: 7042 East Fish Lake Road Maple Grove, MN 55311 (612) 405-2012 amy@radioclubofamerica.org www.radioclubofamerica.org CONTENTS From Your President 4 Congratulations to RCA’s 2022 Banquet Participants and Award Recipients 8 RCA’S 2022 Lifetime Achievement Award Acceptance ....................................................................9 Reprint: Sculptured Thin Films: Accomplishments and Emerging Uses ..................................... 10 Reprint: Meet the Metamaterials 18 RCA’S 2022 Wireless Innovation Award Acceptance 27 2022 RCA Fellows Acceptance 28 RCA Tours Georgia Tech 29 RCA’s 2022 Technical Symposium Was a Huge Success! 32 2023 RCA Technical Symposium .......................................................................................................... 33 Candids From the 2022 Symposium & Banquet ............................................................................. 34 RCA’S 2023 Banquet to Feature Dr. Marty Cooper In Denver 39 Welcome New Members! 43 RCA Interview with Dr. Marty Cooper about the First Handheld Mobile Telephone 44 Paradigms, Cell Phones, and the Contributions of RCA Members to the World 52 Andrew Seybold, Recipient of the 2023 IWCE Connecting Critical Communications Award, Passes Away 60 Silicon Valley Dispatches: Housing vs Telecom ................................................................................ 65 Reprint: Crucible of Communications: How Amateur Radio Launched the Information Age and Brought High Tech to Life 70 Lawsuit Filed Over Preserving Bell Laboratories’ Holmdel Horn Antenna 76 Industry Updates AMSAT Recruiting Engineering Volunteers 80 Congressional Bills Address Amateur Radio in the 2023-2024 Session 81 Researchers Successfully Grow Electrodes in Living Tissues ................................................... 82 NASA and HAARP Conclude Asteroid Experiment 83 Millimeter Wave Radar System Keeps Drivers Safe on The Road 85 Sound Waves Propagating In One Direction Break Light Transmission Reciprocity 88 Testing For Coexistence in Crowded and Contested RF Environments 89 Physicists Perform First Measurement of ‘Time Reflection’ in Microwaves 90 RCA News Items Radio Club of America Recognizes Women of Achievement in the Wireless Industry ...... 92 2023 Hamvention Technical Achievement Award to RCA Fellow, Dr. James Breakall 94 TMA Honors Louis T. Fiore’s Lifetime Contribution with Everlasting Scholarship 95 RCA Announces New Carole Perry RCA Young Professional Award 96 Video Release: Dr. Martin Cooper on the 50th Anniversary of his Cell Phone Call 96 Update On Youth Activities 97 Dr. Ulrich Rohde Receives the 2023 IEEE Communications Society Distinguished Industry Leader Award.................................................................................................................... 98 Wireless Infrastructure Association (WIA) and RCA Announce New Partnership 100 Radio Club of America Focusses on Marketing in 2023 101 Radio Club of America Has A New Look And Attends Many Spring 2023 Shows 102 Candids from IWCE 103 RCA Announces New Free Training Module “Introduction to Wireless” 104 AWA Commitment To Education For All Ages 105 Silent Keys ................................................................................................................................................... 107 Business Directory 111 RCA Calendar & Events 113
Proceedings
RADIO CLUB OF AMERICA
Greetings to our RCA Members! I hope you will enjoy this spring 2023 edition of the Proceedings of the Radio Club of America. There is considerable news and significant number of articles to share. This issue reflects themes of recovery and renewal. The pandemic is behind us. Live events have returned. Activity levels are up. It is great to see people that we have missed these past few years. RCA is back and on the move!
110 YEARS OF THE PROCEEDINGS
The bi-annual Proceedings is our opportunity to talk directly to you, our members, about what is going on at RCA. The Proceedings, released each May and October, shares industry news, RCA news, feature articles, and many announcements about our members. Since 1913, 110 years ago, the Proceedings has kept you, our members, in touch with RCA and provided in-depth reporting about RCA and the activities of our membership. The RCA ENews and formerly the Aerogram kept you up to date, but the Proceedings is the detailed report. Congratulations to everyone who has contributed to these pages for more than a century! You have left an amazing record of our members and of RCA. Past issues are available online at www. radioclubofamerica.org/Proceedings. An index of the first hundred years, 19132013, is available on the website
RCA INDUSTRY EVENTS
So far in 2023, RCA has participated in the following industry events. We have a new booth, new marketing materials, and a renewed presence, thanks to Amy Beckham and the Sapphyre Group and our many volunteers. We were well represented at Orlando Hamcation in February, NATE in February, and IWCE this past March. We had a booth for the first time at Connect(X), and we will be
participating in the upcoming Dayton Hamvention in May. Welcome back!! We look forward to participating in a number of industry events later in 2023 as well, including the UTC Telecom & Technology Conference in June and APCO in August. We also plan to participate in the Women in Wireless forum at MTUG in August, and WISPALOOZA in October. See the RCA calendar for more information. Don’t forget that our RCA Technical Symposium and Banquet takes place in November. See the RCA website for more information.
We are really stepping up RCA’s involvement in the industry. This is a year of evaluation as we think about 2024. What shows do you want to see RCA participate in? Which shows should we drop? We need your input and involvement. Please contact Amy Beckham at amy@radioclubofamerica. org or me at jbart1964@gmail.com to discuss your ideas.
WIRELESS INNOVATION
RCA has updated its branding to focus on our major value offerings. RCA: FOSTERING WIRELESS INNOVATION is a theme that you will see in our new marketing materials, website, publications, and other venues. The concepts that our value is our members, and our members and RCA are fostering innovation are key.
Our many activities largely involve networking and educational opportunities, both live and online. The quality of these programs depends on the high quality of the people involved. RCA has a legendary reputation for bringing together a rare and unique group of highly talented and gifted people, our members, who enjoy sharing time together. Never forget that it is all about YOU So, come join us!
AN INVITATION
We invite you to look at our new materials and to share them with others as we target membership growth as a
top priority in 2023. Please stop and see us at the many industry events we are involved in. Please bring us your ideas and your energy. Get involved!
Several RCA members are speaking at an Innovation Forum during the Dayton Hamvention (see related announcement in this issue). The theme for Dayton’s 2023 activities is “Innovation.” This special panel will discuss their experiences addressing common themes, challenges, current developments, and the ties between professionals and amateurs as we all try to innovate or support the world of wireless.
RCA is proud to be associated with and to support these types of activities and these well-known innovators as they make their many contributions to our world.
RCA’S 2023 BANQUET WEEKEND IN DENVER
The banquet and technical symposium committees are working hard to bring you a phenomenal set of activities in November at our annual extravaganza. We look forward to seeing everyone in Denver on November 18. Please see the information in this issue to save the date and watch the RCA website for new information during the coming months.
Dr. Marty Cooper will be one of several headliners as we celebrate 50 years of handheld wireless phones, famously demonstrated on the streets of Manhattan in 1973. We encourage all of you to come to Denver and to enjoy these live, fun filled, and energizing activities as we network, learn, and share in the thrills of the art and science of wireless.

CHANGES UNDERWAY AT RCA
We are working hard to modernize RCA. We have many accomplishments to be proud of, and much work still to do. In the first half of 2023, we have:
4 PROCEEDINGS • SPRING 2023 WWW.RADIOCLUBOFAMERICA.ORG
FROM YOUR PRESIDENT
• developed all new marketing materials and a new booth for participating in industry tradeshows;
• completely revised and updated the media kits used in marketing our publications and our sponsorships –these are anticipated to be available in May;
• investigated whether to replace or redevelop the RCA website, opting to make some current revisions and then to undertake major upgrades during summer 2023;

• automated many accounting and billing functions as part of a complete revamping of our office functions;
• tied many of the membership systems to the automated accounting functions – our goal is to simplify and to be easily accessible for providing member services;
• redesigned the format of the Proceedings and other publications
• refocused on expanding our corporate partnerships and involvement with industry leaders; and
• participated in more industry shows and activities as we upgrade our services and decide what new events we want to target in 2024.
We are achieving success. Membership is on the rebound, adding approximately 100 new members in just these past several months. We have also attracted several new corporate memberships and attention from several new companies who are interested in being associated with and participating in the world’s most prestigious and oldest wireless society.
We are charged up and charging ahead in 2023. Come and join us in the new RCA!!
EDUCATION
RCA continues to host the Women In Wireless events and the RCA Interviews series. Both of these activities offer wonderful ways to meet leaders who are making a difference in our wireless world. The archives of the RCA Interview series feature nearly 50 interviews. Started prior to the pandemic, and
now emerging from Zoom meetings held during the pandemic, the Women In Wireless program also offers live activities. Please stay tuned by reading the RCA ENews and the RCA Website for current information about these opportunities.
RCA is proud to be associated with these leaders. We ask our members to get involved, bring us more people to meet, and share your knowledge and contacts. You will enjoy the friendships and the discussions!
YOUTH, SCHOLARSHIPS, AND MENTORSHIP
RCA’s Youth Activities, RCA Scholarships, and the new RCA Mentorship Program are all flourishing. Consider that we now offer support, guidance, and scholarships that can bring someone from grammar school, through their teenage years and college, and into their careers. These are amazing accomplishments. Many people are responsible for providing these opportunities that are developing the next several generations of leaders
Save the Date! 2023 Technical Symposium and 114th Awards Banquet SATURDAY, NOVEMBER 18, 2023 DENVER, COLORADO
PROCEEDINGS • SPRING 2023 WWW.RADIOCLUBOFAMERICA.ORG 5
We’re AFC, Your FCC Coordination Experts
EXPERIENCED · ACCURATE · COMPREHENSIVE
We get it right the first time. AFC is a team of experts who will help you with every aspect of your FCC radio frequency coordination needs. The goal is to get you on track and on budget.

What can AFC do for you?
• Licensing
• License Management
• Frequency Coordination
• Engineering Services
Why AFC?
• Comprehensive Services
• Experienced Professionals
• Affordable Costs
• Timely Response
AFC is the leading FCC certified radio frequency coordinator with a network of more than 70 RF professionals nationwide.
Find out more at apcointl.org/afc or contact us at afc@apcointl.org.
AFC is a division of APCO international — a non-profit organization dedicated to serving those in emergency communications.
in wireless. Your efforts have created programming that is truly making a difference and leaving a legacy.
RCA is proud of these legacy contributions and thanks all of you. For more information about any of these offerings, please see the website
comments, recommendations, and suggestions on ways to further improve all our written communications.

THANK YOU
RCA’s leadership changes over time. Each year we hold elections that become effective on January 1. We welcome, and bid a fond farewell, to the following:
RCA cannot provide our programs without the support of sponsors. Thanks to all of you for stepping up!
We are proud to announce that a longtime RCA member and sponsor, Ray Novak with ICOM America, has generously offered to sponsor new student members. This is the future of RCA. This new program will support college and graduate school students as they finish their educations and enter their careers in wireless. They will have the opportunity to participate at RCA and to meet and work with all of our
We also welcome our many corporate sponsors who believe in RCA, its members, and our programs. Thanks to all of you for your generosity!
I want to thank Jane Winter and William Waugamann for their many contributions to the RCA Board. Your generosity and leadership have left a mark on all of us, and we are grateful for your efforts these past years.
John completed two years as RCA’s president on December 31, 2022. This was a stunning period to experience as he led our organization through a global pandemic and as we emerged from a virtual environment back into live activities. John initiated new programs, brought new leaders into RCA, worked closely with all of us to move things forward, and remains involved. Thank you for your dedication, commitment, perseverance, and inspiration.
RCA offers several ways to share ENews, email announcements, website content, and . As the long-time editor , I can say that it has never been better, but we do need your help, so please contribute material for future issues. We want to continue expanding our premier publication. It is up to you to develop and share new ideas and content. We welcome your

Please welcome Karen Clark, Michael Kalter, and Stan Reubenstein to the RCA Board of directors. We look forward to your participation and your leadership in 2023.

A very special thank goes to John Facella, the former president of RCA.

DON’T MISS IT!
RCA Interview: Engineering Personnel from WWV and WWVH (Details on p. 104)
Tuesday, June 13 | 9-10 p.m. ET
for all you have done for RCA!!
GET INVOLVED
Congratulations to all of RCA’s members for their continuing successes. It is truly an honor to serve as your president. I succeed a legendary group of giants who came before me who have led this wonderful organization. RCA is what you, the members, make of it. For more than a century, this has been a place to meet, share ideas, celebrate accomplishments, develop lifetime friendships, and to enjoy the art and science of wireless. I encourage all of you to bring a friend and to get more involved at RCA. The future is bright.
We look forward to seeing all of you in Denver this November.
DAVID BART, KB9YPD President





The Radio Club of America Inc.
Pre-Registration Required!
Register to receive a link, by scanning the QR code or online at radioclubofamerica.org

PROCEEDINGS • SPRING 2023 WWW.RADIOCLUBOFAMERICA.ORG 7
Former RCA president John Facella. Thank you
Departing board members Jane Winter (left) and Bill Waugeman (right). Thank you for your time, dedication, and service to RCA!
Incoming (returning) board members Karen Clark (left) and Stan Reubenstein (center) and new board member Michael Kalter (right). Thank you for joining RCA’s leadership team in 2023!!
Congratulations to 2022 RCA Banquet Participants and Award Recipients
RCA’s first live banquet and awards ceremony since the pandemic was a smashing success! It was wonderful to finally see everyone in person! We had several firsts: new awards, multiple speakers, and we finished at a reasonable time (in years past, we sometimes ran very long). Congratulations and thank you to the banquet planning committee and to Amy Beckham and the entire Sapphyre team.
This year, our donation auction returned in full force, the first we have held in many years. The results were outstanding, and RCA realized $2,500. Thank you to all our donors, and to those who purchased these items; your generous contributions help enable RCA to continue providing our programs and services.
Thank you to our presenters: David Bart, Jon Paul Beauchamp, Dr, Nathan “Chip” Cohen, John Facella, and Carole Perry. Thanks also go to Amy Beckham who led the administrative coordination.
The entire ceremony was recorded and can be viewed on RCA’s YouTube channel at https://www.youtube.com/@radioclubofamerica7981.
We invite everyone to return in 2023 for the next award banquet and Technical Symposium that will be held in Denver.

Saturday, November 19, 2022
6:00 PM EASTERN Atlanta, GA
RCA’s 113th Awards presentation was held LIVE in Atlanta, our first live gathering since the pandemic. We had a great turnout. Thank you to all who participated and thank you to a team of speakers that included:
Master of Ceremonies
Ed Ryan, Esq., RCA Vice President/Co-Counsel, Patent attorney at Tutunjian & Bitetto, P.C.


Welcoming Speaker
Dr. Chaouki T. Abdallah, Executive Vice President for Research (EVPR), professor of Electrical & Computer Engineering at the Georgia Institute of Technology
Keynote Speaker
Robert Bell, Executive Director for both the Space and Satellite Professionals International (SSPI) and the World Teleport Association (WTA)

PROCEEDINGS • SPRING 2023 WWW.RADIOCLUBOFAMERICA.ORG 8
113TH RCA AWARDS PRESENTATION
RCA’S 2022 Lifetime Achievement Award Acceptance
EDITOR’S NOTE: Dr. Akhlesh Lakhtakia received RCA’s Lifetime Achievement Award at the 113th Radio Club of America banquet and awards ceremony. Established in 2015, this award is bestowed by RCA’s Board of Directors to recognize very significant achievements and a major body of work accomplished over a lifetime that has advanced the art and science of wireless technology. Prior award recipients include Dr. Henry Richter (2019), Dr. Ulrich Rohde (2017), Dr. Joseph H. Taylor, K1JT (2016), Professor Frank Drake, Ph.D. (2015), and Dr. Martin Cooper (2010). The following text presents Dr. Lakhtakia’s acceptance speech.

Thank you very much. Since I am a professor, I am used to talking for 50 minutes. I recognize that most of you would like to do better things, so I will keep it brief.
You know, on July 20, 1969, I remember very well where I was. I was in the 7th grade, and as for the apartment building in which my family lived, there was no television. However, there was radio commentary; and every five minutes or so, the regular programming would be interrupted, and somebody would come and either in English or in Hindi, that’s a local language, they would say what was happening with the [Apollo 11] Moon mission.
That day, I turned into a black sheep for my family. You see, I was born into a family of lawyers, administrators, and housewives. I resolved to study science. There was no one in my family to guide me, and it took me about a year to realize what I wanted to become: an electronics engineer.
So, I went to school — I went to college — to study electronics engineering. My parents didn’t really quite know what to do with me. They remembered what happened, that, when they had been married — that was 20 years earlier — they had been given a radio set as a gift. It was one of those types of radio sets that you saw in today’s silent auction, perhaps a little bit bigger — a GEC, if I remember. Something had gone wrong with it. They thought: “Wow! Our son is going to become an electronics engineer! He will repair it.” Well, guess what? That didn’t happen. I spent the next three years consoling them that I am trying to figure out how to repair it. Eventually, I worked and accumulated enough money to buy them a brand-new radio set.
By then, by the time I finished my Bachelor’s degree, I had specialized in computer architecture. Now, these were very primitive computers in those days, very primitive. So, I said to myself, I don’t want to spend the rest of my life balancing ones and zeroes. Somehow, I talked to
a professor of physics, and I fell in love with Maxwell’s Equations.
Next, I went to the University of Utah for my Master’s Degree and Ph.D., and that is where I really learned Maxwell’s Equations. That’s where I learned to manipulate them. That’s where I learned to…I don’t know what to say…I still am in love with them. In fact, a few years after we got married, my wife, who is here [pointing], she said to me, “I know you love me, but you love Maxwell’s Equations more.” I think that is still true. So, I turned into a theoretical engineer; meaning that I loved the structure of Maxwell’s Equations. I solved Maxwell’s Equations analytically, and I solved them numerically. Yet, I would not go into a lab, because when I would go into a lab, something or other would stop working. And that is how it continued, for about the next 20 years. Maybe less.
I had for long been interested in electromagnetic fields in complex materials, and I wanted a special type of complex materials to be made. And, for a while, I had colleagues who were willing to do that; and then, well, two of them retired. So, I decided I will have to set up my own lab. So yes, I did set up a couple of labs where I don’t do experiments –– my students do. You see, I am still a klutz. Today, with this honor, the Radio Club of America has given klutzes like me hope.
Thank you very much.
PROCEEDINGS • SPRING 2023 WWW.RADIOCLUBOFAMERICA.ORG 9
Dr. Akhlesh Lakhtakia (center) receiving the RCA Lifetime Achievement Award from Dr. Nathan “Chip” Cohen (left) and RCA President John Facella (right).
Ž. MaterialsScienceandEngineeringC192002427–434

www.elsevier.comrlocatermsec

Sculpturedthinfilms:accomplishmentsandemerginguses
AkhleshLakhtakia)
Abstract
Ž. SculpturedthinfilmsSTFsarenano-engineeredmaterialswhosecolumnarmorphologyistailoredtoelicitdesiredopticalresponses uponexcitation.TwocanonicalformsofSTFshavebeenidentified.LinearconstitutiverelationsforgeneralSTFsasunidirectionally Ž. nonhomogeneouscontinuouslyorpiecewiseuniformlyandlocallybianisotropiccontinuumsarepresented,alongwitha4 = 4matrix ordinarydifferentialequationforwavepropagationtherein.AnominalmodelforthemacroscopicpropertiesoflinearSTFsisdevised fromnanoscopicconsiderations.TheaccomplishedimplementationofSTFsascircularpolarizationfiltersandspectralholefiltersis discussed,asalsoareemergingapplicationssuchasbioluminescencesensorsandopticalinterconnects. q 2002ElsevierScienceB.V.All rightsreserved.
Keywords: Bianisotropicmaterials;Biochips;Chiraloptics;Localhomogenization;Opticaldevices;Sculpturedthinfilms;Sensors
1.Introduction
ShortlyaftertheconceptualizationofhelicoidalbianŽ. isotropicmediumsHBMsin1993byLakhtakiaand wx Weiglhofer1,thebasisofrealizingthesematerialsusing thin-filmtechnologywasenunciatedbyLakhtakiaand wx wx Messier2.VerificationbyRobbieetal.3soonfollowed,althoughafewyearslaterIcameacrossapioneeringandessentiallycomprehensivebutobscureprecedent wx reportedbyYoungandKowalin19594.Thegeneral Ž. conceptofsculpturedthinfilmsSTFsemergednaturally, andwaspresentedinAugust1995byLakhtakiaand Messiertoagroupofthin-filmresearchersassembledat wx PennState5.Thetopichasenjoyedconsiderablegrowth intheensuingyears,chieflyintheoryinitially,butnowin wx experimentsandapplicationsaswell6.
ThenanostructureofSTFscomprisesclustersof3–5-nm diameterandarrangedtoformparallelcolumnsthatare bentinsomefancifulformswithfeaturesize30nmor larger.Accordingly,aSTFisaunidirectionallynonhomogeneouscontinuumwithdirection-dependentpropertiesat visibleandinfraredwavelengths.Amulti-sectionSTFcan thusbeconceivedofasanopticalcircuitthatcanbe integratedwithelectroniccircuitryonachip.Beingporous,
aSTFcanactasasensoroffluidsandcanbeimpregnated withliquidcrystalsforswitchingapplicationstoo.Applicationaslow-permittivitybarrierlayersinelectronicchipsas wellasforsolarcellshasalsobeensuggested.Duringthe last5years,severalphysicalvapordepositiontechniques haveemergedformanufacturingSTFs,andthefirstoptical applicationssawthelightofthedayin1999.
Ž. ThefollowingisabriefreviewofitheelectromagŽ. neticfieldequations,iianominalnanoscopic-to-conŽ. Ž.tinuummodel,iiirealizedopticalapplications,andiv emergingapplicationsofSTFs.Alargepartofthework reviewedhereisduetomycollaborators,mystudentsand me.Fortheessentialsofthefabricationtechniques,the interestedreaderisenjoinedtoreadthegemofapaper wx thatYoungandKowalwrote4.Fordetailsofthemodern versionsoftheYoung–Kowaltechnique,referenceismade wx wx toLakhtakiaandMessier7,HodgkinsonandWu8, wx wx Messieretal.9,andMalacandEgerton10.ThematerialsthatcanbedepositedasSTFsrangefrominsulatorsto semiconductorstometals,therebyindicatingtheversatility ofSTFtechnology.
2.Electromagneticfieldequations
) Tel.: q1-814-863-4319;fax: q1-814-863-7967. Ž. E-mailaddress: AXL4@psu.eduA.Lakhtakia.
Letthe z axisofacartesiancoordinatesystembe alignedparalleltothedirectionofnonhomogeneity.By
PROCEEDINGS • SPRING 2023 WWW.RADIOCLUBOFAMERICA.ORG 10
CATMAS—ComputationalandTheoreticalMaterialsSciencesGroup,DepartmentofEngineeringScienceandMechanics,PennsylÕaniaStateUniÕersity, 212Earth-EngineeringSciencesBldg.,UniÕersityPark,PA16802-6812,USA
2.1.LinearconstitutiÕeequations
0928-4931r02r$-seefrontmatter q 2002ElsevierScienceB.V.Allrightsreserved. Ž. PII:S 0928-49310100438-6 Reprint with Permission by Materials Science and Engineering.
definition,themorphologyofasimpleSTFinanyplane z s z canbemadetocoincidewiththemorphologyin 1 anotherplane z s z withthehelpofasuitablerotation.In 2 otherwords,the local morphologyisspatiallyuniform, butthe global morphologyisunidirectionallynonhomogeneous.Naturally,thisleadstotheconceptoflocalor referenceconstitutiÕeproperties oftheSTF.Theglobal constitutivepropertiesoftheSTFcanbeconnectedtothe localonesbymeansofrotationoperators.
Thefrequency–domainconstitutiverelationsofachosenSTFarethereforedefinedasfollows:
v .2 Ž.Ž.Ž.
ref
Intheserelations, e s 8.854 = 10 12 Frmand m s 4p 00 = 10 7 Hrmarethepermittivityandthepermeabilityof vacuum,respectively,whilethesuperscriptTdenotesthe Ž.Ž. transpose.Whereasthe3 = 3dyadics e v and m v ref ref representthereferencedielectricandmagneticproperties, Ž.Ž. respectively,the3 = 3dyadics a v and b v delinref ref eatethereferencemagnetoelectricproperties.Theangular Ž. frequencyisdenotedby v,andanexp i v t timedependenceisimplicit.
AnySTFforopticalandrorinfraredapplicationscomprisesidenticalcolumnsof20–100-nmdiameter.Nominally,allcolumnstwistandbendidenticallyas z changes, Ž. whichfeatureiscapturedbytherotationdyadic Sz .This 3 = 3dyadicissomecompositionofthefollowingthree elementaryrotation3 = 3dyadics:
Sz s uu q uu q uu cost z Ž.Ž.Ž. y yyxxzz
q uu uu sint z ,4 Ž.Ž.
Sz s uu q uu q uu cos z z Ž.Ž.Ž. z zzxxyy
q uu uu sin z z ,5 Ž.Ž. Ž. yxxy
Theangularfunctionsof z intheseequationsmaybe specifiedpiecewise,ifnecessary;while u , u and u are xyz thethreecartesianunitvectors.
AllcolumnsinaSTFareparalleltoeachotherinany Ž. xy plane,whichcharacteristicisincorporatedin e v , ref
Ž.Ž.Ž.Ž. m v , a v and b v .Suppose S 0 s I,the3 = 3 refref ref identitydyadic,sothattheplane z s 0isthereference plane.Let u denoteaunitvectorthatistangentialat t z s 0toanycolumn.Twootherunitvectorsaredefined fromtheshapeofthatcolumnasfollows:theunitnormal vector u suchthat u u s 0,andtheunitbinormal nn t vector u s u = u .Both u and u areconveniently b t n t n chosentolieintheplane y s 0;hence, u iseitherparallel b oranti-parallelto u .Withanangleofrise x specified, y weset u s u cos x q u sin x , u syu sin x q u cos x , t xz n xz u syu ,6Ž. b y thesethreeunitvectorsformingaright-handedcoordinate Ž x system.Typically,theangleofrise x g 08,908
Extensiveexperimentalresearchontheuniformcolumwx narthinfilms11showsthattheprescription ev s ev uu q ev uu q ev uu ,7 Ž.Ž.Ž.Ž.Ž.
a nn b tt c bb ref Ž. isappropriate.This e v isabiaxialdyadic;andthe ref Ž.Ž. simplification ev s ev isappropriateforalocally ca uniaxialSTFinthepresentcontext.Ifnecessary,agyŽ. rotropicterm e v u = I maybeappendedtotheright g g Ž. sideofEq.7,with u assomeunitvector.Theformsof g
Ž.Ž.Ž. m v , a v and b v aresimilartothoseof refref ref Ž. e v ref TwocanonicalformsofSTFscanbeidentified,as revealedbythescanningelectronmicrographsofFigs.1 Ž. and2.ForsculpturednematicthinfilmsSNTFs,either


PROCEEDINGS • SPRING 2023 WWW.RADIOCLUBOFAMERICA.ORG 11 () A.Lakhtakia r MaterialsScienceandEngineeringC192002427–434 428
Fig.1.Scanningelectronmicrographofasculpturednematicthinfilm. Ž. Courtesy:R.Messier.
T Dr , v s e Sz ev Sz Er , v Ž.Ž.Ž.Ž.Ž. 0 ref T qav Sz Hr , v ,1 Ž.Ž.Ž. Ž. ref T Br , v s m Sz bv Sz Er , v Ž.Ž.Ž.Ž.Ž. 0 ref T qmv P Sz P Hr ,
Ž.
Sz s uu q uu q uu cos j z Ž.Ž.Ž. x xxyyzz q uu uu sin j z ,3 Ž.Ž. Ž. zyyz
Ž.
zxxz
Fig.2.Scanningelectronmicrographofaperiodicthin-filmhelicoidal Ž. bianisotropicmedium,alsocalledachiralSTF.Courtesy:R.Messier.
Ž.Ž.Ž.Ž.Sz s Sz or Sz s Sz .Thecolumnarmorphology xy isessentiallytwo-dimensional,lyingineitherthe xz plane orthe yz plane.Ontheotherhand,thin-filmhelicoidal Ž. bianisotropicmediumsTFHBMsareendowedwith Ž.Ž. three-dimensionalmorphology,because Sz s Sz .Alz thoughTFHBMsneednotbeperiodicallynonhomogeneousalongthe z axis,itiseasytofabricatethemwith periodschosenanywherebetween200and2000nm.Of course,combinationsofthetwocanonicalformsaswellas cascadesofmultiplesectionsarepossible,andaddtothe attractionofSTFs.
2.2.WaÕepropagation
ElectromagneticwavepropagationinaSTFisbest handledusing4 = 4matrixesandcolumn4-vectors.At anygivenfrequency,thefollowingspatialFourierrepresentationoftheelectricandthemagneticfieldphasorsis useful:
Inthisequation, f z , k ,c , v Ž. inc
s ez , k ,c , v , ez , k ,c , v , h Ž.Ž. x inc y inc x
T = z , k ,c , v , hz , k ,c , v 10 Ž.Ž.Ž. inc y inc
w Ž.x isacolumn4-vector,and P z , k,c , v isa4 = 4 inc matrixfunctionof z thatcanbeeasilyobtainedusing symbolicmanipulationprogramssuchasMathematica.
Ž. AnalyticsolutionofEq.9canbeobtained,provided w Ž.xw Ž.x P z , k,c , v s P k,c , v isnotafunctionof z inc coninc wx Thishappens,ofcourse,forcolumnarthinfilms11,and wx thesolutionprocedureisdescribedbyHochstadt13. Ž. ExactanalyticsolutionofEq.9hasbeenobtainedalso Ž.foraxialpropagationi.e., k s 0inperiodicTFHBMs wx14;andasolutionintermsofaconvergentmatrix Ž polynomialseriesisavailableforobliquepropagationi.e., . wx k / 0inperiodicTFHBMs15.
Ž.
Ž. Ž.Ž . Er , v s e z , k ,c , v exp i k x cos c q y sin c inc inc inc 8 Ž. 5 wx Ž. Ž.Ž . Hr , v s h z , k ,c , v exp i k x cos c q y sin c inc inc inc
wx
Substitutionoftheforegoingrepresentationintothe Ž. source-freeMaxwellcurlpostulates, = = Er, v s Ž.Ž.Ž. i v Br, v and = = Hr, v syi v Dr, v ,followedby Ž.Ž. theuseoftheconstitutiverelations1and2,leadsto fourordinarydifferentialequationsandtwoalgebraic Ž. equations.Thecomponents ez , k , c , v and z inc
Ž.hz , k,c , v aretheneliminatedtoobtainthe4 = 4 z inc
wxmatrixdifferentialequation12
d f z , k ,c , v Ž. inc
dz
s i P z , k ,c , v f z , k ,c , v .9 Ž.Ž.Ž. inc inc
Moregenerally,onlyanumericalsolutionofEq.9 w Ž.x canbeobtained.Supposethat P z , k,c , v isaperiodic inc functionof z .Then,aperturbativeapproachcanbeused wx toobtainsimpleresultsforweaklyperiodicSTFs16,17, whileacoupled-modeapproachmaycomehandyifotherwxw Ž.x wise18.Butif P z , k,c , v isnotperiodic,the inc constitutivedyadicscanassumedtobepiecewisehomogeneousoverslicesofthickness D z ,andtheapproximate wxtransferequation12
inc canbesuitablymanipulatedwithappropriatelysmallvaluesof D z
Ž.Ž.
Eqs.1and2incorporatetheassumptionofaSTFasaunidirectionallynonhomogeneouscontinuum.Thisisvalidina macroscopicsense,i.e.,whenthelengthscaleofthefilmmorphologyisconsiderablysmallerthantheelectromagnetic probewavelength.Thisassumptionholdstrueinthevisibleandtheinfraredfrequencyregimes,becauseSTFswith appropriatemorphologicallengthscalescanbefabricated.
Letusconsiderasimplenanoscopic-to-macroscopichomogenizationformalismtodeterminethereferenceconstitutive Ž. wx dyadics e v ,etc.19.ThechosenSTFismadeofabianisotropicmaterial,whosebulkconstitutiverelationsare ref specifiedas:
PROCEEDINGS • SPRING 2023 WWW.RADIOCLUBOFAMERICA.ORG 12 () A.Lakhtakia r MaterialsScienceandEngineeringC192002427–434 429
f z q D z , k ,c , v Ž. inc D z , exp i P z q , k ,c , v D z inc ½5 ž/ 2 = f z , k ,c , v , 11 Ž. Ž.
3.Fromthenanoscopictothecontinuum
3.1.Nominalmodel
¶ Dr , v s eev P Er , v q av P Hr , v Ž.Ž.Ž.Ž.Ž. ss 0 •. 12 Ž. ß Br , v s mbv P Er , v q mv P Hr , v Ž.Ž.Ž.Ž.Ž. ss 0
ThevoidregionsoftheSTFaretakentobeoccupiedbyamediumwiththefollowingbulkproperties:
BothmediumsaresupposedtobepresentintheSTFasellipsoidswhichareentirelynotional.Inevery xy plane,thelongest axesofallellipsoidsofbothmediumsshouldbealignedinparallel.Theshapesofthetwotypesofellipsoidscanbe different,therespectivesurfacesbeingdefinedbythefunctions
Ž. Here, u u,f istheradialunitvectorinasphericalcoordinatesystemlocatedatthecentroidofanellipsoid;thescalars r d arelinearmeasuresoftheellipsoidalsizes;andtheshapedyadics U arerealdyadicsofrank3,withpositive s , Õ
needlewithaslightbulgeinitsmiddlepart.TheporosityoftheSTFisdenotedby f 0 F f F 1. ÕÕ
Theuseof6 = 6dyadicsprovidesnotationalsimplicityfortreatingelectromagneticfieldsinbianisotropicmaterials. Thus,wedefinethe6 = 6dyadics
The v-dependenciesofvariousquantitiesarenotexplicitlymentionedinthisandthefollowingequationsforcompactness.
ThecelebratedBruggemanformalismisnowimplementedtoeffectlocalhomogenizationwithreferencetoany xy . wx plane19.Forthispurpose,the6 = 6polarizabilitydyadics
I isthe6 = 6identitydyadic.The6 = 6depolarizationdyadics D mustbecomputedvia s , Õ two-dimensionalintegrationasfollows:


PROCEEDINGS • SPRING 2023 WWW.RADIOCLUBOFAMERICA.ORG 13 () A.Lakhtakia r MaterialsScienceandEngineeringC192002427–434 430
¶ Dr , v s eev P Er , v q av P Hr , v Ž.Ž.Ž.Ž.Ž. 0 ÕÕ •. 13 Ž. ß Br , v s mbv P Er , v q mv P Hr , v Ž.Ž.Ž.Ž.Ž. 0 ÕÕ
r u ,f s d U P u u ,f , r u ,f s d U P u u ,f . 14 Ž.Ž.Ž.Ž. Ž. ss r ÕÕ r s Õ
s , Õ Ž j . Ž. Ž 3 .Ž1 .Ž3 .Ž2 . eigenvalues0 - a F 1 j s 1,2,3.Setting a 4 a and a 4 a willmakeaparticularellipsoidalmostlikea s , Õ Ž.
Ž. 15
Ž
1 a s C C P I q i vD P C C , 16 Ž. Ž.Ž. s Õ s Õ ref s Õ s Õ ref aredefined,where
Ž. 17 Ž. Here, u s u u,f istheunitradialvector, rr † 1† 1 A u s u U e U uu U m U u Ž. ž /ž / s , Õ rr rr r s , Õ ref s , Õ s , Õ ref s , Õ † 1† 1 u U a U uu U b U u , 18 Ž. ž /ž / r rr r s , Õ ref s , Õ s , Õ ref s , Õ † 1 wx while U isthetransposeof U ,etc.TheBruggemanformalismthenconsistsofthesolutionoftheequation20,21 ss f a q 1 f a s 0 , 19 Ž. Ž. Õ s ÕÕ
with 0 asthe6 = 6nulldyadic.Thisequationhastobenumericallysolvedfor C ,andaJacobiiterationtechniqueis ref wx recommendedforthatpurpose21,22.
Ž. ThesolutionofEq.19representsthehomogenizationofobjectsofmicroscopiclineardimensionstoamacroscopic Ž. continuum.Thequantitiesentering Sz areknownpriortofabrication,asalsoare x , C and C .Inordertocalibratethe s Õ nominalmodelpresented,theshapedyadics U and U canbechosenbycomparisonofthepredicted C against s Õ ref measureddata.
3.2.ApplicationtodielectricTFHBMs
wx SherwinandLakhtakia22usedtheforegoingmodeltoextensivelystudytheplanewaveresponsesofdielectric TFHBMs,with m s I, a s 0, b s 0, e s e I,and e s I.With l denotingthewavelengthinvacuum,aLorentz s 0 s Õ s , Õ s , Õ s , Õ resonancemodelwaschosenfor e asper s
20 Ž. s 2 1 1 1 q N i ll Ž. ss 0
withconstants q , N and l selectedsothatabsorptionismoderateforvisiblewavelengths.Theellipsoidswerechosento sss Ž.beidenticali.e., U s U ,asdescribedby, s Õ 22 r ur u b t 2 2 r u qqs d , 21
n
gg 23
wherethetransverseaspectratio g ) 1andtheslendernessratio g 4 1relatethethreeprincipalaxes. 23 Fornormallyincidentplanewavesandwith
thespectrumsofopticalrotation,transmittanceellipticity,lineardichroism,circulardichroism,apparentlineardichroism, andapparentcirculardichroismwerecalculatedasfunctionsoftheconstitutiveandthegeometricparameters e , g , g , x , s 23 V, f s 1 f ,and l .Maximummagnitudesinthecomputedspectrumsweredeterminedinspecificwavelength-regimes. Õ 0 Thevariationsofthesemaximumswerethenexaminedwithrespecttoanyoneoftheconstitutiveandthegeometric parameters,whiletheotherparameterswereheldfixed.Fromthesestudies,thefollowingsignificantconclusionswere reached:
Ž.iAllobservableresponsepropertiesstronglydependonthetransverseaspectratio g ,1 F g < g .Thereexistsa 223 specificvalueof g denotedby g o suchthatallopticalactivitydisappears.Thevalueof g o canbeparameterizedinterms 22 2 ofothergeometricfactorsand es
Ž.iiAllobservablepropertymaximumsarebest-fittedtofourth-orderpolynomialsof g . 2
Ž. max iiiAllobservablepropertymaximumshavesimilardependenciesonthevolumefraction f ;furthermore, p ™ 0as
Ž max f ™ 0,1.Here, p denotesthemaximummagnitudeoftheobservableresponseproperty p overaprescribedrangeof . l0
Ž. max Ž. max Ž. ivThereexistsan f foreachvalueof g suchthat pf ) pf , f / f .Thevalueof f dependsonthevalues o2ooo ofothergeometricandconstitutiveparametersaswellasontheproperty p.Anincreasein g resultsinadecreasein f 2o wx Detailsoftheseandotherresultswillappearinprintshortly23,andtheidentifiedfunctionalrelationshipsshouldassist indesignofSTF-baseddevicesaswellastheon-linemonitoringofSTFfabricationprocesses.
4.Opticalapplications
wx Althoughmanyapplicationsarepossible5,thepotentialofSTFshasbeenmostsuccessfullyexploitedfor opticalfilters.ChiralSTFs,whichareappropriatelydescribedastheperiodicdielectricTFHBMsofSection3.2, mustdisplaythecircularBraggphenomenoninaccordance wx withtheirperiodicnonhomogeneityalongthe z axis6,24, therebyensconcingthemselvesfirmlyintheareaof chiral Ž. optics.Briefly,astructurallyright-resp.left-handed
chiralSTFonlyafewperiodsthickalmostcompletely Ž. reflectsaxiallyincident,rightresp.leftcircularlypolarizedlightwithwavelengthlyingintheso-calledBragg Ž regime;whilethereflectionofaxiallyincident,leftresp. . rightcircularlypolarizedlightinthesameregimeisvery little.ThebandwidthoftheBraggregimeandthepeak reflectivitythereinfirstincreasewiththethicknessofthe chiralSTF,andthensaturate.Oncethissaturationhas occurred,furtherthickeningofthefilmhasnegligible effectsonthereflectionspectrum.
PROCEEDINGS • SPRING 2023 WWW.RADIOCLUBOFAMERICA.ORG 14 () A.Lakhtakia r MaterialsScienceandEngineeringC192002427–434 431
q s e s 1 q ,
Ž.
ž/ž/
Ž.
p z p z Sz s Sz s uu q uu q uu cos q uu uu sin, 22 Ž.Ž. Ž.Ž. Ž. z zzxxyy yxxy Ž. z z s p z r V VV
4.1.Circularpolarizationfilters
ThecircularBraggphenomenoncanbeemployedto realizecircularpolarizationfilters.Normallyincident,circularlypolarizedlightofonehandednesscanbereflected almostcompletely,whilethatoftheotherhandednessis substantiallytransmitted,ifabsorptionissmallenoughand thefilmissufficientlythick,intheBraggregime.Thiswas wx demonstratedbyWuetal.25withchiralSTFsfabricated usingtheserialbidepositiontechnique.Asofnow,the w Braggregimecanbepositionedatvirtuallyany l g 450, 0 x 1700nm.Polarizationinsensitivitycanberealizedusinga bilayerversion,asacascadeoftwootherwiseidentical wx chiralSTFsbutofoppositestructuralhandedness26. wx Chirpingcanbeusedtowidenthebandwidth27,and tightlyinterlacedchiralSTFsmayalsoholdtechnological wx attraction28.
4.2.Polarization-discriminatoryhandedness-inÕerters
Apolarization-discriminatoryhandedness-inverterfor circularlypolarizedlightwasfabricatedusingSTFtechnology.Thiswasthefirstrealizationofatwo-sectionSTF wx device.ItcomprisesachiralSTF24andahalf-wave wx platerealizedasacolumnarthinfilm11.Basically,it almostcompletelyreflects,say,leftcircularlypolarized light;whileitsubstantiallytransmitsincidentrightcircularlypolarizedlightaftertransformingitintoleftcircularly wx polarizedlight.Theoreticalpredictions29wereborneout wx experimentally30.
4.3.Spectralholefilters
InafurtherbidtoillustratethepotentialoftheSTF concept,athree-sectionSTFwasproposedasaspectral holefilter.Itsfirstandthirdlayersareidenticalchiral wx STFs,whilethethinmiddlelayerishomogeneous31,32. Themiddlelayerissupposedtoactasaphasedefect.This designwasactuallyimplementedtoobtaina11-nmwide wx spectralholecenteredat l s 580nm33.Therealized 0 bandwidthfiltercomparesveryfavorablywiththoseof commerciallyavailableholographicfilters.
Abetterdesignbecameavailableshortlythereafterand wx wasexperimentallyevaluatedtoo34.Themiddlelayer waseliminated,butthelowerchiralSTFwastwistedby 908 withrespecttotheupperchiralSTFaboutthe z axis. Thetwistactsastherequiredphasedefect. ˘
4.4.RugateandSolcfilters
SNTFscanalsobepressedintoserviceasopticalfilters wx—forlinearlypolarizedplanewaves.McPhunetal.35 fabricatedrugatefilterswithSTFtechnologyfornarrow˘ bandreflectionapplications.Solcfiltersofthefanandthe foldedtypesarealsopossiblewiththesametechnology wx36.
4.5.Fluidsensors
TheporosityofSTFsmakesthemattractiveforfluid wx concentrationsensingapplications37,38,becausetheir opticalresponsepropertiesmustchangeinaccordance withthenumberdensityofmoleculesintrudingintothe voidregions.Inparticular,theoreticalresearchhasshown thattheBraggregimeofachiralSTFmustshiftaccordingly,therebyprovidingameasureofthefluidconcentrawx tion37.Qualitativesupportforthisfindingisprovided wx byexperimentsonwetanddrychiralSTFs39.
VeryrecenttheoreticalresearchhasindicatedthatSTF spectralholefilterscanfunctionashighlysensitivefluid concentrationsensors;andproof-of-conceptexperiments withbothcircularlypolarizedandunpolarizedincident lighthaveconfirmedthered-shiftofspectralholesupon wx exposuretomoisture40.
5.Emergingapplications
wx Fromtheirinception5,STFswereexpectedtohavea widerangeofapplications,implementableonlyaftertheir optical,electronic,andmagneticpropertiescametobetter understood.Theiropticalapplicationscametobeinvestigatedfirst,asdetailedinSection4.However,theirhigh porosity—incombinationwithopticalanisotropyandpossibletwo-dimensionalelectronconfinementinthemicrostructure—makesSTFspotentialcandidatesas:
Ž. Ž ielectroluminescentdevicesemittinglightofapre. specifiedpolarizationstatefromcirculartolinearpreparedbychemicalvapordepositionofnanocrystalsiliconintothevoidspacesofSTFsformedfromwide-gap transparentoxides;
Ž.iihighspeed,highefficiencyelectrochromicfilms;
Ž.iiiopticallytransparentconductingfilmssculptured frompuremetals;
Ž.ivmulti-stateelectronicswitchesbasedonfilamentary conduction;
Ž.vopticalsensorsthatcandetectandquantifyvarious chemicalandbiologicalfluids;and
Ž.vimicro-sievesfortheentrapmentofvirusesorfor growingbiologicaltissuesonsurfacesofbiologicalor nonbiologicalprovenances.
Obviously,manyotherapplicationsmayturnouttobe possible,butsignificantprogressthusfarhasbeenreported,tomyknowledge,onlyinthefiveareasdiscussed below.
5.1.Biochips
Endowedwithporosityofengineeredtexture,STFscan functionasmicroreactorsandthereforecanfunctionas biochips.Asanexample,letusconsiderthefollowing
PROCEEDINGS • SPRING 2023 WWW.RADIOCLUBOFAMERICA.ORG 15 () A.Lakhtakia r MaterialsScienceandEngineeringC192002427–434 432
scenario:Intercalationofarutheniumcomplexwithdouble-strandedDNAisknowntogenerateluminescence. Supposethatidenticalsingle-strandedDNAmolecules— withaparticulargenomicsequencematchedto,say, E. coli —aredispersedinaSTF.Adropofcontaminated watercontaininganalyteDNAmoleculesfromexploded E.coli isputontheSTF,followedbyadropofan appropriaterutheniumcomplex.ThebioluminescencesignalemergingfromtheSTFcanbeopticallysensedby photoncountersinordertomeasurethedegreeofcontamination.
Bioluminescentemissionisboundtobeaffectedbythe reactorcharacteristics.IfthereactorisachiralSTF,the possibilityofexploitingthecircularBraggphenomenon exhibitedbyitwouldbeattractive.Indeed,thestructural handednessaswellastheperiodicityofchiralSTFshave beenshowntocriticallycontroltheemissionspectrumand intensity,whilethepolarizationstateoftheemittedlightis stronglycorrelatedwiththestructuralhandednessofthe wx embeddedsourcefilaments41.BioluminescenceSTF sensorsthereforemeritcloserattention.
5.2.Opticalinterconnects
Efficientuseofoptoelectronicdevicesrequiresthedevelopmentofopticalinterconnectswhich,inadditionto providingeffectivesignaltransmission,mustbesimpleto fabricateonintegratedcircuitry.STFtechnologyiscompatiblewiththeplanartechnologyofelectronicchips. GuidedwavepropagationinchiralSTFsturnsouttoyield thespace-guideconcept:thecapacitytosimultaneously supportpropagationmodeswithdifferentphasevelocities wx indifferentdirections42,43.Thiscouldresultinefficient useoftheavailable realestate inelectronicchips.Furthermore,thehelicoidalmicrostructureofchiralSTFswould resistverticalcleavageandfracture,incontrasttocolumnarthinfilmswhichcanalsofunctionasspace-guides.
ChiralSTFscanbegrownasaregularlatticeby wx lithographicallypatterningthesubstrates10.Whereas slowsubstrate-rotationratesresultinthegrowthofarrays ofmicrohelixesormicrospringsspacedascloseas20nm fromtheirnearestneighbors,fasterrotationratesyield wx arraysofincreasinglydenserpillars9,10.SuchSTFsare essentiallyphotonicbandgapmaterialsinthevisibleand theinfraredregimes.Mostrecently,evenlinedefectshave wx beenintroducedtherein44.
5.3.Interlayerdielectrics
Withthemicroelectronicsindustrymovingrelentlessly towardsdecreasingfeaturesizesandincreasinglystringent tolerancelevels,anurgentneedexistsfortheuseof low-permittivitymaterialsasinterleveldielectrics.Silicon dioxide,thecurrentmaterialofchoice,hasexcellentpropertiesinallrespectsexceptone:itspermittivityistoohigh. TheporosityofSTFsandnanoporoussilicamakesthem
attractivelow-permittivitymaterialsformicroelectronic andelectronicpackagingapplications.However,chiral STFsarelikelytohavesignificantthermal,mechanical,as wellaselectricaladvantagesovernanoporoussilica—beŽ. Ž.causeofiporositywithcontrollabletextureandii helicoidalmorphology.Also,chiralSTFscouldbeimpregwx natedwithvariouskindsofpolymers45.
5.4.Electricallyaddressabledisplays
Ž. LiquidcrystalsLCscanbeelectronicallyaddressed wx46andarethereforewidelyusedthesedaysfordisplays. AlthoughSTFsarenotelectronicallyaddressable,the alignmentofnematicLCsforcedintothevoidregionsof chiralSTFshasbeenshowntorespondtoappliedvoltages wx47.Thus,STF–LCcompositesmayhaveafutureas robustdisplays.
5.5.Opticalpulse-shapers
Thecurrentexplosivegrowthofdigitalopticscommunicationhasprovidedimpetusfortime-domainresearchon novelmaterials.AschiralSTFsareveryattractivefor opticalapplications,thecircularBraggphenomenonis beingstudiedinthetimedomain.Apulsebleedingphenomenonhasbeenidentifiedastheunderlyingmechanism, whichcandrasticallyaffecttheshapes,amplitudesand wx 1 spectralcomponentsoffemtosecondpulses48.However,narrow-bandrectangularpulsescanpassthrough wx withoutsignificantlossofinformation49.Applicationof STFstoshapeopticalpulsesappearstobewaitinginthe wings.
6.Concludingremarks
Theforegoingsectionmakesitevidentthatsculptured wx thinfilmsarecomparabletoliquidcrystals45,50,51in manyrespects.Theirrespectiverolescanbecompetitiveas wellascomplementary,dependingonthespecificenvironmentandapplication.Forinstance,beingsoftandviscous, LCsserveaspressurertemperaturesensors.ButSTFsare poroussolidsandlikelytobeunaffectedbysmallchanges intheambientpressureandtemperature.However,those qualitiesarelikelytobeusefulincertainenvironments wheremechanicalintegrityandthermalstabilityareata premium.Furthermore,STFscanserveasfluidsensors andmicroreactors,butLCscannot.Liquidcrystalsare widelyusedforelectronicdisplaysastheyareelectrically addressable;STF–LCcompositescanalsobeelectrically addressed.BothLCsandSTFscanbeusedasoptical filtersandpolarizers,butonlythelattertrulymakethe
PROCEEDINGS • SPRING 2023 WWW.RADIOCLUBOFAMERICA.ORG 16 () A.Lakhtakia r MaterialsScienceandEngineeringC192002427–434 433
1
Ž.Ž.Ž.
Replace1inthelasttermsofEqs.19,21and22ofthispaper
Ž. by d t
conceptofoptics-in-a-chippossible.Finally,thewidescope ofSTFs—accessiblethroughtailorablemicrostructureand anisotropy,aswellasviathealmostunlimitedtypesof depositablematerials—isremarkable.
Toconclude,thedevelopmentofSTFtechnologyis nowinapost-embryonicstage.Muchneedstobedoneto makeitrobust,economicalandwidelyused.Butthefuture wxappearsbright,andtherecentfeatofSuzukiandTaga52 infabricatingSTFswithmanysectionsunderscoresthe tremendouspromiseofSTFsasintegratedopticalchips wx5,12.
Acknowledgements
IamindebtedtoallofmycollaboratorsandmystudentsforsplendidsupportonSTFresearchoverthelast decade.ThisreviewisdedicatedtotheinspirationalbattingperformancesofV.V.S.LaxmanandRahulS.Dravid andthesuperbbowlingperformanceofHarbhajanSingh duringacricketTestmatchbetweenIndiaandAustralia, playedMarch11–15,2001atEdenGardens,Kolkata.
References
wx1A.Lakhtakia,W.S.Weiglhofer,MicrowaveOpt.Technol.Lett.6 Ž.1993804.
wx Ž. 2A.Lakhtakia,R.Messier,in:F.Mariotte,J.-P.ParneixEds., Ž. ProceedingsofChiral’94Perigueux,France,May18–20,French ´ AtomicEnergyCommission,LeBarp,France,1994,pp.125–130.
wx3K.Robbie,M.J.Brett,A.Lakhtakia,J.Vac.Sci.Technol.,A13 Ž.19952991.
wx Ž. 4N.O.Young,J.Kowal,Nature1831959104.
wx5A.Lakhtakia,R.Messier,M.J.Brett,K.Robbie,InnovationsMater. Ž. Res.11996165.
wx Ž. 6V.C.Venugopal,A.Lakhtakia,in:O.N.Singh,A.LakhtakiaEds., ElectromagneticFieldsinUnconventionalMaterialsandStructures, Wiley,NewYork,2000,pp.151–216.
wx Ž. 7A.Lakhtakia,R.F.MessierEds.,EngineeredNanostructuralFilms andMaterials.SPIE,Bellingham,WA,USA,1999.
wx Ž. 8I.Hodgkinson,Q.H.Wu,Appl.Opt.3819993621.
wx9R.Messier,V.C.Venugopal,P.D.Sunal,J.Vac.Sci.Technol.,A18 Ž.20001538.
wx Ž. 10M.Malac,R.F.Egerton,Nanotechnology12200111.
wx11I.J.Hodgkinson,Q.-h.Wu,BirefringentThinFilmsandPolarizing Elements,WorldScientific,Singapore,1997.
wx Ž. 12A.Lakhtakia,Optik107199757.
wx13H.Hochstadt,DifferentialEquations—AModernApproach,Dover Press,NewYork,1975,Chap.2.
wx14A.Lakhtakia,W.S.Weiglhofer,Proc.R.Soc.London,Ser.A448 Ž. Ž. 1995419,Erratum:45419983275.
wx15A.Lakhtakia,W.S.Weiglhofer,Proc.R.Soc.London,Ser.A453 Ž. Ž. 199793,Erratum:45419983275.
wx16V.A.Yakubovich,V.M.Starzhinskii,LinearDifferentialEquations withPeriodicCoefficients,Wiley,NewYork,1975.
wx Ž. 17W.S.Weiglhofer,A.Lakhtakia,Optik1021996111.
wx Ž. 18K.Rokushima,J.Yamakita,J.Opt.Soc.Am.A4198727.
wx19A.Lakhtakia,P.D.Sunal,V.C.Venugopal,E.Ertekin,Proc.SPIE Ž. 3790199977.
wx20W.S.Weiglhofer,A.Lakhtakia,B.Michel,MicrowaveOpt.TechŽ. Ž. nol.Lett.151997263,Erratum:221999221.
wx Ž. 21B.Michel,in:O.N.Singh,A.LakhtakiaEds.,Electromagnetic FieldsinUnconventionalMaterialsandStructures,Wiley,New York,2000,pp.39–82.
wx Ž. 22J.A.Sherwin,A.Lakhtakia,Proc.SPIE40972000250.
wx Ž.Ž 23J.A.Sherwin,A.Lakhtakia,Math.Comput.Model.2001in . press.
wx24I.Hodgkinson,Q.h.Wu,B.Knight,A.Lakhtakia,K.Robbie,Appl. Ž. Opt.392000642.
wx Ž. 25Q.Wu,I.J.Hodgkinson,A.Lakhtakia,Opt.Eng.3920001863.
wx26A.Lakhtakia,V.C.Venugopal,MicrowaveOpt.Technol.Lett.17 Ž.1998135.
wx Ž. 27A.Lakhtakia,MicrowaveOpt.Technol.Lett.282001323.
wx Ž. 28A.Lakhtakia,Optik1122001119.
wx Ž. 29A.Lakhtakia,Opt.Eng.3819991596.
wx Ž. 30I.J.Hodgkinson,A.Lakhtakia,Q.h.Wu,Opt.Eng.3920002831.
wx Ž. 31A.Lakhtakia,M.McCall,Opt.Commun.1681999457.
wx32A.Lakhtakia,V.C.Venugopal,M.W.McCall,Opt.Commun.177 Ž.199957.
wx33I.J.Hodgkinson,Q.h.Wu,A.Lakhtakia,M.W.McCall,Opt.ComŽ. mun.177200079.
wx34I.J.Hodgkinson,Q.H.Wu,K.E.Thorn,A.Lakhtakia,M.W.McŽ. Call,Opt.Commun.184200057.
wx Ž.35A.H.McPhun,Q.H.Wu,I.J.Hodgkinson,Electron.Lett.341998 360.
wx Ž. 36A.Lakhtakia,Opt.Eng.3719981870.
wx Ž. 37A.Lakhtakia,Sens.Actuators,B521998243.
wx Ž. 38E.Ertekin,A.Lakhtakia,Eur.Phys.J.:Appl.Phys.5199945.
wx Ž.39I.J.Hodgkinson,Q.h.Wu,K.M.McGrath,Proc.SPIE37901999 184.
wx40A.Lakhtakia,M.W.McCall,J.A.Sherwin,Q.h.Wu,I.J.HodgkinŽ. son,Opt.Commun.194200133–46.
wx Ž. 41A.Lakhtakia,Opt.Commun.1882001313.
wx Ž. 42A.Lakhtakia,Optik1101999289.
wx Ž.43E.Ertekin,A.Lakhtakia,Proc.R.Soc.London,Ser.A4572001 817.
wx Ž. 44M.Malac,R.F.Egerton,J.Vac.Sci.Technol.,A192000158.
wx45V.C.Venugopal,A.Lakhtakia,R.Messier,J.-P.Kucera,J.Vac.Sci. Ž. Technol.,B18200032.
wx Ž. 46S.D.JacobsEd.,SelectedPapersonLiquidCrystalsforOptics, SPIE,Bellingham,WA,USA,1992.
wx Ž. 47J.C.Sit,D.J.Broer,M.J.Brett,Liq.Cryst.272000387.
wx Ž. 48J.B.GeddesIII,A.Lakhtakia,Eur.Phys.J.Appl.Phys.1320013.
wx49J.B.GeddesIII,A.Lakhtakia,MicrowaveOpt.Technol.Lett.28 Ž.200159.
wx50S.Chandrasekhar,LiquidCrystals,CambridgeUniv.Press,Cambridge,UK,1992.
wx51P.G.deGennes,J.Prost,ThePhysicsofLiquidCrystals,Clarendon Press,Oxford,UK,1993.
wx Ž.Ž. 52M.Suzuki,Y.Taga,Jpn.J.Appl.Phys.40Part22001L358.
PROCEEDINGS • SPRING 2023 WWW.RADIOCLUBOFAMERICA.ORG 17 () A.Lakhtakia r MaterialsScienceandEngineeringC192002427–434 434



PROCEEDINGS • SPRING 2023 WWW.RADIOCLUBOFAMERICA.ORG 18 www.osa-opn.org 32 | OPN January 2007 1047-6938/07/01/0032/6-$15.00 ©OSA
Meet the
Akhlesh Lakhtakia and Tom G. Mackay
Above: Opal detail. Below: The eye of the “silver-spotted skipper” butterfly (Epargyreus clarus), which has negativerefractive-index geometrical optics.
D.G. Stavenga, University of Groningen, The Netherlands
Reprint with Permission by Optics & Photonics News.
Bill Bachman, Getty Images
Among optics and electromagnetics researchers today, the term “metamaterials” is often taken to be synonymous with materials that have a negative refractive index, but there is much more to metamaterials than that. As research evolves, these unique composite materials will be fabricated with new, multifunctional architectures that will enable applications in sensing, security, transportation and other areas.
Metamaterials the






PROCEEDINGS • SPRING 2023 WWW.RADIOCLUBOFAMERICA.ORG 19 OPN January 2007 | 33
Metamaterials have captured the imagination of a generation of researchers. They will be conceived from deep understandings of physical, chemical and biological phenomenons at submicron length scales, designed with adaptive algorithms implemented on powerful but tiny computers, and fabricated with automated technologies with nanoscale precision. These materials, which are still in their infancy, shall one day perform robustly and reliably to satisfy a multitude of requirements in complex environments––even inside human beings and other animals, and perhaps far away from the third planet orbiting our Sun.
In the year 2000, Rodger M. Walser of the University of Texas at Austin coined the name metamaterials for artificial materials fabricated by first downscaling macroscopic material architectures to submicron and nanometer length scales and then combining different downscaled architectures into macroscopic composite materials that would not only exceed their conventional counterparts in performance but perhaps also satisfy complex multifunctional requirements.

Shortly thereafter, Walser formally defined metamaterials as “macroscopic composites having a manmade, three-dimensional, periodic cellular architecture designed to produce an optimized combination, not available in nature, of two or more responses [emphasis in the original] to specific excitation.”

But early definitions are evolutionary––ask any solar-system astronomer! We can relax the requirements of periodicity today, though not of cellularity. Furthermore, we must not exclude naturally occurring metamaterials. Living objects are far more complex than manufactured ones; in 2006, the eyes of certain
lepidopterans and lobsters were found to contain metamaterials. In addition, natural analogs of artificial structures such as photonic crystals are frequently reported; opals are a good example. The issue of multifunctionality is likely to divide researchers into two camps, as is exemplified by varying answers to the following question: Should permittivity and the inverse of the permeability be considered as entirely separate performance parameters, even though they are really part of a single constitutive tensor or dyadic that relates the primitive electromagnetic field (comprising the conventional E and B) to the induction electromagnetic field (comprising D and H)?
A working definition of a metamaterial is as follows: It is a composite material exhibiting response characteristics that either are not observed in, or are enhanced relative to, the individual responses of its constituent materials, each of which is chemically inert with respect to the others in its immediate proximity. The latter restriction excludes molecularly pure materials containing two or more types of atoms from being classified as metamaterials. Multifunctionality is considered simply a desirable attribute of metamaterials for now, but will be required within a decade for a tighter definition.
Early examples
As the working definition suggests, metamaterials were fabricated before the term was. An example dating back to the 1890s is that of isotropic chiral materials made by dispersing electrically small spirals in a host medium. These composite materials would alter both the orientation and the eccentricity of the vibration ellipse of an electromagnetic plane wave in
www.osa-opn.org

PROCEEDINGS • SPRING 2023 WWW.RADIOCLUBOFAMERICA.ORG 20
34 | OPN January 2007 [ ]
[ Sample of an isotropic chiral material ]
A scanning electron microscope image of a sculptured thin film
This material was fabricated for microwave applications by dispersing miniature springs in epoxy.
This chiral sculptured thin film was made by evaporating silicon oxide in an evacuated chamber containing a rotating substrate.
Álvaro Gómez, Universidad de Cantabria, Spain
Mark W. Horn, Pennsylvania State University
some spectral regime, although the constituent materials by themselves cannot.

Isotropic chiral materials exhibiting that response in the optical regime are commonplace in nature; their molecules are not coincident with their mirror images. But composite materials demonstrating that effect in the microwave regime must be artificially made—e.g., by dispersing tiny metallic springs in epoxy. The shapes of the spirals engender the alteration of the vibration ellipse. Electromagnetic research on isotropic chiral materials intensified during the late 1980s and early 1990s, and may now be back in vogue in the context of negative refraction.
Sculptured thin films provide another example. These composite materials are assemblies of shaped parallel nanowires made of clusters less than 5 nm in size. The nanowire shapes impart response characteristics to this type of metamaterial that are not evinced by the bulk material that was evaporated to make it.
For instance, chiral sculptured thin films are useful as circular-polarization filters because they display the circular Bragg phenomenon arising from the helical shape of their nanowires, which also contributes to a reduction of residual stress in comparison with columnar thin films that are assemblies of parallel straight nanowires.
Magnetoelectric composite materials provide yet another example. These materials exist in nature as crystals. They develop a magnetization in response to the application of an electric field, and a polarization in response to a magnetic field. Magnetoelectric composite materials in the form of multilayers with alternate piezoelectric layers (such as barium titanate) and magnetostrictive layers (such as terfenol-D) were proposed and experimentally investigated by Girish Harshe, formerly at Pennsylvania State University.
These composite materials exploit the interaction of the electric/magnetic field with the strain tensor in two different classes of materials to deliver magnetoelectric coefficients that are much higher than in their natural counterparts. Of course, neither piezoelectric nor magnetostrictive materials are magnetoelectric.
Homogenized composite materials

Metamaterials are composite materials. Provided that their constituent materials are evenly dispersed as electrically small inclusions or particles––much like a batter of both yellow and chocolate cake mixes––composite materials can be homogenized.
Researchers have been predicting the effective constitutive properties of a homogenized composite material (HCM) for the past two centuries. The homogeneity of HCMs is a consequence of the electromagnetic wavelengths being much larger than the inclusion dimensions. Similarly, a sample of quartz appears homogeneous to the naked eye, but its crystal structure is revealed under X-ray illumination.
Although homogenizability should not be construed as a defining attribute of metamaterials, HCM-metamaterials present interesting technoscientific opportunities. Here are several recent electromagnetic examples:
c Bianisotropy. The most general linear electromagnetic material is called bianisotropic—which refers to the anisotropic coupling of D and H to E and B. The huge parameter space associated with bianisotropic materials implies an exceedingly rich palette of electromagnetic responses. Bianisotropic HCMs may be readily conceptualized as arising from commonplace constituent materials.
One of the constituent materials has to be anisotropic whereas the other is isotropic but exhibits magnetoelectric coupling. For example, the homogenization of a biaxial dielectric material with an isotropic chiral material results in a biaxial bianisotropic HCM. Bianisotropic materials are best used for single-step tailoring of both the polarization state and the bandwidth.
c Voigt-wave propagation. Planewave propagation in biaxial dielectric materials is generally birefringent––i.e., two different wave vectors are associated with propagation in a given direction in a biaxial dielectric material. In exceptional cases, the two plane waves coalesce to form a single plane wave called the Voigt wave, named in honor of Woldemar Voigt, who reported his experimental observations more than 100 years ago. Any Voigt wave exhibits an unusual property: Its amplitude is linearly dependent upon propagation distance.
PROCEEDINGS • SPRING 2023 WWW.RADIOCLUBOFAMERICA.ORG 21 OPN January 2007 | 35
In 2006, the eyes of certain lepidopterans and lobsters were found to contain metamaterials. In addition, natural analogs of artificial structures such as photonic crystals are frequently reported; opals are a good example.
Iolite and amethyst are two naturally occurring crystals that allow Voigt-wave propagation.
Voigt-wave propagation cannot occur in isotropic or uniaxial dielectric materials. A composite material comprising two uniaxial dielectric constituent materials may yield a biaxial HCM, provided that the distinguished axes of the uniaxial constituent materials are not aligned with each other. In so doing, biaxial dielectric HCMs that support the propagation of Voigt waves can be conceptualized, even though their uniaxial constituent materials do not support such propagation.
The void regions of a porous dielectric composite material may be engineered to allow Voigt waves to propagate ordinarily but not when the material is immersed in a certain fluid. Thus, researchers can exploit the phenomenon for optically sensing for the presence and density of an infiltrating fluid.
c Negative phase velocity. The familiar description of plane wave propagation, as presented in many standard electromagnetism textbooks, is that of positive phase velocity (PPV). That is, the phase velocity casts a positive projection onto the direction of the rate of energy flow as quantitated by the time-averaged Poynting vector. On the other hand, the phenomenon of negative phase velocity (NPV)––wherein the direction of the phase velocity is opposed to the direction of the rate of energy flow––has generated much excitement over the past five years.
Of the several unusual phenomenons that follow as a consequence of NPV, the most notable is negative refraction. Prospective technological applications of NPV propagation, such as near-perfect lenses, continue to motivate research


Early experimental research on microwave negative refraction was done with metamaterials comprising cells containing metallic wires and rings embossed periodically on plastic sheets. There is now hope for simpler NPV metamaterials—e.g., random assemblies of spherical inclusions of two different isotropic homogeneous, dielectric-magnetic materials, with relative permittivities ea and eb and relative permeabilities ma and mb , respectively.
Provided that the values of ea,b and ma,b lie within certain ranges, with the real parts of ea,b < 0 and the real parts of > 0 (or vice versa), the bulk constituent materials cannot support NPV propagation, whereas the HCM may. Whether NPV propagation is supported by the HCM depends upon the relative proportions of the constituents, as well as the size and distribution of the inclusions.
The scope for realizing NPV propagation in HCMs may be extended by using constituent materials that are more complex than isotropic dielectric-magnetic materials. For example, numerous studies have revealed that a bianisotropic HCM, in the form of a Faraday chiral material, may support NPV propagation, whereas its constituent materials do not. A Faraday chiral material can develop from the homogenization of an isotropic chiral material with a magnetically biased ferrite.
c Enhancement of group velocity. Group velocity—the velocity of the peak of a pulse—is meaningful only when the pulse is not seriously distorted while traversing a medium. Suppose we consider a composite material made of 1) a constituent material with relatively high relative permittivity ea and low frequency-dispersion dea/dw and 2) a constituent material with relatively low eb and high deb/dw, in a spectral regime of interest.
Both constituent materials are randomly distributed as electrically small spherical inclusions, so that the HCM is also an isotropic dielectric material. The group velocity in the HCM can exceed in magnitude the group velocity in either constituent material for certain relative proportions of the constituent materials. Group-velocity-enhancing metamaterials
PROCEEDINGS • SPRING 2023 WWW.RADIOCLUBOFAMERICA.ORG 22 www.osa-opn.org 36 | OPN January 2007
[ Positive/negative phase velocity ]
Positive refraction Negative refraction Incidence Positive refraction <Poynting vector> Phase velocity Reflection PPV medium Incidence Negative refraction <Poynting vector> Phase velocity Reflection NPV medium
Illustration of positive/negative phase velocity and positive/negative refraction due to an isotropic dielectric-magnetic material.
may be useful for reducing information delay in solid-optics components, possibly in optoelectronic chips.
The group-velocity enhancement brought about by homogenization also arises in anisotropic HCMs. For example, if the constituent materials are dispersed as oriented spheroids, in certain directions the group velocities associated with both the ordinary and extraordinary wave vectors in the corresponding anisotropic dielectric HCM can exceed in magnitude the group velocity in either constituent material. The degree of group-velocity enhancement is sensitively dependent upon the eccentricity and orientation of the inclusions.

c Nonlinearity enhancement. Finally, let us turn to nonlinear materials. Metamaterials with enhanced nonlinearity would be useful for more efficient harmonic generation, amplification, etc. In a similar manner to that described for group-velocity enhancement, HCMs may be conceptualized to exhibit nonlinear responses that are enhanced compared to those of their constituent materials.
This has been demonstrated for a wide range of cubically nonlinear HCMs, including isotropic and anisotropic dielectric HCMs, as well as isotropic chiral HCMs. The achievable

The HCM comprises electrically small spherical inclusions of 1) an isotropic dielectric-magnetic material a with ea = –5.9 + 0.8i and ma = 1.5 + 0.2i, and 2) an isotropic dielectric-magnetic material b with eb = –1.5 + i and mb = 2 + 1.1i. The phase–velocity parameter ρ indicates whether the phase velocity is positive or negative. In other words, negative (positive) phase velocity is signified by ρ < 0 (ρ > 0). The phase-velocity parameter ρHCM is plotted against the volume fraction of material a (solid line), along with ρa,b (dashed lines). The NPV regime is shaded.

The HCM comprises spherical inclusions of 1) an isotropic dielectric material a with relative permittivity ea = 32 and dea/dw|w Ω = 5/Ω and 2) an isotropic dielectric material b with eb = 1.25 and deb/dw|w=Ω = 13/Ω. The magnitude of the HCM’s group velocity vg HCM (solid line) and the magnitudes of the constituent materials’ group velocities vg a,b (dashed lines) are plotted as functions of the volume fraction of material a. All speeds are normalized with respect to the speed of light in free space. The regime of group-velocity enhancement is shaded.

PROCEEDINGS • SPRING 2023 WWW.RADIOCLUBOFAMERICA.ORG 23 OPN January 2007 | 37
Direction of phase velocity relative to time-averaged Poynting vector in an HCM
Early experimental research on microwave negative refraction was done with metamaterials comprising cells containing metallic wires and rings embossed periodically on plastic sheets. There is now hope for simpler NPV metamaterials.
[ ]
Enhancement of group velocity in an HCM
[ ]
Volume fraction of material a
Volume fraction of material a
degree of nonlinearity enhancement is sensitive to the shape and distribution of the constituent inclusions in addition to the relative proportions of the constituent materials.
Nonhomogeneous metamaterials
Nonhomogeneous metamaterials, whose constitutive properties are designed to vary with position, are functionally graded materials. Nonhomogeneous metamaterials with complex microstructures have lately become a reality due to breakthroughs in manufacturing techniques. Indeed, a U.S. research group has now demonstrated graded negatively refracting lenses for microwave focusing. Also, the nonhomogeneity of metamaterials presents opportunities for cloaking––that is, through judicious spatial variation in its constitutive properties, a metamaterial shroud may be used to conceal, at least partially, an object. At least four cloaking schemes have been reported from the United States and the United Kingdom. Most recently, a combined U.S.-U.K. research effectively cloaked a quasi-two-dimensional metallic object from a continuous-wave source radiating at 8.5 GHz. However, the accomplishment of the same feat for optical sources or ultrawideband sources remains a daunting challenge for technoscientists.
Multifunctionality
The HCMs presented earlier show responses that are either not exhibited at all by their constituent materials or not exhibited to the same degree by any of their constituents. The technoscientific opportunities offered by such HCM-metamaterials are indeed tremendous in optics and electromagnetics, but any multifunctionality that they exhibited would be either incidental or anemic.
Robust multifunctionality lies at the heart of intelligent materials design. Materials have many different types of responses: electromagnetic, elastodynamic, thermal, piezoelectric, pyroelectric, magnetoelastic and so on. Design for just one type of response cannot generally satisfy the multitude of requirements for efficient and durable functioning in complex systems and environments.
Nanotechnological approaches appear promising for the fabrication of multifunctional metamaterials, because different types of nanoparticles could be intimately mixed to yield materials with desirable macroscopic responses to different types of excitations. Very likely, more than one approach could deliver the desired responses, as can be gleaned from the following rather simple argument modeled after the celebrated Maxwell Garnett formula for homogenizing particulate composite materials.
Let us consider only linear HCM metamaterials. Typically, the formulation of macroscopic responses requires a set of primitive fields, a set of induction fields and a set of constitutive linkage parameters. Let pk (k = 1,2,…) denote the primitive fields. These fields can be tensors of arbitrary order; for instance, p1 can be the electric field (which is a first-order tensor), and p2 can be the strain (which is a second-order tensor).
Similarly, let q k (k = 1,2,…) denote the induction fields. Then, q1 can be the electric displacement, and q 2 can be the stress, for example. Forming the poly vectors P = {p1, p2, p3,…} and Q = {q 1, q 2, q 3,…}, we can set up the linear constitutive relation Q = M P, where the constitutive object M encodes linkages between every pair {q j, p k} of the form q j = m jk • p k, with • denoting an appropriate multiplication.

a
The HCM comprises spherical inclusions of 1) a cubically nonlinear isotropic dielectric material a with relative permittivity ea = 2 and nonlinear susceptibility ca = 9.07571 x 10–12 m2 V–2 and 2) a linear isotropic dielectric material b with eb = 8. The HCM is a cubically nonlinear material with nonlinear susceptibility cHCM. The nonlinearity parameter c0 HCM = cHCM/ca is plotted as a function of the volume fraction of material a (solid line). Also shown are the nonlinearity parameters c0 a = 1 and c0 b = 0 (dashed lines). The regime of nonlinearity enhancement is shaded.
Let an electrically small inclusion be embedded in a dissimilar host medium, with their respective constitutive objects denoted by M inc and M host, respectively. The response function of this inclusion is not a straightforward calculation and may not be known except in special circumstances. Suppose, however, that both materials are poly-isotropic, the inclusion is spherical, and the boundary conditions at the bimaterial interface are particularly beneficent.
Poly-isotropy implies that every constitutive linkage m jk is actually a scalar (i.e., m jk = m jk d jk, where d jk is the appropriate idempotent). Then the response function of the embedded inclusion may be captured reasonably well––at least, for this argument––via the poly-polarizability density
A = (M inc – M host)•[(I + N •(M inc – M host)]†, where † denotes
PROCEEDINGS • SPRING 2023 WWW.RADIOCLUBOFAMERICA.ORG 24 www.osa-opn.org 38 | OPN January 2007
[ ] Volume fraction of material
0 0.2 0.4 0.6 0.8 1 Nonlinearity parameter 1.4 1.2 1 0.8 0.6 0.4 0.2 0 Nonlinearity parameter of an HCM
the reciprocation operation, N is some appropriate constant depending on M host as well as the shape of the inclusion, and I is the idempotent.
The effective constitutive object of a composite material wherein the volume fraction finc of the inclusion material is sufficiently small may be estimated as M HCM = M host + f inc A • (I – f inc N •A )†. It must thus contain terms dependent on A . A significant attribute of A is that it can give rise to indirect connections between a particular pair of induction and primitive fields––say, q 3 and p 6––in the HCM, even though the constitutive linkage m36 is null-valued in the constituent materials. Many such connections may exist between q 3 and p 6, and each connection may perambulate through more than one constitutive linkages other than m36
Furthermore, a particular constitutive linkage may be involved in more than one perambulation, which suggests the possibility of more than one route towards a desired multifunctionality. The goal of multifunctionality would lead to overlap among currently distinct research disciplines, thereby promoting interdisciplinarity in research institutions and multidisciplinarity in research careers.
Charles Bakis (Pennsylvania State University) recently suggested to us a splendid example of multifunctionality: the skin of the Boeing 787 Dreamliner. This skin is made of a composite material. Low weight for fuel efficiency, high stiffness for resistance to deformation, and high strength for resistance to rupture are age-old requirements for any airborne mechanical structure.
In addition, the 787’s skin was designed to dampen sound in order to isolate acoustically the cabin from the wing-mounted engines and thus reduce noise in the cabin. The skin was also designed for thermal isolation from low external temperatures during flights in order to prevent internal condensation on it, which, in turn, allows higher humidity in the cabin and greater comfort for the passengers.
The multifunctionality of airplane skins will be further enhanced in the future when 1) a network of embedded optical fibers will allow simultaneous monitoring of the skin’s mechanical integrity and external environmental variables, 2) embedded antennas would enable numerous channels of communications with aircraft traffic controllers and Internet service providers, and 3) a network of embedded actuators to morph the shape of the airplane to reduce drag and further increase fuel efficiency and reduce vibrations.
Outlook
The future is bright for metamaterials science and technology. The emergence of metamaterials coincided with the rapid gain in popularity of nanotechnology as a research discipline with financial backing from governments and industries. Metamaterials with new types of architectures will be
fabricated by molecular self-assembly, layer-by-layer deposition, nanoimprinting and other nanotechnological methods. Such metamaterials will be multi-functional and their fabrication will enable new sensors and actuators for monitoring the health and controlling the performance of complex structures operating in extreme or delicate environments, including biological and extraterrestrial. Who could ask for anything more?
[ Akhlesh
[ References and Resources ]
>> Boeing Company, 787 Family: www.boeing.com/commercial/ 787family/
>> A. Lakhtakia, presentation on twisted material gains: www.ima.umn. edu/2006-2007/SW10.2-4.06/activities/Lakhtakia-Akhlesh/Lakhtakia_06_14.pdf
>> A. Lakhtakia and R. Messier. Opt. Photon. News 12(9), 26-31 (2001).
>> T.G. Mackay. Electromagnetics 25, 461-81 (2005).
>> D. Munshi et al. Futures (2007): http://dx.doi.org/10.1016/ j.futures.2006.08.003.
>> National Research Council. Condensed-Matter and Materials Physics: Basic Research for Tomorrow’s Technology, National Academy Press, Washington, D.C. (1999).
>> D. Schurig et al. Science 314(5801), 977-80 (2006).
>> O.N. Singh and A. Lakhtakia, eds. Electromagnetic Fields in Unconventional Materials and Structures, Wiley, New York, N.Y. (2000).
>> Royal Society and Royal Academy of Engineering. Nanoscience and Nanotechnologies: Opportunities and Uncertainties, RS Policy document 20/04, RAEng Policy document R2.19, London, United Kingdom (2004).

>> D.G. Stavenga. J. Eur. Opt. Soc. Rapid Pub. 1, 06010 (2006).


>> G. Tayeb et al. Opt. Photon News 14(2), 38-43, 49 (2003).
>> W.S. Weiglhofer and A. Lakhtakia, eds. Introduction to Complex Mediums for Optics and Electromagnetics, SPIE, Bellingham, Wash. (2003).
PROCEEDINGS • SPRING 2023 WWW.RADIOCLUBOFAMERICA.ORG 25 OPN January 2007 | 39
Lakhtakia (akhlesh@psu.edu) is the Charles Godfrey Binder Professor of Engineering Science and Mechanics at Pennsylvania State University. Tom G. Mackay is a lecturer at the School of Mathematics at the University of Edinburgh in Edinburgh, United Kingdom. ]
Nanotechnological approaches appear promising for the fabrication of multifunctional metamaterials.
Member
WARRIORS 4 WIRELESS
Warriors 4 Wireless is a charitable organization existing soley to help veterans find decent paying careers in the growing 5G wireless workforce. We have invested well over $3,300,000 of contributed funds to assist veterans joining the telecom workforce. And we have connected over 3,300 veterans to telecom career opportunities. Let us help you!

WE ARE ALWAYS SEEKING THE BEST VALUE FOR EVERY VET! Want more information?
www.warriors4wireless.org

Support RCA Youth Activities by Donating Your Frequent Flyer Miles
Due to the efforts of Carole Perry, the Youth Activities Program has been very successful. During the year, Carole travels all over the country to meet with people and to speak on behalf of the program. Almost all of the travel is at Carole’s personal expense. You can help by donating your frequent flyer miles to the Radio Club. If you would like to participate, please contact Carole Perry at wb2mgp@gmail.com and she will assist you.
PROCEEDINGS • SPRING 2023 WWW.RADIOCLUBOFAMERICA.ORG 26
RCA’S 2022 Wireless Innovation Award Acceptance
EDITOR’S NOTE: Arlene Harris received RCA’s Innovation Award at the 113th Radio Club of America banquet and awards ceremony. Established in 2022, this award is bestowed by RCA’s Board of Directors for creating a new concept or product to be used in the wireless industry. The following text presents Ms. Harris’ acceptance speech that was brought into the banquet via Zoom.
Hello to all of my good friends at the Radio Club of America this evening. I hope you are having a good time. I am so sorry that I could not be there in person.
It has been a long time, but I know that part of my life was enriched by the evenings I spent at Radio Club. I have been a member of the Radio Club since the mid-1980s. Some of my fondest memories are attending the Radio Club dinners at the New York Athletic Club with wireless pioneer friends like Fred Link and Mal Gurian. The Radio Club has been a bastion for innovators like Mal and Fred, and of course, my husband Marty Cooper, and many of the great names of all time in radio communications.
In the shadow of all these giants, it is an overwhelming honor to be awarded this first ever Radio Club recognition for innovation.
Our early innovators laid the groundwork for the wireless revolution. My most meaningful contribution was not in radio itself, but from the next wave of opportunities that wireless created, leading a talented team to make the first cellular prepaid management system in the midto-late 1980s. It was humbling to work in the shadow of giants in the industry. As cellular systems were built
around the world, the continuing improvements in prepaid options enabled a frictionless way for consumers to pay for cellular service, helping to raise billions out of poverty. Wow, what a big deal; more than I ever imagined.
I think about how this little group of people that work with me helped build those original systems. We could not possibly have imagined what their innovations would become. I know many of you today are working on little projects or maybe some big projects that are someday going to change someone’s life.
We are all challenged to innovate, to solve problems, big and small every day. We as individuals and citizens of a challenged world have lots of problems to solve, where radio will play an essential role for the good work you do. I expect that many of you will one day be recognized by the Radio Club for your important contributions, making life better, making a better world and the world a better place to live.
I am totally humbled by being the first recipient of this award, I certainly appreciate this honor more than you can know. I am grateful for you, and I am grateful for this recognition. Thank you very much and have a wonderful evening.
Meet the 2023 RCA Board of Directors
• David Bart, President (Skokie, IL) term ends 2024
• Don Root, Executive Vice-President (Ashland, VA) term ends 2024
• Rich Berliner, Vice President (Warren, NJ) term ends 2024
• Chester “Barney” Scholl, Vice President/Counsel (Hermitage, PA) term ends 2023
• Edward Ryan, Vice President/Co-Counsel (Melville, NY) term ends 2023
• Ronald Jakubowski, Treasurer (Cape Canaveral, FL) term ends 2023
• Margaret Lyons, P.E., Secretary (Freehold, NJ) term ends 2023
• John Facella, P.E., President-Emeritus (Raymond, ME)
• Jon Paul Beauchamp, Director (Mount Laurel, NJ) term ends 2023
• Ernie Blair, Director (Huntsville, AL) term ends 2023
• Dr. James Breakall, Director (Port Matilda, PA) term ends 2024
• Karen Clark, Director (Littleton, CO) term ends 2024

• Verle “V.G.” DuVall, Director (Kingwood, TX) term ends 2023
• Michael Kalter, Director (Xenia, OH) term ends 2024
• Charles Kirmuss, Director (Westminster, CO) term ends 2024
• Denis Marin, Director (Banning, CA) term ends 2023
• Bruce McIntyre, Director/President-Emeritus (Safety Harbor, FL) term ends 2023
• Carole Perry, Director (Staten Island, NY) term ends 2023
• Stanley Reubenstein, Director/President-Emeritus (Aurora, CO) term ends 2024
• Paul Scutieri, Director (Raleigh, NC) term ends 2023
• Dr. Julio Urbina, Director (Port Matilda, PA) term ends 2024
PROCEEDINGS • SPRING 2023 WWW.RADIOCLUBOFAMERICA.ORG 27
Arlene Harris, recipient of the 2022 Radio Club of America’s Wireless Innovation Award.
2022 RCA Fellows Acceptance
Each year, RCA elevates to Fellow a small group of members whose contributions to the art and science of radio communications or to the Radio Club of America are deemed outstanding. Elevation to Fellow status is approved by the board of directors after nomination and review. This occurs when they have been a member with RCA for at least five years and they have made substantial contributions either to the science and/or the art of radio, broadcast, or to the organization itself.
The RCA board of directors selected the following members to be elevated to Fellow status in 2022:
• Lynn J. Bisha, W2BSN – for contributions to amateur radio and contributions to the collection and preservation of wireless history at the Antique Wireless Association as a curator and board member.
• Professor Jim Breakall, WA3FET – for an outstanding academic career and leadership in research, teaching, amateur activities, and contributions to RCA’s board of directors and the RCA Technical Symposium.

• Jason Kern – for leadership in a thirty-year career in public safety communications encompassing senior positions at APCO and a range of government agencies.
• Neil Horden KB6PEX – for leadership and contributions in a career of more than 40 years in the wireless industry focusing on land mobile radio product management and technology strategy in the public safety arena.
• Pete Varounis, NL7XM – for a lifetime of amateur radio activities and leadership and for the collection and preservation of wireless documentation.
Neil Horden accepted on behalf of the 2022 class of RCA Fellows, and he delivered the following comments:
Good evening and thank you very much to the entire Radio Club of America as well as the board for this fantastic honor. After spending a career in wireless that started, I guess, somewhat unofficially with running a high school radio station many years ago…okay, that’s a little bit of a fib. It started when I was seven years old, and I got a set of walkie-talkies.
After meandering mostly through what I thought was going to be a career in broadcast, I then somehow stumbled into the world of Public Safety Communications. That carried me for the rest of my career.
After listening to the Technical Symposium sessions today, I really thought about the first one. It mentioned Maxwell and how we are standing on the shoulders of the giants that came before us.
I thought back to my first RCA event, a time when I was not even a member, I, at an early professional age, was dragged along by my boss. I won’t say what age, but it was probably 35 years ago or so. At that event I had the honor of meeting Fred Link. For those of you who may not know the microwave world, you need to understand that he started a company that became universally known in the industry.
He has since passed, but I realized that some of the people in the room today are closer to my age at that early point in my career. They are here tonight and were in the sessions presented today. They may, in 30 or 35 or 40 years in the future, have a similar honor, and they may think back to the sessions that they heard today, and realize just how much came before them.
I hope that they too can build upon their giants and create a wonderful future.
On behalf of the new Fellows, thank you very much to RCA, and thank you from all the Fellows for this honor.
PROCEEDINGS • SPRING 2023 WWW.RADIOCLUBOFAMERICA.ORG 28
Neil Horden delivering the acceptance on behalf of the new class of 2022 RCA Fellows.
RCA Tours Georgia Tech
Prior to the 2022 awards banquet and technical symposium, Radio Club of America (RCA) members toured Georgia Institute of Technology’s (Georgia Tech) wireless research facilities and makerspace. Thank you to Georgia Tech professors Dr. Nima Ghalichechian and Dr. Mary Ann Weitnauer, both RCA members, for making these arrangements with former RCA president John Facella.
Activities included presentations by PhD students, and later in the day, RCA’s pizza party for Georgia Tech college and graduate students. RCA’s pizza party included a presentation by RCA’s Dr. Julio Urbina about the history of Arecibo Observatory, emphasizing the role played by RCA members. Carole Perry joined the RCA party with Georgia Tech students and former RCA Young Achievers Divyam Mishra (alumni) and Audrey McElroy (current). Twenty RCA members participated in these activities.
Specific laboratory tours included:


• mmWave Antennas & Arrays Lab – Dr. Ghalichechian’s Group, School of Electrical and Computer Engineering
– The research in this group is interdisciplinary and centers around applied electromagnetics, specifically, mmWave (30-300 GHz) antennas and arrays. These include phased arrays, reflectarrays, on-chip antennas, ultra-wideband antennas, reconfigurable antennas, phase-change materials, 3D-printed lenses and arrays, and robotic measurements of antennas. – Several of the current PhD students spoke or were present, including David West, Seung Yoon, Sree Adinarayana Dasari, Walter Disharoon, Thomas G. Williamson. Several past PhD and Master’s Degree students also participated.
• ATHENA Lab –Dr. Manos Tentzeris’ lab explores the advancing and development of novel technologies for electromagnetic, wireless, RF, mm-wave and subTHz applications. Research includes areas such as


PROCEEDINGS • SPRING 2023 WWW.RADIOCLUBOFAMERICA.ORG 29
A slide show was also broadcast during the tour that illustrated some of the research conducted in the mmWave Antennas & Arrays Lab. Sample slides included:
RCA Tours Georgia Tech continued…

telecom, defense, space, automotive, health, smart skin, weather/climate and sensing areas and combines inkjet-printing, flexible paper/organic substrates, nanotechnology-based structures and green energy scavenging. – Several of the current PhD students spoke or were present, including Charles Lynch, Kexin Hu, I-Ting Chen, Lauryn Smith, Genaro Soto Valle, Madeline Holda, Will Callis, Marvin Joshi, Nathan Wille, and Hani Al Jamal. Several past PhD and Master’s Degree students also participated.
• Low Frequency Radio Lab – This group uses electromagnetic waves between 0.5-500 kHz to explore the Earth’s natural electricity, while developing practical applications. Low frequency (LF) radio waves have a large number of applications, including: (1) Lightning produces powerful low frequency waves, which are essentially a fingerprint of the lightning; (2) LF waves reflect at 80 km altitude, and can travel around the world for global communications and navigation; (3) LF waves penetrate into the ground and seawater, making them useful for underground communications and mapping; (4) LF waves allow diagnostics of the ionospheric D-region, which is too high for balloons yet too low for satellites; (5) LF waves escape into space, interacting with particles that otherwise damage and





destroy satellites, and trigger aurora; (6) LF waves are extremely difficult to generate, so we need radically different kinds of antennas to broadcast. – Several of the current PhD students spoke or were present, including Evan Worthington, Nathan Opalinski, Nikhil Pailoor, Roderick Gray, Charles Topliff, David Richardson, Shweta Dutta, Liam Smith, Joe Ellis, Jeremy Lightner, and Varun Rajput.
• L3Harris Fabrication Laboratory – This laboratory promotes education and research, fosters creativity, innovative designs and invention; and provides spaces and tools to encourage intellectual expression for current and future generations of Georgia Tech students.
• Van Leer Interdisciplinary Design Commons (IDC) – This is the largest electronics-oriented student makerspace in the U.S. IDC is open to electrical and computer engineering students, as well as students from other majors. Like other makerspaces on campus, IDC offers students a hands-on learning environment where they can work together to solve technology design challenges.
• Georgia Tech Amateur Radio Club, W4AQL – we did spot the club office, but no one was home.
Georgia Tech Tour Snapshots
PROCEEDINGS • SPRING 2023 WWW.RADIOCLUBOFAMERICA.ORG 30











PROCEEDINGS • SPRING 2023 WWW.RADIOCLUBOFAMERICA.ORG31
RCA’s 2022 Technical Symposium
Was a Huge Success!
The Technical Symposium held in Atlanta on November 19, 2022 was a huge success. RCA’s annual opportunity to learn about innovative wireless technology moved forward live for the first time since the pandemic. We had significant participation. The all-day symposium has indeed become one of the wireless industry’s premier events. RCA presented ten sessions in one of our largest programs ever. Presentations covered the origins of wireless theory (Maxwell), ionospheric sensing techniques, 5G antennas, small satellites, satellite security, RCA youth activities and a youth presentation, scalable 5G design, HAARP research, and 6G.
The presentation slides and the video of the presentations are available on the RCA website and presentations can be seen on the RCA YouTube channel. Those who attended the event and needed continuing education units (CEUs) for their professional engineering licenses were able to do so for a nominal fee.
Thank you to Dr. Jim Breakall, Dr. Julio Urbina, and Dr. Nathan “Chip” Cohen for organizing this terrific annual event.
As in previous years, the Technical Symposium audience voted for the best presenters based on numerous criteria. Incredibly, there was a threeway tie for first place, congratulations to all three!
• Carole Perry: RCA Youth Activities
• Rachel Jones: The Current State of Satellite Security
Saturday, November 19, 2022
Atlanta, GA
• Divyam Mishra: Designing a Scalable 5G-Enabled Connected Intelligent Edge Preparations are already underway for the 2023 Technical Symposium in Denver. A call for abstracts for this year’s Symposium and an invitation to prospective presenters to submit their ideas can be found on the RCA website.
We hope to see you all live in 2023!
THANK YOU 2022 TECHNICAL SYMPOSIUM PRESENTERS
In case you missed it, the presentations are available on RCA’s website.
• Dr. Akhlesh Lakhtakia (PennState University) - From Maxwell to Nanotechnology.
• David Richardson (Georgia Tech, PhD student) - A Look at Current Lower Ionospheric Sensing Techniques and a Movement Towards a Unified Approach.
• Dr. Nima Ghalichechian (Georgia Tech) - Antennas and Arrays for Future 5G Systems.
• Dr. Nathan “Chip” Cohen (Fractal Antenna Systems, Inc.)Big Problems Solved for Small Satellites.
• Rachel “RC” Jones (Univ. North Dakota, PhD student)The Current State of Satellite Security

• Carole Perry (RCA) - RCA’s Youth Activities
• Audrey McElroy (Georgia Tech, student) - Youth Presentation: From High Schooler to Ramblin’ Wreck: Youth in Amateur Radio from the Perspective of a Young Woman in Engineering.
• Divyam Mishra (Qualcomm) - Designing A Scalable 5G-Enabled Connected Intelligent Edge.
• Steve Floyd (HAARP) - The High Frequency Active Auroral Research Program, “HAARP”, a Brief History and Engineering Review.
• Dr. Mahhavan Swaminathan (Georgia Tech) - Advanced Packaging for 6G Communications.
• Dr. Jim Breakall, Dr. Julio Urbina, Dr. Nathan “Chip” CohenModerators.
PROCEEDINGS • SPRING 2023 WWW.RADIOCLUBOFAMERICA.ORG 32
RCA TECHNICAL SYMPOSIUM
2023 RCA Technical Symposium

The 2023 Technical Symposium will be in Denver on Saturday, November 18. Topics and speakers are still being organized. We are looking for presenters in any of the areas of wireless technology including antennas, broadband, broadcast, cellular, land mobile radio, military, satellite, or other wireless related technologies. RCA especially likes to feature ‘early work’ and offers an opportunity for researchers and companies to gain feedback on the technologies that they are developing.

We are calling for abstracts from potential presenters. Please contact Dr. Jim Breakall, Dr. Julio Urbina, or Dr. Nathan “Chip” Cohen if you have suggestions or ideas, please email to info@radioclubofamerica.org.
Also, make your reservations early. The hotel block sells out quickly. Information is on the RCA Website: https://www.radioclubofamerica.org/content.aspx?page_ id=22&club_id=500767&module_id=470167.
PROCEEDINGS • SPRING 2023 WWW.RADIOCLUBOFAMERICA.ORG 33
Wear it on its own, or add Life Member, Senior Member, or Fellow bars to reflect your unique membership distinctions. • $9.95 for the standard pin • $3 per bar for Life Member, Senior Member, and Fellow bars ORDER AT: https://bit.ly/3eqX64O Prices include shipping & handling. DISPLAY YOUR RCA MEMBERSHIP WITH OUR CUSTOMIZABLE MEMBER PINS! Save the Date! 2023 Technical Symposium and 114th Awards Banquet SATURDAY, NOVEMBER 18, 2023 | DENVER, COLORADO
Candids From the 2022 Technical Symposium & Banquet











PROCEEDINGS • SPRING 2023 WWW.RADIOCLUBOFAMERICA.ORG 34
Candids From the 2022 Technical Symposium & Banquet











PROCEEDINGS • SPRING 2023 WWW.RADIOCLUBOFAMERICA.ORG 35
Save the Date!
Featuring Keynote Speaker Dr. Marty Cooper, one of Time magazine's “100
REASONS
Cutting edge technical learning
Presentations on a wide variety of wireless topics, from emerging technology to historical aspects, make this a fascinating and educational event.
Strengthen your network
Join us in Denver, and meet members of the RCA Rocky Mountain Chapter.
Honor the distinguished and deserving
Join us to celebrate the people who invent, create, inspire and collaborate to create the products, services, and companies that make this industry one of a kind.
Support the next generation
Help develop the future workforce by supporting RCA’s youth efforts, and learn from this year’s Young Achiever Award Winner.
Participate in a facility tour
We will be touring the NIST facility, the Wings Over the Rockies Museum, and more.
Discover Denver!
We are excited to bring these events to the Rocky Mountain Region, and truly hope this provides greater opportunity for involvement for our members west of the Mississippi. What an opportunity for our members and peers to visit this incredible city.

PROCEEDINGS • SPRING 2023 WWW.RADIOCLUBOFAMERICA.ORG 36
ATTEND THE RCA BANQUET AND TECHNICAL SYMPOSIUM
NOVEMBER 18
Register for the 2023 Technical Symposium and Banquet at www.radioclubofamerica.org 2023 TECHNICAL SYMPOSIUM AND 114TH BANQUET &
TO
SATURDAY,
| DENVER, CO
AWARDS PRESENTATION
Best Inventors in History.”
THANK YOU 2022 SPONSORS






The Radio Club of America Board of Directors and its members would like to thank the generous 2022 sponsors. Be sure to tell them that you saw their company mentioned in the Radio Club of America Awards Program.




GOLD 2022 AWARDS PROGRAM SPONSORS
TABLE OF 8
OTHER COMPANY DONATIONS
ANNUAL RCA SPONSORS







THANK YOU MEMBER DONORS

PROCEEDINGS • SPRING 2023 WWW.RADIOCLUBOFAMERICA.ORG 37
Andy Maxymillian, PMP Principal Consultant Blue Wing Services 235 Summer Hill Drive Gilbertsville, PA Telephone: Mobile: E-mail:
Ernie Blair | Margaret Lyons | Stan Reubenstein | Charles & Mary Soulliard
SILVER BRONZE







PROCEEDINGS • SPRING 2023 WWW.RADIOCLUBOFAMERICA.ORG 38 Andy Maxymillian, PMP Principal Consultant Blue Wing Services 235 Summer Hill Drive Gilbertsville, PA 19525 Telephone: (610) 473-2171 Mobile: (610) 316-2660 E-mail: andrew.maxymillian@bluewing.com Our organization grows and encourages innovation because of your support. With your support, our organization continues to grow and encourage innovation. Thank you! SECURE YOUR 2023 SPONSORSHIP TODAY! Thanks to our sleek new RCA web site, opportunities to host innovative virtual programs and more new ways to connect with RCA members, being an RCA sponsor is a better-than-ever investment in the future. Contact Karen Clark, Sponsor Committee Chair at kjclark33@comcast.net for more information!
RCA’S 2023 Banquet to Feature Dr. Marty Cooper In Denver
The Radio Club of America (RCA) is thrilled to announce that Mr. Martin “Marty” Cooper will be featured at the 2023 banquet and awards ceremony to be held in Denver, Colorado. Originally scheduled to speak at RCA prior to the pandemic, we are thrilled to see Dr. Cooper in person in 2023.
This year marks the 50th anniversary of Dr. Cooper’s historic walk on Sixth Avenue in Manhattan, the first public demonstration of a mobile handheld telephone. Dr. Cooper will be introduced by his spouse, Ms. Arlene Harris, recipient of RCA’s 2022 Wireless Innovation Award, and a legend of her own in the wireless industry, known as “the first lady of wireless.”


Dr. Cooper is the recipient of numerous awards including RCA’s Fred Link Award and Lifetime Achievement Award. Among his many honors, he is an IEEE Centennial Medalist, Marconi Prize recipient, IEEE Eta Kappa Nu Eminent Member, and Charles Draper Prize recipient from the National Academy of Engineering. He has been inducted into the Consumer Electronics Hall of Fame and Wireless History Foundation’s Wireless Hall of Fame. He is a lifetime member of the IEEE, was president of its Vehicular Technology Society. In 2007, Time magazine named him one of the “100 Best Inventors in History.” He is a Prince of Asturias Laureate.
We welcome Dr. Cooper and encourage all to attend the RCA banquet. Further information is available on the RCA website
RCA’S 2023 BANQUET
RCA’s 2023 banquet will take place in Denver on Saturday, November 18 at the Hyatt Regency. We look forward to seeing everyone in November for this rare and very exciting opportunity.

PROCEEDINGS • SPRING 2023 WWW.RADIOCLUBOFAMERICA.ORG 39
Dr. Marty Cooper with original Motorola mobile phones.
RADIO CLUB OF AMERICA
Denver – Host City for the 2023 Radio Club of America Banquet and Technical Symposium.
DR. MARTY COOPER
Dr. Cooper is a pioneer in wireless communications and radio spectrum management who has eleven patents. He invented the first handheld cellular mobile phone in 1973, led the team that developed it and brought it to market, and is considered the father of the handheld cell phone. He is also cited as the first person to make a handheld mobile phone call in a public demonstration. He was born in Chicago and graduated from the Illinois Institute of Technology (IIT). He served as a submarine officer during the Korean War, later returning to IIT and earning his master’s degree in electrical engineering, and also receiving an honorary doctorate degree. He currently serves on the university’s board of trustees.
Dr. Cooper started his career at Cooper Teletype Corporation and then joined Motorola, Inc. as a senior development engineer in the mobile equipment group. He worked at Motorola for the next 29 years, rising to Vice President and Corporate Director of Research and Development. He was responsible for building and managing Motorola’s paging and cellular businesses. He also led the creation of trunked mobile radio, certain types of oscillators, liquid crystal displays, piezo-electric components, Motorola AM stereo technology and various mobile and portable product lines. He was instrumental in expanding pager technology from use within a single building to use across multiple cities. He also worked to enhance the manufacture of quartz crystals used in Motorola’s radios, that later benefited the company when it started mass-producing the first crystals used in wristwatches.
LATER YEARS
A serial entrepreneur, Dr. Cooper and his wife, Arlene Harris, cofounded numerous wireless technology companies. This includes Cellular Business Systems, SOS Wireless Communications, GreatCall, and ArrayComm. He is currently chairman of Dyna LLC and a member of the FCC’s Technological Advisory Council.
COOPER’S LAW
“Cooper’s Law” addresses the efficiency of voice/ data communications over the radio spectrum. Dr. Cooper found that the ability to transmit different radio communications simultaneously and in the same place has grown at the same pace since Guglielmo Marconi’s first transmissions of wireless telegraphy at the end of the 19th century. This led Dr. Cooper to formulate the Law of Spectral Efficiency, otherwise known as Cooper’s Law. This law states that the maximum number of voice conversations or equivalent data transactions that can be conducted in all of the useful radio spectrum over a given area doubles every 30 months.
Today, the number of radio signals in the world that can be simultaneously sent without interfering with each other exceeds one trillion. This is based on calculations involving effective signal strength and how much today’s technology has split up the electromagnetic spectrum. The partitioning of the spectrum in ever finer degrees is one reason a roomful of people can now simultaneously use their mobile phones, Bluetooth headsets, WiFi laptops, etc., without their signals interfering with one other. Cooper’s Law implies that wireless Internet connections will reach ever more people at ever greater speeds until, theoretically, everyone is able to use the full radio spectrum without interfering with anyone else.
THE FIRST HANDHELD MOBILE PHONE
Inspired by Dick Tracy’s wrist radio in the Sunday newspaper cartoons, Dr. Cooper believed from the beginning that the cellular phone should be a “personal telephone – something that would represent an individual so you could assign a number; not to a place, not to a desk, not to a home, but to a person.” Motorola invested $100 million between 1973 and 1993 bringing the product to market before any revenues were realized. The original handset, the DynaTAC 8000x (DYNamic Adaptive Total Area Coverage) weighed 2.5 pounds (1.1 kg) largely due to the battery. It measured ten inches (25 cm) long and was dubbed “the brick” or “the shoe” phone and had only 30 minutes of talk time before requiring a 10-hour recharge. Within ten years, the size and weight reduced by half.
On April 3, 1973, Dr. Cooper famously demonstrated two working phones to the media and to passers-by prior to walking into a scheduled press conference at the New York City Hilton in midtown Manhattan. Standing on Sixth

PROCEEDINGS • SPRING 2023 WWW.RADIOCLUBOFAMERICA.ORG 40
A July 1973 report of the public demonstration of the DynaTAC.
Avenue near the Hilton, Cooper made the first handheld cellular phone call in public from the prototype DynaTAC. Reporters and onlookers watched as Cooper dialed the number of his chief competitor Mr. Joel S. Engel at AT&T. “Joel, this is Marty. I’m calling you from a cell phone, a real handheld portable cell phone.” That public demonstration landed the DynaTAC on the July 1973 cover of Popular Science magazine. As Cooper recalls from the experience: “I made numerous calls, including one where I crossed the street while talking to a New York radio reporter – probably one of the most dangerous things I have ever done in my life.”
CUTTING THE CORD
In January 2021, Dr. Cooper published Cutting the Cord: The Cell Phone Has Transformed Humanity. The book/ memoir offers an intimate and fascinating account of
INNOVATION
the cell phone story. It includes lessons about the keys to innovation, how to manage it, failure and why it is important to innovation, and how to inspire others. Dr. Cooper offers readers his life’s lessons, gleaned from his unique perspectives derived from many years of leading dreamers who are dedicated to making the future a reality.
SAVE THE DATE
The Radio Club of America looks forward to seeing everyone in Denver on November 18 to meet Dr. Cooper, his spouse Arlene, and to celebrate 50 years of wireless achievements.
FORUM TO BE HELD AT HAMVENTION

INCLUDES LEADING RCA MEMBERS
Moderator: Dr. Nathan “Chip” Cohen, W1YW
Speakers: Howard Rosen, VE2AED; Dr. Nathaniel Frissell, W2NAF; Dr. Jim Breakall, WA3FET; Stephen Floyd, W4YHD; Marty Sullaway, NN1C; Dr. Ted Rappaport, N9NB; Jeremy Hong, KD8TUO; Jack Nilsson, N8NDL and Isaac Bentley, NB6F
The INNOVATION FORUM is a special event associated with Hamvention. It is an introduction and showcase of amateur radio’s “enhancement of the radio art.” The forum will be on May 19 at noon in the Hamvention Forum Room 1.

Our speakers are examples of those who have made major inroads in invention, radio science, engineering, or technical entrepreneurship, in ham radio and in related fields – enabled by skills and knowledge first acquired and nurtured as radio amateurs.
We will discuss: What were/are their paths like? What help did they get through ham radio? What roadblocks did they encounter and how did they overcome them?
Their stories are fascinating and inspiring and just a few examples of the value that amateur radio brings to wireless, telecom, and progress in the human condition.
Although not an RCA event, RCA members presenting include Dr. Ted Rappaport N9NB, Howard Rosen, VE2AED; Dr. Nathan “Chip” Cohen, W1YW; and Dr. Jim Breakall, WA3FET. Join us!
PROCEEDINGS • SPRING 2023 WWW.RADIOCLUBOFAMERICA.ORG 41




track. manage. maintain. software solutions designed for mission critical communications systems the only asset management solutions that can integrate with your radio system www.mcmtechnology.com scan to learn more Proud Sponsor of the 2022 Radio Club of America Annual Awards Banquet and Technical Symposium
Welcome to the Radio Club of America, the oldest and most prestigious organization dedicated to the advancement of radio communication and electronics! We are delighted to have you join us as a member and look forward to getting to know you.
As a new member, you have joined a community of individuals who share a passion for wireless communication. Our members come from all corners of the industry, including engineers, educators, broadcasters, researchers, and enthusiasts. We are committed to promoting the latest developments in wireless communication and fostering innovation and excellence in the field.

One of the benefits of membership in the Radio Club of America is the opportunity to network with other members who share your interests and expertise. Our members are leaders in their fields, and by joining the RCA, you become part of a community of professionals and experts in the industry. You’ll have access to a wealth of knowledge and experience that can help you advance your career and stay up-to-date with the latest developments in the field. We also offer a variety of resources to help you stay informed about the latest news, trends, and developments in wireless communication. Our website and publications, such as the Proceedings, provide valuable information and insights that can help you stay ahead of the curve. Additionally, we offer webinars, symposiums, and other events where you can connect with other members, learn about new technologies and trends, and share your own experiences and knowledge.
Finally, we want to emphasize that the Radio Club of America is a community built on inclusivity, diversity, and


respect for all members. We value the unique perspectives and contributions that each member brings to the table, and we strive to create a welcoming and supportive environment for all. As a member of the RCA, you’ll have the opportunity to connect with individuals from different backgrounds and experiences, and we encourage you to engage in meaningful conversations and share your own unique perspective.
Once again, welcome to the Radio Club of America. We are excited to have you as a member and look forward to all the great things we can accomplish together!
Ernie ALsop, Monroe, WA
Larry Bell, Dodge City, KS
Boris Dinkoff, Toronto, ON
Tony Downs, Waddy, KY
Patrick Foster, Lakewood, CO
George Franklin, Aiken, SC
Stephen Jeffries, Elgin, IL
Derek Kozel, Calistoga, CA
Jon Lanenga, Fort Meade, MD
Stephen Nordstrom, Las Vegas, NV
Michael Richardson, Santa Barbara, CA
Alvin Schmitt, Newport, VA
Peter Sturdivant, Standish, ME
Michelle Thompson, San Diego, CA
PROCEEDINGS • SPRING 2023 WWW.RADIOCLUBOFAMERICA.ORG 43
Members! Purchase RCA apparel from our online store. Options are available for men and women. Order now at https://www.cafepress.com/radioclub Display your RCA membership with pride!
Welcome New
New members as of April 21, 2023
RADIO CLUB OF AMERICA INTERVIEW WITH DR. MARTY COOPER ON THE 50TH ANNIVERSARY OF THE PUBLIC DEMONSTRATION OF THE FIRST HANDHELD MOBILE TELEPHONE
Interviewers: David Bart and John Facella
EDITOR’S NOTE: April 3, 2023 marked the 50th anniversary of Dr. Marty Cooper’s historic demonstration of the first handheld mobile telephone while walking on Sixth Avenue in Manhattan. The Radio Club of America interviewed Dr. Cooper about this historic event in the days leading up to that anniversary. The interview can be seen on RCA’s YouTube channel. The following transcript records the discussion hosted by David Bart and John Facella, the current and immediate past presidents of RCA, respectively. The transcript has been edited for print publication.
[DAVID BART] Thank you for joining us. We are recording this interview with Dr. Marty Cooper, formerly of Motorola, who is a pioneer in the wireless communications industry, especially in radio spectrum management. He has 11 patents in the field. I am joined by John Facella, the former president of the Radio Club of America. My name is David Bart. I am the current president of the Radio Club of America.
Over the next little while, we hope to celebrate the 50th anniversary of the first publicly demonstrated mobile phone call made in New York City on April 3, 1973. Dr. Cooper is considered the father of the handheld cell phone. He is the first person in history to make a handheld cellular phone call in public on that date in 1973. He is also the co-founder and current chairman of Dyna LLC, and he was the founder and CEO of Arraycom. He is the recipient of numerous awards for his achievements in wireless technology. He received the Marconi Prize in 2013.
So, with that, congratulations Dr. Cooper on the 50th anniversary of your historic achievement. What does that anniversary mean to you?
[DR. MARTY COOPER] Well, first of all Dave, if you could call me Marty. We have known each other long enough, so we don’t have to be formal. I think on the 50th anniversary that you will be surprised at my viewpoint. Over the past 50 years I think that we are still in the game stage of cellular technology; we have been experimenting. We have gotten incredible technology into our cell phone and into the networks, but we are still experimenting. We are still trying to do things so that the industry is really still just starting. The real impact on society of the cellular phone and cellular technology is just starting.
By the way, Dave and John, thank you for being on this interview. I really look forward to it, and I hope we get to talk a little bit in this session about what the cell phone is really going to do for us in the future.
[DAVID] Some of our viewers may be unfamiliar with that original DynaTAC phone. Can you hold it up and show us what it looks like, and how you operated it on that day? Maybe you could give us a little sense of how heavy it is?
[MARTY] Let’s see. This is an exact model of a phone I used that day. It looks bigger because it’s closer to you on the screen, but you get a feel for how big it is. It weighs over a kilo, over two pounds, and it had a battery life of 25 minutes of talking. That wasn’t a problem, Dave and John, because you couldn’t hold this thing up for 25 minutes it was so heavy.

[DAVID] It really is about the size and weight of a common brick, and so it was nicknamed “The Brick” over the years.
[MARTY] Yes, it is. It was for that time an incredible achievement, because both of you are old enough to know what a cell phone looked like when it was a car phone and what two-way radios look like. This phone incorporates everything that a two-way radio does, plus it talks and listens. It had a new frequency band, 900 MHz. If you recall what two-way radios were, they had maybe up to six channels. This thing had 450 channels
PROCEEDINGS • SPRING 2023 WWW.RADIOCLUBOFAMERICA.ORG 44
FEATURE
A conversation with Dr. Marty Cooper, creator of the first handheld mobile telephone.
Interference Detection and Mitigation
Intermodulation Studies
Distributed Antenna Systems( ERCES)
Design / Review / P.E. Approval
System Analyzation
Project Management
Engineer-Furnish-Install (EFI)
System Design / Construction
System Optimization
System Integration
End User Equipment Training
Radio Paging Systems
Paging Systems Engineering
User Needs Assessment
System Performance Troubleshooting
Technology Assessment
Request for Information
Preparation of Acceptance Test Plans
Request for Proposal
Execution of Acceptance Test Plans
Vendor Relationship
FCC Licensing and Carey Curves
Budget Cycle Management
Radio Frequency Coverage Verification
Radio Frequency Engineering
Drive Testing
Quality Audits
NEPA Studies
Link Budget
Antenna Systems
Nurse Call Systems Integration
Coverage Maps
Simulcast Radio Design
Site Selection Process
System Performance and Auditing
FCC and ETA Certification Testing

PROCEEDINGS • SPRING 2023 WWW.RADIOCLUBOFAMERICA.ORG 45 ENGINEERING SERVICES DESIGN ENGINEERING FROM A FIELD PERSPECTIVE WITH OVER $250,000 IN TEST EQUIPMENT Let IWATSI provide you with decades of engineering experience from the perspective of a factory field designer that happens to be a Registered Professional Engineer and a Lifetime Member of IEEE Design Installation Maintenance Training “It’s more than Push-to-Talk” www.iwatsi.com Email: support@iwatsi.com 844-IWA-TECH (844-492-8324) 7711 Scotia Drive | Dallas, TX 75248 www.iwatsi.com 844-IWA-TECH (844-492-8324)
SERVICES INCLUDE….
“”PE” Engineering Services Available
DESIGN / ENGINEERING
Registered Professional Engineer and a Lifetime Senior Member of IEEE
available to it. Modern cell phones, as you know, now have many thousands of channels available. So, for its time, it was a great achievement, but it’s also a reflection of what a primitive time 1973 was. There was no internet; it had not yet been made available. There were no digital cameras. There were no integrated circuits. So, the idea that you could actually make a handheld phone with wired components was an incredible achievement for my team at Motorola.
[DAVID] The magic of this is that it tapped directly into the phone circuits of the world. It wasn’t just a radio with a push-to-talk operation in a very confined radius. So, you really invented an entire system, where the phone could talk to a relay, which would then connect into the telephone circuits.
[MARTY] Well that’s right Dave. The afternoon of that first phone call we did a press conference, and we asked the members of the press whether anybody wanted to make a call themselves. One lady got up and said, “I’d like to call my family in Australia,” and I said, “Of course that will work.” She was under the impression that this phone was talking from that room at the downtown Hilton [on Sixth Avenue in Manhattan] all the way to Australia. Of course, we knew that it was talking to the building across the street. The rest of the way was on the public network.
[JOHN FACELLA] Marty, I just want to give a plug for your book, Cutting The Cord. I have read it from cover to cover, and it’s a fascinating story that you have recorded. I joined Motorola in 1973, but a little bit after the cell phone was announced. I think the book does a lot of justice to the difficulty in

coming up with a revolutionary invention like you did at the time.
[MARTY] The book is called Cutting The Cord. I have got the book open. I guess I can show you some images about when we created the first phone. I assembled the top designers at Motorola. None of them worked for me. They worked for the division as a whole. I ran a subdivision of Motorola at the time. But they were so excited about this project that they just stopped all their other work. They didn’t stop charging other people for their time, but they stopped all their other work so they could work on this project.
In 1973, there was no such thing as a cell phone. The team actually invented a slider phone, a flip phone, a curved phone, a sausage phone and gave me the choice of having this phone in any configuration you could imagine. Really creative people. We ended up selecting this very simple block design, The Brick. The reason was obvious. We wanted this to be as simple as it could be; because as you know, whenever you want to demonstrate something, if something can go wrong it will go wrong, and so we wanted to minimize the possibilities of a failure.
The team that was incredible. We assembled the top circuit designers and circuit developers at Motorola. There were 22 people on the team, but we also embraced technology from all over the company. We went through the Semiconductor Division and got a processor chip that had not yet been fully developed. They let us use that chip, so we could use it for the frequency synthesizer. We went to our antenna group, and they created a 900 MHz antenna that would work on a handheld unit. The duplexer was a major challenge. The duplexer in the car phones that existed at that time were bigger than your fist. There was no way you could put a duplexer like that into a phone like this. They actually made a tiny miniature duplexer, which ended up working.
So, the idea that you could build a cell phone at that time was an incredible achievement. To do it in three months, which is the amount of time that we gave our team, that was an absolutely incredible achievement. The guy who ran the program that actually constructed the phone was Don


PROCEEDINGS • SPRING 2023 WWW.RADIOCLUBOFAMERICA.ORG 46
Dr. Marty Cooper showing an original model of the original DynaTAC mobile phone during the interview.
Rosetta Books, New York, 2020, ISBN 978-1-9481-2274-0.
Retractable design concept produced by Rudy Krolopp’s team for the Motorola DynaTAC, 1972. This design was not selected for the DynaTAC; but the idea of a retractable cover was tried in several other products besides phones that were made by different manufacturers. Ultimately, flip covers were often preferred, as shown in handheld calculator covers, digital address books, and other phones.



“Banana” design concept produced by Rudy Krolopp’s team for the Motorola DynaTAC, 1972. Although this design was not selected for the DynaTAC, notice how it incorporated a retractable antenna, an idea from commercial radio. It almost looks like a Korean War era U.S. Army Handy-Talkie, a curved descendant of the boxier Motorola SCR-536 made famous in World War II.

Flip mouthpiece design concept produced by Rudy Krolopp’s team for the Motorola DynaTAC, 1972. Although this design was not selected for the DynaTAC, notice how forward looking it is with the flip phone idea. This phone design concept would reappear in later years from several manufacturers.
Linder. When I approached Don to do this, he said, “I don’t think that’s possible. I don’t think it can be done. I’ll try.” I gave him a big hug and said, “Don, I know you can do it.” I guess he did.
[JOHN] Well, that’s fantastic. By the way, I’ll just add to what you said, Marty, that in my experience at Motorola, a new product took one to two years to develop. So, that gives the audience some feel for the three months you had versus the 24 months that was the norm. Since that time, what are some of the most important changes in wireless communications since you walked across Sixth Avenue? Can you summarize those?
[MARTY] Well, of course, the biggest thing that happened, as you know, not many people believed me when I told them that someday everybody would have a cell phone. We’re almost there, John, more than half the people in the world, maybe almost two-thirds of the people of the world, use cell phones. The number of subscriptions of cell
Double flip design concept produced by Rudy Krolopp’s team for the Motorola DynaTAC, 1972. Although this design was not selected for the DynaTAC, notice how forward looking it is. It contains several concepts that would reappear in later years from several manufacturers with its embedded keyboard, digital screen, and flip phone approach.
phones is more than the population of Earth. I don’t think there’s ever been an invention that has achieved that kind of penetration in such a short time.
We in the U.S. don’t really use the phones in as important ways as happens in the undeveloped countries. There are people on Earth who are sustaining themselves only because of the cell phone. A billion people have moved out of severe poverty. They’re so poor, but they’ve moved out of severe poverty over the last 20 to 25 years largely because cell phones been available to them. The impact of the cell phone in that regard has been quite remarkable, but as I mentioned before, we’re just beginning to see the impact of the cell phone. The future is going to be unbelievable.
Let me let me just reflect on what I think is going to happen during the next 20 years in the cell phone revolution. There are three areas that I’ve been focused on, because they are mostly of interest to me.
PROCEEDINGS • SPRING 2023 WWW.RADIOCLUBOFAMERICA.ORG 47
First is education. Our educational system for the most part is way behind. We’re just starting to catch up. Imagine a teacher now lecturing the students, each of whom has access to all the knowledge of the world because they have a cell phone. A cell phone reaches out to the internet, so having a teacher give information to a student no longer has any significance. Dave and John, I know you’re both conversant with what’s going on with artificial intelligence and now with chat GTP. Not only can the cell phone access information, but you can actually write an essay for your teacher without ever creating anything. So, the whole concept of education and of teaching is going to change. It’s going to change for the better. Our students will need to understand how to discriminate between useful information or fake information. They will learn how to use artificial intelligence as an aid, but they will still have to do the creativity part. There’s no doubt in my mind that our children are going to be smarter than we are, and their children are going to be even smarter than that, and boy could we use that intelligence. If you look at the problems of the world today, the fact that we have poverty at all, and the fact that there are wars where people are being killed for no reason at all; somehow, we ought to have the intelligence to solve those problems, and I am convinced that will happen.
The second area that I think is extraordinarily important is in healthcare. You know we have a concept called the annual examination. I’ll bet both of you have an annual examination, don’t you David? They are absolutely worthless. Why are they worthless? Because the disease is still awake in you until you have the examination. You have it at whatever random time it occurs. Here you have this cell phone that has now become really an extension of your personality. You carry it with you all the time. You have apps on it that reflect what you need in the world. Why not have that cell phone monitor your physical attributes all the time? Why not have a physical examination every 30 seconds, so that if you have a heart attack coming-on, you will know about that before it happens? You will anticipate it. You will pop a pill or call the doctor and find out what to do. You will avoid a full heart attack. That concept
will ultimately apply to every disease. There is no reason why we can’t have a sensor on our body that’s looking for cancer cells. If you think about it, all of us, every single person, has cancer cells in their body, but your immune system takes care of those things. The only time you have the disease of cancer is when your immune system loses control. Why can’t we have a sensor that anticipates that loss of control? When that happens, we can go to see a doctor, this doctor of the future, and immediately zap our out-of-control cancer cells. I see a future that is going to take a few generations to develop, but there is a future where there is no disease. The thing that drives that future of no disease is the ability to connect people.
So, you end up with what is really the most important contribution of the cell phone to humanity; that is, the ability to collaborate and the ability for people to talk to each other to resolve conflicts and to create.
Just think about the idea of creation. I think about Albert Einstein coming up with the idea of Relativity. It’s undeveloped, but he writes it all down and it sends a copy of this to his buddy Niels Bohr. Of course, the mail takes two weeks at that time. Niels Bohr then spends a month or two thinking about it, and then he writes a letter back to Albert Einstein with some suggestions about how to improve it. Well, just think about what happens today. We pick up our cell phone. I call up David and say “Dave, I got this great idea, what do you think about it.” He says, “Well, it’s not a bad idea, but you haven’t thought of so-and-so.” The whole concept of collaboration is going to change. We are going to see, and we have already started to see, an acceleration in our ability to create new technology, and that the world is changing by the day. For the most part, it’s changing for the better; and it’s not going to stop, it’s actually accelerating.
[DAVID] All of this was really made possible because you pulled the phone away from the wall. You changed the paradigm. The existing paradigm was that the phone called you at a place, and the phone was in a geographic spot. The phone exchanges were set up by geographic location. Today, you’re anywhere. The power of that can be seen in your comments of how the third world has really developed independent of the old landline networks. They have moved right into a modern, cellular, wireless environment.
[MARTY] That’s right Dave. Most of the people in the world have actually bypassed the wired phone and are using cell phones. I ought to add to what you’re saying. The whole concept of what a phone call is has changed. Just think about it. In the old days with a wired phone, when you made a phone call, you were calling a place. Today, when you make a phone call, you expect a person to answer right away. That’s a profound difference.
[JOHN] Absolutely. So, Marty, just changing direction a wee bit. In your view, were there any surprises, particular successes, or disappointments during the development of the cell phone from the beginning, and in the past 50 years?

PROCEEDINGS • SPRING 2023 WWW.RADIOCLUBOFAMERICA.ORG 48
Marty Cooper discussing the 900 MHz antenna used on the DynaTAC phone.
[MARTY] Well, I get surprised all the time, but one of the things I am surprised about is the dumb things that we do. We make a cell phone with an interface. One of the dumb things is that we have been overtaken by the technologies. Consider the extent to which we have forgotten that the purpose of a cell phone is to make people’s lives more convenient, easier. Here I have my cell phone, which is a block of flat plastic. I put it up to my round head. I have applications. They say the applications are going to customize this phone to me. All I have to do to customize this phone is to sort out among two million apps which ones are going to suit me. That doesn’t make any sense at all to me.
I have a vision of what the cell phone of the future ought to look like. It is kind of ridiculous calling this a phone in the first place. The phone is one of the minor capabilities of this device. The phone of the future will incorporate artificial intelligence, and that artificial intelligence will be yours. It will be Dave’s and John’s and not something that some engineer in a laboratory figured out. The artificial intelligence will understand your needs. When you need to do something, the phone will either create an app to do that, or it will search out and find the correct app; and, you won’t even have to think about it. To me, that is a real device that serves humanity.
So, one of the things that has become obvious to me is that technology is the application of science to create products and services that make people’s lives better. Sometimes, we technologists lose sight of that, because so we are so entranced by the gadgetry, the ability to put a supercomputer into a cell phone. We forget what the purpose of this phone is to make people’s lives better. So, I’m hoping that in the next generation in the future, the next 50 years, we will embrace that idea and work very hard to make people’s lives better and to enhance their lives while making them happier, to make them more productive. I think that the process has already started. It’s going to accelerate in the coming years.
[JOHN] That makes perfect sense Marty. So, knowing what you know now and how things did develop, is there anything you would have done differently in developing and working with wireless devices and systems?
[MARTY] Well, that brings up a whole new subject, John. I appreciate your asking that. You know one of the important things in my career working in the two-way radio business was the spectrum. There is a myth that there is a limited amount of spectrum. I don’t believe that. I have in fact incorporated that into a what I call the Law of Spectral Capacity which says that the capacity, the ability to put information through all of the useful radio spectrum, has doubled every 30 months for the past 120 years since Marconi first commercialized radio. If you are quick in mathematics, you can figure out that from Marconi’s time to ours that is 10 trillion times increase in capacity.
We know enough about technology today to know that we can do this for at least another 50 years, and you know that we are going to come up with new technologies in the next

50 years and keep expanding that capacity. We are going to have to do that, because the number of applications and the amount of bandwidth that is required to do these things that I talked about before, to eliminate disease or to modernize education, are going to require huge amounts of bandwidth. We are going to be looking at 3D pictures, we are going to be looking at x-rays; so, the amount of bandwidth is going to have to keep increasing.
The tools to do that will improve. As an example, we have already talked about the issue of expanding the radio spectrum where people are now talking about terahertz; but we haven’t even started to use these tools at the lower frequencies. One example of that is smart antennas; with smart antennas we could multiply the capacity of any specific frequency band. Today, with the technology we already have, we could achieve 10 or 20 times more capacity in the future, or much more than that; and yet, our carriers are not focused on doing that, on expanding the capacity of the lower frequencies. They’re into a new thing called millimeter waves; yet, they’re not satisfied with millimeter waves as they’re now going up to terahertz frequencies.
Well, if you think about it, the range of a terahertz base station is a couple of feet, but that that doesn’t occur to me as being very useful except for the Internet of Things. My view is: yes, the Internet of Things is important, because the ability of cell phone technology to run factories and to manage electrical networks is greatly important for the future; but shouldn’t we, while we’re working on the Internet of Things, shouldn’t we be working on the “Internet of People”? We are not doing that. Half the people in the world today do not have access to the internet for education. That is either because they can’t afford it, or because there’s no coverage. Shouldn’t we be putting as much effort into the cost of coverage as we are in putting up millimeter wave base stations? I hope I haven’t gone too far away from your question John, but I think we are not prioritizing the things that are people oriented, and I hope that changes in the future.
PROCEEDINGS • SPRING 2023 WWW.RADIOCLUBOFAMERICA.ORG 49
Dr. Marty Cooper talking about the modern cell phone and its applications.
The “shoe” or “boot” phone design produced by Ken Larson, which became the selected prototype for the Motorola DynaTAC, 1972. This design was selected for the DynaTAC because of numerous technical requirements that needed to be satisfied. These stemmed from a detachable recharging battery, full sized keyboard, space for the duplexer, room for the remaining circuitry, and the mounting for the fixed antenna.

[JOHN] I think that’s a very astute observation Marty, and I think you just in this moment coined a new term, the Internet of People, so let everybody remember it from this conversation, because it’s a very interesting idea, and I’m thinking about it.
So, talking about people, some critics, not all by any means but a few critics, have said that the cell phone has disrupted the attention span of workers and students, and it also enabled a lot of misinformation via social media. What do you think?
[MARTY] Of course, you know that any new technology carries with it dangerous concerns. So, let’s focus on addictions and think about what happened when TV came in. Do you remember that, John? You know people whose kids became locked onto their television, and parents said that the kids do nothing but watch television all the time. I hope you notice that we survived, and that we learned how to manage that. We learned how to get our kids to do their homework and watch television at the same time.
I think the same thing is true with the cell phone. We are going through some difficult periods now. You know the cell phone has been used for positive things, like solving serious crimes as a matter of fact; but also, some negative things, and I think it has also been used for pornography. Well, somehow, I just have a deep feeling for humanity, that humanity gets over these problems. We survive these problems. We figure out how to handle them, and somehow or other, we are going to have to work on them. We are still in the early stages. It’s only been 50 years. As I keep repeating, this is only a beginning, and we are going to solve those problems. We are going to solve the addiction problem, and we are going to solve the spectrum problem. We are going to somehow or other come up with a way of providing a separate internet for our children for education that doesn’t expose them to pornography or other bad things, one that focuses on education. Don’t you think education is as important as everything else? Believe it or not, there is a separate internet for medicine, they call it Nexus, that is focused on medical advances of medical technology. Why not have an internet for youngsters? You
know, I can imagine that you might have a totally separate internet for elementary school, another one for high school, and another one for the rest of us. There is just so much that can be done to solve these problems that people are concerned about, addiction or fake news. They are problems that have to be solved, but they’re solvable.
[DAVID] You paint a very positive and hopeful view of the future, and some of the challenges you have identified are probably more societal, behavioral, or political; but what do you think some of the challenges are on the technology side that need to be overcome in realizing the broader application of wireless technology for the benefit of all?
[MARTY] Well, I could talk about some of the minor problems that I think already have solutions. We are aware, for example, that you have to keep charging this phone every day, and you can talk a lot of people right out of charge. Yet, think about what the human body is. We are a charger. We ingest food, and we convert that food to energy. Isn’t that what a charging system does? I think that what we call a cell phone today, ultimately, is going to be part of us. I mean, it’s already a part of us. It’s going to be embedded under our skin. Why not use the human body as the charging station, as the energy source for your so-called cell phone.
You know, you guys are convincing me that we need a new name for this device. I haven’t figured it out yet. In the world today, we call it a cell phone. More accurately in a number of countries, they call it a mobile phone. In other countries they have different names for it. So, I hope we come up with a more reflective name.
The reason we call this a cell phone, by the way, is that Bell Labs originally came up with the idea. As wonderful as Bell Labs were, they were a bunch of techies. I think a marketing guy would have come up with a better name for a cell phone.
[DAVID] We were talking about some of the challenges, maybe on the technology side, that need to be overcome to expand the functionality of the device in whatever form that future device may be in. What are your thoughts?
[MARTY] Absolutely, David. Well, I have already addressed the issue of the need for having an artificial intelligence in the cell phone that optimizes the cell phone for you. You are the person that uses the cell phone, it is an extension

PROCEEDINGS • SPRING 2023 WWW.RADIOCLUBOFAMERICA.ORG 50
Marty Cooper: What should we call these devices in the future?
of your personality, not the personality of the guy that designed the cell phone.
In the medical field, in order to conquer disease, we are going to have to come up with all kinds of sensors, and these sensors will have to be put in your body based upon your DNA, reflecting your susceptibility to specific diseases. That concept, the idea of having sensors that anticipate disease rather than waiting for you to get sick so we can cure the disease, those sensors are just in the primitive stages of development. Ultimately, they also have to be embedded in your body, and they have to be connected to some central server. That to me is what the cell phone of the future is going to look like. Everybody is going to carry a server on them that connects to the rest of the world; and on their body, they will have various devices. I think ultimately these devices are all going to be embedded, and that they will customize their function and optimize their function.
I want to describe to you the optimum telephone. We still do use the telephone, don’t we? The optimum telephone, I think, is going to start out being like an earring, or something in your ear; but ultimately it will be embedded under your skin near your ear, because we want the ability to have this phone both hear what you’re saying and to have you hear with comes out of the phone. This device under your skin will have a supercomputer in it, and if I want to talk to Dave, I will say “Get me Dave” on the phone. It will say, “Which Dave do you want? Your cousin Dave in Pittsburgh or Dave Bart from the RCA?” Dave Bart of course. The next thing you know, I’m talking to you. To me, that is the telephone of the future. It is an optimized telephone. All of the other functions of the phone, sooner or later, will be optimized. So, instead of looking at this tiny screen, we will have glasses.
I suppose it’s going to sound like I’m trying to turn us into Borgs [referring to the cyborgs from Star Trek], but why not replace the lenses in your eyes with electronic lenses? Why not let us do virtual reality while we’re still living in the real world? All of those things are going to take generations to happen, but they are going to happen unless we get out of control and blow ourselves up. But as you said Dave, I’m an optimist.
[DAVID] This has been a wonderful celebration of the past and a view of the future. John, do you have any thoughts or comments as we wrap up?
[JOHN] No, I always enjoy listening to Marty, because he is, if anything, a futurist, and he sees far into the distant future and imagines things like the Internet of People that I would not have thought of.
[DAVID] Marty, as we head to the end here and celebrate your anniversary, do you have any closing thoughts of your own?
[MARTY] I do have a closing thought, Dave. I think the biggest thing that the cell phone epitomizes is what can be achieved through opportunity. You know, I have just been so lucky in my life, that I just happen to be in the right place

at the right time. I am not exceptional in any way. I just happen to be in the right place with some ideas. I had an environment and I had colleagues who were incredible. The management of Motorola were amazing to take a wild man like me and let me execute ideas that nobody else thought were useful.
What the cell phone epitomizes to me is the future of opportunity. There is no reason now why all of our children can’t have the opportunity to create and to make the world better, whether they are engineers or humanists, or whatever they do. I think we have the potential of making a much better world with no disease, no warfare, smarter people, no poverty; and this is the future that I look for.
I am so proud that I made a very tiny contribution to that future, and I am very proud of you, Dave and John, for giving me the opportunity to appear here today. Thank you very much.
[DAVID] Well, Marty, it is our distinct pleasure to celebrate the 50th anniversary of the first public demonstration of a handheld mobile phone call with you. Congratulations to you and to everyone who contributed to that wonderful demonstration of a new invention that changed humanity in 1973.
That’s it for us from the Radio Club of America. We hope you have enjoyed this discussion with Dr. Marty Cooper, and we wish everyone all the best.
ABOUT THE PARTICIPANTS
Dr. Marty Cooper is an engineer, inventor, and entrepreneur. He spent nearly three decades at Motorola and contributed to the development of pagers, twoway radio dispatch systems, quartz crystal manufacture, and more. He is a Director Emeritus and received numerous recognitions from the Radio Club of America, including Honorary Membership, Fellow, the Fred Link Award, and the Lifetime Achievement Award. He is a recipient of the Marconi Prize and many other awards.
David Bart is the current President of the Radio Club of America, Editor of the RCA Proceedings, and an RCA Fellow. He is also the Treasurer of the IEEE History Committee and a Director and Fellow of the Antique Wireless Association. He has received numerous awards for his work involving the history of communications.

John Facella is President Emeritus of the Radio Club of America and an RCA Fellow. He worked at Motorola, Harris, and a major consulting company for over 30 years and has presented or written numerous wireless articles. He has been the CEO of several high-tech startup companies and is a licensed professional engineer.

PROCEEDINGS • SPRING 2023 WWW.RADIOCLUBOFAMERICA.ORG 51
AN ESSAY CONSIDERING PARADIGMS, CELL PHONES, AND THE CONTRIBUTIONS OF RCA MEMBERS TO THE WORLD
By David Bart
The Merriam Webster dictionary defines a “paradigm shift” as “an important change that happens when the usual way of thinking about or doing something is replaced by a new and different way.” The Cambridge dictionary defines “paradigm shift” as “a time when the usual and accepted way of doing or thinking about something changes completely.”1
These definitions explain the importance of Dr. Martin Cooper’s 1973 public demonstration of a handheld mobile telephone. Notice the words: public, demonstration, handheld, mobile, telephone. Those words describe the device and the event that changed the world in 1973 in a historic walk on Sixth Avenue in Manhattan. Thereafter, humanity entered a new paradigm for the way it thought about and used telephonic communications – one where the individual was free to be anywhere.
TELEPHONES AND RADIOS ARE DIFFERENT
Dr. Cooper stood on the shoulders of giants.2 Numerous societal changes have been brought by new communications technologies that changed the world.3 The invention of the telegraph stemmed from many innovations and adaptations dating to the early 19th century, including Samuel Morse’s efforts that were famously demonstrated in 1844. Efficient electrical communication at a distance was born. The invention of the telephone is attributed to several individuals in the late 19th century, including Alexander Graham Bell in 1876. People could now talk across long distances. Wireless telegraphy is the product of many famous people, of whom Guglielmo Marconi is only one contributor.
Communication became far reaching, mobile, and more rapid. The wireless transmission and reception of voice, more commonly known as radio, is also the product of many people and numerous advances in technology, including those of Edwin H. Armstrong at Columbia University. Distance was again compressed, and one person could now “broadcast” to many. Wireless mobile radio emerged in the 1940s, primarily installed in automobiles, rendering even more flexibility in radio applications.4 Walkie talkies and other mobile radio devices advanced during World War II and further
developed in subsequent years, becoming smaller and more versatile.5 Those advances built on earlier developments in wireless telegraphy and mobile radio communication from trains and ships.6 The evolution of wired and wireless communication proceeded over many years.
All of these devices either involved physical ties (e.g., landline wires such as telegraph and telephone wires) that tethered a person to a physical place, or used radio (e.g., direct connection by radio waves from one spot to another in a talk/listen/talk mode that was manually operated in a push-to-talk circuit). The question was when and how electrical communication could follow the person. Incredibly, early 20th century commentators and futurists did contemplate this question. For example, H. G. Wells predicted a future with wireless communication, commingling concepts of email and voicemail, but these were still tied to a wireless station.7 Cartoonists also anticipated some of the dilemmas that might occur in a wireless future.
Personal radio communication began with “MTS” car telephone service from Bell in 1946.8 The equipment was large and bulky; it was ‘push to talk and release to listen.’ In order to connect to worldwide telephone networks, you had to use an operator. Ordinary citizens became enamored of using radios because of the “CB” craze of the 1970s, but they remained separate from the telephone networks, and were also ‘push to talk’. By the 1970s, a more advanced car telephone system called “IMTS” was introduced, which allowed the user to dial calls without an operator, and the circuit was “full duplex” (talk and listen at the same time). But again, the equipment was still bulky.
In contrast, the mobile telephone relied upon a new system where customers could dial a call for themselves, eliminating the operator, and eliminating the need for pushto-talk operation.9
A NEW PARADIGM: MOBILITY AND HANDHELD COMMUNICATION
By 1973, the time was ripe for a mobile, handheld telephone that could connect to the existing global
PROCEEDINGS • SPRING 2023 WWW.RADIOCLUBOFAMERICA.ORG 52
FEATURE
PROCEEDINGS • SPRING 2023 WWW.RADIOCLUBOFAMERICA.ORG 53 Contact Amy Beckham or Karen Clark Amy Beckham amy@radioclubofamerica.org Karen Clark kjclark33@comcast.net. Individual & Business Contributions Life Memberships Tom Sorley Fund Donations Corporate Contributions Endowments Corporate “One-Touch” Sponsorships Sponsorship Contributions Membership Dues Promotional Sponsorships - Support RCANow and into the future!
telephone landline and overseas relay networks. A full network focused on mobile phones took another ten years to develop and required plenty of convincing at both American Telephone and Telegraph (AT&T) and the Federal Communications Commission (FCC). The initial invention and demonstration of the DynaTAC spurred industry excitement and motivated further development and construction of mobile networks, so that they could be built (with the commitment of effort and cost) to support a handheld phone, as opposed to one transported in a car. Those expanding mobile networks utilized both installed landlines and wireless microwave radio links at fixed locations to transmit and receive signals.
The DynaTAC showed that the advances necessary to make a new type of telephone feasible could be embedded in a new portable device that could change the world; one that focused on combining the concepts and technologies needed for: handheld, portable, lightweight, mobile, telephone, communication.10 The U.S. patent office agreed, and Dr. Cooper and Motorola were granted a patent for the new ideas that were embodied in their new mobile telephone system.11 Another decade and additional work finally brought these new products into the marketplace by 1983.12 The FCC announced that it would authorize frequency allocation and would award two commercial licenses for cellular service in October 1981.13 Illinois Bell, a subsidiary of AT&T, launched the first modern cellular system in Chicago in October 1983. A Motoroladesigned system launched in December 1983 in the
Washington and Baltimore area, and Motorola launched the DynaTAC 8000x that year.14 The original foundation for the FCC’s commercial wireless allocation set the stage for evolving governmental standards and a changing competitive landscape that defined and continues to define mobile telephone service.15
Many well-established institutions have since agreed on the importance and the merit of the initial accomplishment in 1973, awarding Dr. Cooper numerous international recognitions and medals for his innovation and achievement as well as his subsequent contributions to wireless communication.16
Before 1973, people were tied to a place for electronic communication – by wire or at radio installations. For example, telephone exchanges and phone numbers were historically identified by geographic location. In the Lucile Ball television shows, Lucy and Ricky Riccardo’s phone number of Murry Hill 5-9975, or MU5-9975, was a standard format (2 letters, 5 numbers) that identified the Murry Hill exchange (an area on the east side of Manhattan in New York City) for a home telephone 685-9975.17

After 1973, the device could follow the person. The importance of this shift in the location of telephonic communications and the way they were conducted was recognized and intended by Dr. Cooper and Motorola. The feasibility of the new device was demonstrated to the general public while walking on a street in the middle of the country’s largest city.18 This was not an experiment in a laboratory, it was a public demonstration of a working device that was feasible to produce. The device was small, practical, and easy to use, and it was untethered from any fixed location or larger installation.
Did the 1973 public demonstration itself affect anything? Not likely, according to Dr. Cooper and the person who received the first call, Joel Engel at AT&T.19 Nevertheless, it is a marker in time, after which things changed forever. It marked the practical reality that it was now feasible to forever change the direction of wireless communication, shifting it toward a mobile and easily accessible one.
PROCEEDINGS • SPRING 2023 WWW.RADIOCLUBOFAMERICA.ORG 54
A 1906 Punch magazine cartoonist, Lewis Baumer, imagined a wireless future where people interact only through their devices, ignoring the humans sitting beside them. (If only Baumer could see some of today’s teenagers.)
IMPACT OF THE NEW PARADIGM
The mobile telephone and the development of cell phone technology permitted the phone number to now follow the person, regardless of the person’s physical location. This is the paradigm shift. People were now free to roam while they stayed connected to a global telecommunications network. The importance of this societal change is widely recognized.20 “This year [1973] marked the origin … Cooper is believed to be the inventor of this mobile phone for use in a non-vehicle setting … Cooper and Mitchell together pushed Motorola to develop wireless communication products that would be small enough to be used in an open environment.”21 Dr. Cooper’s “phone call showed the inception of mobile media, as inventors were certain that information could be passed from one person to another in a free environment using a mobile phone.”22 Advances in mobile communication technology have moved far beyond Dr. Coopers’ 1973 demonstration. Mobile, cellular, and digital technologies have spawned an amazing array of almost unlimited new mobile applications.23 Today, more than 6 billion people worldwide use mobile phones, “making it the most common and rapidly adopted communication in history.”24 “At the opening of the twentiethfirst (sic) century, the fixed telephone has been officially eclipsed – by its mobile counterpart.”25
THE RADIO CLUB OF AMERICA AND PARADIGM SHIFTS

Dr. Cooper’s contribution is one of many that have been made by members of RCA. From the beginning in 1909, RCA’s members have led or contributed to significant paradigm changes in the world of wireless as shown in the following table. These are only just a few areas. RCA has contributed to diverse technical accomplishments in many aspects of wireless, but our focus here in this essay is on fundamental paradigm shifts in the way people think about and interact with their world, how they think about their own identities, and how they function together or apart. These shifts are affecting the fundamental definition of who we are as humans and how we reach and interact with each other. They also affect how we use wireless for basic human needs. For example, wireless medical alarms are now common, e.g., patients with heart conditions can now be monitored 24 x7, and seniors on their own can have more confidence with an alarm necklace in case they fall.
The following table highlights some of the key paradigm shifts in wireless communication in which RCA members played a leading role or participated in some significant ways. The accomplishments span the 110 years of RCA, and a century of wireless development.
FUTURE PARADIGM SHIFTS
The 50th anniversary of Dr. Marty Cooper’s walk across Sixth Avenue should be considered one of those moments in history where people became truly able to wander and explore, free from any tether to a place. This is what makes it a truly momentous accomplishment. The communications paradigm moved from communications to a place, but not necessarily with the right person immediately, to communicating with a person who was immediately answering, and who could now be located in any place.
PROCEEDINGS • SPRING 2023 WWW.RADIOCLUBOFAMERICA.ORG 55
Consider this prescient and early cartoon from the Daily Mirror (U.K., Jan. 23, 1923), nearly 50 years ahead of Dr. Marty Cooper’s demonstration on Sixth Avenue.

We get it right the first time. Experienced | Thorough | Reliable AFC is a team of experts that will help you with every aspect of your FCC radio frequency coordination needs. The goal is to get you on track and on budget. What can AFC do for you? • Licensing • License Management • Frequency Coordination • Engineering Services Why AFC? • Comprehensive Services • Experienced Professionals • A ordable Costs • Timely Response Now that’s a wise choice! Find out more at apcointl.org/afc or contact afc@apcointl.org. AFC is a division of APCO International—a non-profit organization dedicated to serving those in emergency communications.
We’re AFC, Your FCC Coordination Expert
SAMPLE RCA CONTRIBUTIONS TO SOCIETAL PARADIGM SHIFTS
Period Sample Accomplishments
Founding of RCA
1909-1910
1912 to 1930s
WWI
1920s & 1930s
• Youth leadership (W.E.D. Stokes et al)
• Female inventor leadership (Lillian Todd)
• Congressional testimony about wireless laws by youth (W.E.D. Stokes et al)
• Wireless on ships and planes
• Circuitry for wireless radio development
• AM radio
• Transatlantic communication
• FM radio
• Shortwave radio
• Broadcasting networks develop
Paradigm Change
• Female leadership before the 19th amendment (1920)
• Female scientific and industry leadership
• Testimony by U.S. youth in a legislative hearing
• Radios improve safety and response times, benefitting passengers and crews and increasing public confidence in transportation
• Wireless communication is possible on a larger scale, permitting communication at a distance separated from landlines
• Two-way radio separates more and more people from landline communications
• Broadcasting – from one to many – opens communication but also risks the control of ideas and misinformation
• New means of transmission lay many foundations for a range of technical advances and new concepts of ways to overcome distance
• Networks provide more entertainment and news choices, and some degree of personalization
1930 to 1980s
WWII
• Mobile two-way radio systems
• Radar
• Proximity fuse
• Walkie talkie
1939 to 1960s
• Electronic television
• Police, fire, EMS, businesses, railroads, etc. move away from wired telegraph and wired telephones to communicate in the field with central dispatchers, improving access, safety, and efficiency
• Advances in radar tracking sets the stage for ideas leading to autonomous vehicle management and control
• Proximity fuse sets the stage for remote detonation and control at a distance
• Portable communications on the battlefield provides a model for individual mobile communication
• Broadcasting of visual images into the home opens new ways to see the world, perspectives on viewing the world, and ideas about the individual – initially in black and white, but by the late 1960s in color
1960s and after
• Space vehicle communication
• Space research
1970s & 1980s
1980s
1990s
2012 & 2017
• Wireless telephony
• Cable television
• Fractal and other small antenna systems
• FirstNet
2010s
2020s
• Invisibility cloaking
• Broadband
• 4G and 5G
• Millimeter wave
• Space vehicle communication allows humans to reach farther into the universe and farther back in time with spacecraft, radio telescopes and arrays
• We are not alone (SETI)
• Mobile, accessible communication is available anywhere
• Elimination of control by big 3 networks and FCC opens the range of access to communicating ideas and viewpoints
• Size compression and increased capabilities enable ever more adaptive uses of fractal concepts, opening up new fields in wireless and other areas
• Development of one nationwide network, yields improved interoperability of public safety communication, better reliability, and provides data capabilities similar to those available to citizens and businesses
• Is anything really there, or is it hiding?
• Millimeter wave allows more connections and faster speeds in close areas such as stadiums, train stations, etc., further compressing time and space
• The mobile phone becomes a computer and a telephone with ever increasing speed, enabling human sensors, thousands of customized apps, early use with artificial intelligence, medical devices and other developments – leading to the cell phone becoming part of human identity.
PROCEEDINGS • SPRING 2023 WWW.RADIOCLUBOFAMERICA.ORG 57
Dr. Cooper noted in a recent interview (see RCA’s interview of Dr. Cooper in this issue of the Proceedings) that he foresees the communications paradigm shifting even further, toward an “Internet of People,” where the mobile device becomes an extension of numerous aspects of human identity and human existence. But that is another discussion, and perhaps more lines in the table will or should be added in future years. With any luck and a little good fortune, perhaps RCA and its members can make those contributions.26
ABOUT THE AUTHOR
David Bart is the current President of the Radio Club of America, Editor of the RCA Proceedings, and a Fellow. He has received numerous awards for his work involving the history of communications and is currently Treasurer of the IEEE History Committee and a Director and Fellow of the Antique Wireless Association. He is the National Director of Restructuring and Complex Litigation at Baker Tilly US LLP. He has an MBA (Finance and Accounting) and BA (Anthropology and Statistics) from the University of Chicago, and numerous professional certifications.
SOURCES
1 The concepts of a paradigm and a paradigm shift were used to explain the scientific progress and change in a highly influential book written by Thomas Kuhn: The Structure of Scientific Revolutions (1962). According to Kuhn, a paradigm shift occurs when the underlying assumptions and modes of normalcy are reexamined, and a new paradigm is established. When the new paradigm’s dominance is established, normality returns, and the focus becomes solving puzzles within the new paradigm. (Ch. IX and XII).
2 Many histories of radio, telegraph, and telephone are widely available. For example, see “A Short History of Radio With an Inside Focus on Mobile Radio,” Federal Communications Commission, Winter 2003-2004; J. Hardy, “The Complete History of Phones from the last 500 Years”, History Cooperative, Feb. 16, 2022.
3 See the following for a historical and societal discussion about the impact of new communication technologies: M. Mihalis, “Mobile Media as A Digital Communication Tool,” New Searches and Studies in Social and Humanities Sciences, April 2021, Ch. 3, p. 33-52.
4 D. Bliss, “The First Mobile Phone Call Was Made 75 Years Ago,” Smithsonian Magazine, June 16, 2021.
5 R. Brewster, “The SCR-536 Handie-Talkie Was the Modern Walkie-Talkie’s Finicky Ancestor,” IEEE Spectrum, Sep. 25, 2020.
6 Mihalis, 2021, p. 35.
7 See Men Like Gods (1923) and The Shape of Things to Come (1933).
8 Mobile telephone service from a car was available to the wealthy in some key cities like New York. It started in 1946. First it was MTS (manual) via an operator, and later it was dialed by the user, but both had access to the phone networks. See Geoff Fors website, Chapter 6, Motorola and GE Mobile Telephones 1970-1983, http://www.wb6nvh. com/MTSfiles/Carphone1.htm
9 Supra, Note 6.
10 M. Cooper, Cutting The Cord (New York: Rosetta Books, 2020), p. 116-117.
11 U.S. Patent No. 3,906,166.
12 “The Motorola DynaTAC 8000x Enables the First Commercial Analog Cellular Telephone Service,” History of Information Website, 10/13/1983 to 1984.
Andy Maxymillian, PMP Principal Consultant

Blue Wing Services

235 Summer Hill Drive
Gilbertsville, PA 19525
Telephone: (610) 473-2171
Mobile: (610) 316-2660
E-mail: andrew.maxymillian@bluewing.com
PROCEEDINGS • SPRING 2023 WWW.RADIOCLUBOFAMERICA.ORG 58
13 S. Hochheiser. Your Engineering Heritage: The Foundations of Mobile and Cellular Telephony, IEEE USA Insight, Aug. 1, 2012.
14 Ibid. See also Cooper, 2020, p. 135-139 and Wireless History Timeline, Wireless History Foundation website, https://wirelesshistoryfoundation.org/wireless-history-project/ wireless-history-timeline/.
15 See Single Network Future: Supplemental Coverage from Space, Space Innovation, Notice of Proposed Rulemaking, F.C.C. Notice of Proposed Rulemaking, DA/FCC #: FCC-2322, GN Docket No. 23-65, IB Docket No. 22-271 (released Mar. 17, 2023), Note 69: “The 800 MHz Cellular band was originally divided into two sets of two 10 megahertz blocks (Block A and Block B). An Inquiry Into the Use of the Bands 825-845 MHz and 870-890 MHz for Cellular Communications Systems; and Amendment of Parts 2 and 22 of the Commission’s Rules Relative to Cellular Communications Systems, CC Docket No. 79-318, Report and Order, 86 F.C.C.2d 469 (1981). Later, 10 more megahertz of spectrum was added and divided between Block A and Block B, with the bands being reconfigured to take advantage of this new spectrum. Amendment of Parts 2 and 22 of the Commission’s Rules Relative to Cellular Communications Systems et al., GEN Docket No. 84-1231 et al., Report and Order, 2 FCC Rcd 1825, 1828 at paras. 25-26 (1986).”
16 23 awards and recognitions are listed at: “Martin Cooper (inventor)”, Wikipedia.
17 M. Miller, “‘I Love Lucy’: The Story Behind the Ricardo’s Designated Phone Numbers and Why They Started with Letters,” Outsider, Mar. 18, 2021; Notes on Nationwide Dialing, AT&T Dept. of Operation and Engineering, 1955, Section I: p. 2-3, Section II: p. 2, 8-9.
18 Cooper, 2020, p. 118-125
19 Cooper, 2020, p. 139-140.
20 M. Mihalis, “Mobile Media as A Digital Communication Tool,” New Searches and Studies in Social and Humanities Sciences, April 2021, Ch. 3.
21 R. Wei. “Mobile media: Coming of age with a big splash,” Mobile Media & Communication, 2013, Vol 1 No. 1, p. 5056.
22 J. Farman, “Historicizing Mobile Media,” The Mobile Media Reader (New York: Peter Lang, 2015), p. 9-22.
23 H. K. Flora, X. Wang, S. V. Chande. “An Investigation of the Characteristics of Mobile Applications: A Survey Study,” I.J. Information Technology and Computer Science, 2014, Vol. 11, p. 21-27.
24 Ibid.
25 G. Goggin, Cell Phone Culture: mobile technology in everyday life (New York: Routledge, 2006), Ch. 1.
26 Thank you to John Facella for contributing his comments to the draft of this essay.

PROCEEDINGS • SPRING 2023 WWW.RADIOCLUBOFAMERICA.ORG 59
Save the Date! 2023 Technical Symposium and 114th Awards Banquet SATURDAY, NOVEMBER 18, 2023 | DENVER, COLORADO
ANDREW SEYBOLD, RECIPIENT OF THE 2023 IWCE CONNECTING CRITICAL COMMUNICATIONS AWARD, PASSES AWAY
By Andrew Seybold
EDITOR’S NOTE: It is with great sadness that we report the recent passing of longtime RCA Fellow and member Andrew Seybold on May 2. Andrew passed away at his home surrounded by his family. As we go to press, further information is not available yet. This news comes on the heels of Andy receiving the prestigious IWCE Critical Communications Award. The following articles discuss the award and contain brief biographical material about Andrew, who enjoyed notable roles in the wireless industry, within the public safety arena, within the cellular industry, and on the RCA board. During his career, Andy received many awards, including RCA’s Sarnoff Citation. Finally, Andy has continued to support the RCA Proceedings, and RCA has been publishing excerpts from Andy’s Public Safety Advocate newsletter. We have reprinted his last newsletter posting below. Further information and celebrations of Andy’s life will be forthcoming.
IWCE CONNECTING CRITICAL COMMUNICATIONS AWARD

Andrew received the 2023 IWCE award in April 2023 for his “outstanding vision, commitment and contributions to the critical communications industry.”
Andrew stated:
“I am deeply humbled to have been only the second person to receive this lifetime achievement award, especially since Chief Harlin McEwen (Ret.) was the first and there could be no one better to follow.
Since the day I was invited to join the group seeking spectrum from Washington DC for a nationwide public safety broadband network, FirstNet has become my life’s work and Band 14 has been its greatest reward.
I am thankful to IWCE’s dedicated staff, the Public Safety Broadband Technology Association (PSBTA), and Dick Mirgon, a founding member of the Public Safety Alliance
who has long served the wireless communications industry, for moderating the panel during which this award was presented.
Unfortunately, I was not able to be there, but I listened and was honored by the number of people who chose to attend this session. I thank everyone who has supported me over the years and I look forward to continuing with my life’s work of improving and expanding wireless communications for public safety.”
PUBLIC SAFETY NETWORKS PAST AND FUTURE
The public safety community has been using wireless communications (wireless, land mobile radio, and digital technologies) since the early 1930s. For most of that time, public safety was struggling to find enough radio spectrum to meet its needs across the US. Radio systems typically connected back to dispatch centers using analog telephone wires furnished by various telephone companies. This enabled voice transmission, and radio transmitters and receivers could be located on towers distant from dispatch centers.
LMR AND OTHER FORMS OF CONNECTIVITY
As two-way radio became Land Mobile Radio (LMR), new technologies including digital broadband were added, and the method for connecting dispatch to radio sites improved dramatically.
Today, many LMR systems are still providing primarily voice communications. This resulted in having to find new and better ways to connect LMR or broadband radio systems with increasingly more complex dispatch centers and radio systems.
Two-way communications improved over time and the number of technologies grew, resulting in a variety of ways to increase remote capabilities. Standard single pairs of wires that were run point-to-point, but not connected to a telephone, led to a more modern approach known as T1, point-to-point, or point to many-point systems. Though still based on copper wires, T1 provides improved access to and from a dispatch center or Emergency Communications
PROCEEDINGS • SPRING 2023 WWW.RADIOCLUBOFAMERICA.ORG 60
FEATURE
IWCE 2023 Connecting Critical Communications Award.
Center (ECC) and, theoretically, priority service with a dedicated connection to public safety service.
Typical copper connections enabled one dispatch console to use one remote base station over a single radio channel. As demand grew, multiple channels using a variety of signaling technologies were deployed over copper wire pairs to increase the number of channels that could be used over the pair. The first way to control a channel on one pair of copper wires was to reverse positive and negative voltages of the pair. Next came tones to change channels and provide other signaling functions. The tones were relayed to the base station to initiate a change from, for example, channel 1 to channel 2.
Today, public safety has more spectrum and capabilities than ever before. However, that does not mean it has all it will need now and into the future. LMR has been augmented with FirstNet and broadband. In some areas, Next Generation 9-1-1 (NG911) for incoming dispatch notifications has already been rolled out and hopefully will be built out for the entire US in the next few years. All of these networks are being connected. This will be much easier when they can be tied together using Internet Protocol (IP-based connectivity). We are currently using IPv4 but are on our way to IPv6, which will add more capabilities.
If the vendor and public safety communities can move toward implementing IP as a common connectivity technology, all of today’s networks and what may become available will provide more ways to use communications services.
As wireless technology continued to be upgraded, and users required more features and functions, vendors and phone companies continued to work with copper wires for point-to-point and point-to-multipoint systems. However, there were places where copper was not available. Commercial wireless solved this problem by installing analog and digital microwave point-to-point/ multipoint systems and public safety systems followed the model. The placement of radio towers and base stations in these systems resulted in larger coverage areas and more flexibility. Most analog LMR systems still in operation continue to use point-to-point copper or microwave for connectivity between the access point and the radio transmitter/receiver.

Telephone companies that had provided copper connectivity for many years have been moving away from copper and have upgraded their systems with fiber. In many parts of the US, it is no longer possible for a public safety agency to order installation of one or more types of copper connectivity.
New ways to provide connectivity without using direct point-to-point technologies had to be found. For analog systems, the primary choice today is to move from copper to Voice-over-IP (VoIP) services. VoIP connectivity is provided in a digital format that is converted back to standard analog signaling once it reaches the transmitter.
As back-end services have matured along with LMR and broadband technologies such as FirstNet, features and functions offered by new radio technologies including P25 conventional, P25 simulcast, P25 trunked, and Digital Mobile Radio have, for the most part, continued to use point-to-point connectivity.
PUBLIC SAFETY NETWORKS TODAY
Several areas still using analog technologies continue to be served by phone companies with one or another form of copper connectivity. However, while the Federal Communications Commission (FCC) has not set an end-oflife for copper connectivity, it is certainly open to existing wireline vendors to move fiber, satellite, and microwave connectivity options.
FIRSTNET AND INTERNET PROTOCOL
When the FirstNet Authority awarded the contract to build out a nationwide public safety broadband network to AT&T. At that time, LTE, or 5G were chosen for overthe-air connectivity. Internet Protocol has been used in the wireless community for many years as network

PROCEEDINGS • SPRING 2023 WWW.RADIOCLUBOFAMERICA.ORG 61
Andrew Seybold.
capabilities continued to be expanded and IP offered many advantages. Today, we use IPv4 but we are told the transition to IPv6 is well underway. The need to move is primarily because at some point we will run out of IP addresses and will be forced to move to IPv6.
IP ADVANTAGES
Using IP back-end connectivity makes a lot of sense. First, most IP systems use multiple connectivity points and redundant network cores (central brains of an IP system). Even so, many LMR systems are not using IP for their networks nor do most APCO P25 trunked systems. These usually have a single network core that feeds the entire trunked network.
UPCOMING NETWORK BACK-ENDS USING IP
As we draw closer to moving to digital, communications will be delivered via fiber or high-speed digital microwave. This will enable incoming calls to the dispatch center to include pictures, video, text, voice, push-to-talk and other features and functions. The reporting party will be able to give dispatch more information than with voice or text. Therefore, at some time after NG911 has been funded and is being rolled out, we will have two of the three types of public safety networks with IP back-end services.
The first, of course, is FirstNet (Built with AT&T), the public safety broadband network. Then NG911 will also be IP-based. These two networks will provide many ways to interface both incoming and dispatch calls. Thus, public safety will be able to provide more detailed incident information better and faster.
WHERE THAT LEAVES RADIO
Today’s LMR systems management needs to be looking ahead to when they will have no choice but to move to IP-based connectivity. As an increasing number of phone companies cease to offer copper-based services including analog copper (many have already begun), LMR will have to find alternatives. Some can be replaced with digital microwave and point-to-multipoint and some may be replaced with 5G. Moving from the copper world to the digital world will open access to benefits that will provide better and faster services for the public safety community.
IP FOR LAND MOBILE RADIO
As mentioned above, most of today’s newest types of land mobile radio including P25 trunked are not using an IP system for the back-end.
A few years ago, I was asked to write a white paper about Johnson’s (part of the Kenwood family of products) DallasFort Worth airport installation of a P25 trunked system. Instead of a single core or server, Johnson’s system uses multiple cores and servers at each cell site built out from
the network. The advantage to this, even back then, was that the cell site tower, server, radio equipment, and back-end of the system were 100-percent IP-based. The redundancy for the entire system was many times better, and cores at each location can greatly improve redundancy of the network.
Since that time, things have been quiet in the LMR backend arena with a few exceptions. Kenwood has convinced a number of agencies to install P25 trunked or simulcast systems, or both, with cores at every site. If you read the white paper, you will see that there are a number of ways this combination can be P25 trunked and cores at each camera location can greatly improve redundancy of the network.
Within the last few months, Kenwood started racking up wins using this technology. For example, Santa Barbara County, California, has awarded a contract to Kenwood to install a combination UHF 700-MHz simulcast trunked system based on Sheriff and other County services between UHF and 700-MHz systems depending on where the units are located. The idea is to deploy 700-MHz systems in metro areas within the UHF system covering suburban and rural areas. [An aside: This system will use ESChat PTT, the application the county has been using for a number of years.]
Delaware County, Pennsylvania Sylvania, was my home county and where I worked as a dispatcher in the County Police Department many years ago, also awarded a contract to Kenwood for its IP-based redundant P25 trunked phone network. And there are many others, including a YouTube film made in Australia about the advantages of this type of IP-back-end P25 trunked system (YouTube: Kenwood P25 Trunked Radio System).
I find it interesting that other vendors claim they can provide the same type of network connectivity by using a core at each camera location. However, so far, I have not seen any other vendor bidding on this type of network as their prime offering to an agency in the last year or so.
CONCLUSIONS
We are heading toward an all-IP world. FirstNet is already there, NG911 is on its way, and a number of LMR systems are moving toward an all-IP back-end that can provide higher levels of redundancy than those available today.
I will be watching how long it takes the vendor community and agencies running public safety communications systems that choose only IP-based back-end connectivity. If your LMR system is due for an upgrade, and your agency and/or local government understands that the best combination of communications services for your community is Next-Generation 9-1-1, FirstNet, and IP-based LMR, you might want to take a look at what Kenwood offers.
PROCEEDINGS • SPRING 2023 WWW.RADIOCLUBOFAMERICA.ORG 62
As we head into the future, it will become more of an IP world and there will be more ways to thread these networks together. The all-IP vision I wrote about a few years ago will be easier to achieve, as will the capability to deliver content and services. It will be interesting to see how many more IP-based LMR systems contracts are awarded to various vendors between now and the end of the year. My guess is that at year-end, the number of IP-based LMR systems will outpace all other options.


Reprinted from: Public Safety Advocate, March 12, 2023.

ABOUT THE AUTHOR
Andrew Seybold has been involved in Public Safety and Public Safety Communications for more than fifty years, starting as a first responder and then working with RCA Mobile Communications, General Electric Communications, Biocom (where he helped develop the first paramedic radio for sending voice and EKG from an incident to a hospital), and Motorola. In 1981, he began his career as a consultant, educator, and author. For the past ten years, Mr. Seybold has been volunteering his time and efforts to the Public Safety community in its quest to build a nationwide, interoperable broadband communications network, and has worked closely with the Public Safety Spectrum Trust, The Public Safety Alliance, the Major City Chiefs Association, APCO, The International Chiefs of Police, the National Sheriff’s Association, and other organizations. Mr. Seybold is a former board member and a Fellow of the Radio Club of America. He received RCA’s Sarnoff Award; APCO’s President’s Award and Special Partnership Recognition Award; National Public Safety Telecommunications Council (NPSTC) Special Recognition Award; National Sheriffs’ Association (NSA) Presidents Award; and the Public Safety Spectrum Trust (PSST) Commendation.

The Radio Club of America (RCA) and The Antique Wireless Association (AWA) have installed a display in the AWA Museum about RCA. In addition, RCA’s historical documents, publications, papers, pictures and more have been cataloged and filed in the AWA Museum’s archives. Many other displays at the AWA Museum feature RCA members and their innovations.
RCA’s archived historical material is available to the public. There is considerable additional RCA historical material in the possession of past RCA officers and members. We ask that you please donate these items to the RCA historical collection. This is your history, and we want to preserve it for future generations. Please contact the co-chairs of the RCA Historical Committee, Felicia and Jim Kreuzer, to donate RCA historical items to the RCA archives at the AWA museum. Contact Felicia at feliciaa.kreuzer@gmail.com and Jim@wireless@pce.net
PROCEEDINGS • SPRING 2023 WWW.RADIOCLUBOFAMERICA.ORG 63
RCA SEEKS YOUR HISTORICAL
CLUB OF AMERICA Join RCA at Dayton Hamvention! May 19–21, 2023 Green County Fairgrounds and Expo Center Dayton, OH visit https://hamvention.orgto register!
MATERIALS RADIO
RCA’S EXPANSIVE ONLINE RESOURCES
RADIO CLUB OF AMERICA
Do you know about RCA’s numerous online resources?
For more than a century, the Radio Club of America (RCA) has fostered wireless innovation by providing premier networking and education opportunities. RCA’s members are a premier group who built and are building the world of wireless communication. Our members leadership in the field of wireless communications encompasses professional, academic, entrepreneurial, and amateur individuals who are interested in the art and science of wireless communication.
Regardless of membership in any other local or national organization, RCA fosters innovation by bringing together a unique and high value group of talented and enthusiastic members from every segment of the wireless industry.

RCA PROVIDES A WIDE ARRAY OF ONLINE RESOURCES TO OUR MEMBERS
NETWORKING
• RCA Events – links to join us at RCA events, including laboratory visits, technical symposium, industry events at conferences, awards banquet
• Facebook, Twitter, LinkedIn – follow us on social networking sites

• Publications – follow RCA and contribute to RCA’s ENews, RCA Proceedings, and website
VIDEO ARCHIVES
• RCA’s Interview Series – nearly 50 online interviews of leaders in the industry share their perspectives
• RCA Video Archives – containing recordings of the Technical Symposium and annual awards
• RCA on YouTube – follow our YouTube page
CAREER DEVELOPMENT
• Mentorship Opportunities – Supporting professional growth and providing opportunities for those industry up-and-comers to meet with more experienced members to learn and grow their careers
• Young Professional Award Applications – to elevate individuals under age 35 for their innovation, leadership, and creativity in wireless communications

• Career Links - for job listings
RECOGNITION
• Experts and Legends – snapshot biographies of RCA’s legends who made and are making the modern world of wireless
• Award Applications – to elevate achievers, pioneers, game changers and inventors
PROGRAMS FOR WOMEN
• Women in Wireless – links, archives, recordings and resources highlighting the contributions, historical, and ongoing, of women to wireless communications

YOUTH PROGRAMS
• Youth Activities – special programs for middle and high school using wireless and amateur radio as a teaching and leadership development tool
• Scholarship Applications – for middle school, high school, college, and graduate school

TRAINING & EDUCATION
• Training – links to certification, training, and RCA introductory video resources
• Document Library – links to past issues of the RCA Proceedings, white papers, and other publications
Amy Beckham
Administrative Director
amy@radioclubofamerica.org
612.405.2012
www.radioclubofamerica.org
Facebook: facebook.com/RadioClubOfAmerica
Twitter: @RCA1909
YouTube: @radioclubofamerica7981
LinkedIn: www.linkedin.com/groups/844837
Radio Club of America brings together professionals and non-professionals from every segment of the wireless industry
CURRENT PERSPECTIVES: SILICON VALLEY DISPATCHES: HOUSING VS TELECOM
By David Witkowski
As you go through your day, you might notice that smartphones are very popular. When most people are not actively doing something, they have their heads down, staring at the magic black rectangles that power electronic dopamine pumps that we just cannot bring ourselves to put down. So, you might be surprised when I tell you that constructing, upgrading, and keeping the cellular sites that serve our precious devices is actually harder than ever, and an unforeseen intersection of economics and public policy makes it likely that we could soon see fewer of high-level macro cellular sites that serve as the backbone of our networks.
OPPOSITION GROUPS AND THEIR FAMILIARS
How is it possible that people can simultaneously crave wireless connectivity, and yet be opposed to cellular sites? This is a question I often ask myself. When I am speaking at community meetings, city councils, planning commissions, and other hearings, I always ask, “Okay, show of hands please… How many people here do not own a cellphone?” It has been years since anyone has raised their hand. They want their smartphones to work—they just do not want the cellular site located near their house. The majority of their concerns seem to be related to the health and safety of electromagnetic fields, followed by concerns about aesthetics and property devaluation. It is hard to do anything about aesthetics, although I am often impressed by how clever site developers have become at dreaming up creative camouflage strategies. Studies have shown that property values are not harmed in economically meaningful ways by nearby wireless sites. In fact, an academic study I conducted during 2021 in partnership with Ralph McLaughlin, a Ph.D. economist specializing in urban planning and real estate valuations, showed that good cellular coverage increases property valuations in economically depressed communities. Although there are many poor-quality studies that claim a variety of harmful effects from electromagnetic fields, decades of highquality medical and academic studies have failed to find evidence of harm caused by RF on humans or animals. None of this deters the scores of groups who have made opposing wireless sites and systems their raison d’être, and who, in turn, infect the uninformed with their

pseudoscience. It does not help that some popular actors and social media influencers adhere to these superstitions. During the early days of the global SARS-CoV-2 pandemic, a doctor in San Francisco (who later lost his medical license) was conducting talks where he suggested a link between cellular site emissions and COVID-19—he was the source of the “5G causes COVID” meme. Actors like Woody Harrelson and John Cusack, and musical stars like Madonna and rapper M.I.A. amplified this wacky theory, leading to several incidents of arson and vandalism at cellular sites around the world, and assaults on telecom crews struggling to sustain networks during the depths of the pandemic. Unfortunately, this vandalism deprived some people—trapped in their homes by pandemic lockdown orders—of a critical means of communication.
You would think that, given the critical role cellular networks played in connecting people during the pandemic, and the role they still play in our new hybrid reality, plus the realization that the anti-wireless activist community is led by people who are (as I like to say) “several fries short of a Happy Meal”, would all lead city councils, planning commissions, zoning boards, and other elected or appointed governing bodies to reject the ravings of the small yet vociferous foil-hatter community. Unfortunately, this is not the case. Some of the services my company provides are third-party reviews
PROCEEDINGS • SPRING 2023 WWW.RADIOCLUBOFAMERICA.ORG 65
FEATURE
Figure 1. The California Senate committee hearings for SB-649 were…entertaining. (Photo credit: David Witkowski)
of electromagnetic compliance reports and expert witness testimony at public hearings for cellular site applications. In my professional experience, the governing bodies tasked with reviewing applications from carriers and site developers have become even more prone to voting against siting applications. This does not bode well for the future of our nation’s cellular networks, which must expand to keep up with the exponential growth in global smartphone usage and other applications like the Internet of Things.
The U.S. Congress passed the Telecommunications Act in 1996, which set forth several elements intended to help the emerging cellular industry catch up to the U.K. and Europe, which by 1996 already had solid coverage for voice and SMS across most areas. One of these elements removed local government’s ability to reject applications for cellular sites on the basis of RF health concerns. If a site meets the FCC’s safety guidelines (a document that is based on the IEEE C95.1 standard) it is deemed safe, and a state or local jurisdiction cannot override that determination simply because they think the FCC should be more cautious. The TCA was challenged in the courts, and the courts overturned those challenges. And yet, 27 years later, local and state governments continue to assert control over cellular siting based on unfounded concerns about RF health effects. The city of Monterey, California recently enacted an ordinance that bans the placement of cellular sites within 150 feet of any residence. A state regulatory agency in New Hampshire enacted a policy banning cellular sites within 1,500 feet of any school. These regulations are not based in any engineering or physics, they are arbitrary distances created for a political purpose by the elected or appointed bodies by the same people who propagated the anti-science fiction that 5G

causes COVID-19. When confronted with the question of whether 150 feet is a safe distance from an RF source, engineers would ask questions about the site’s RF power, antenna gains and patterns, cable losses, height above ground, and nearby walkable surfaces. None of that matters to the City of Monterey and the State of New Hampshire. Their policies seem to be based on what amounts to numerology—distances that end in zero and are evenly divisible by 2, 3, and 5 are somehow good. I once proposed, jokingly, to a resident’s technology committee that they require the carrier to paint a pentagram on the ground around a tower to “constrain the RF evil.” One of the residents actually replied, “Do you think that could work?”
THE HOUSING CRISIS AND TELECOM
The challenges now facing U.S. cellular carriers, where the telecommunications industry exists in an almost entirely capitalist paradigm, cannot be overstated. Tower owners and site managers in the U.S. work constantly to secure and renew tower ground leases and to provide carriers the certainty they need to protect their network—as well as the investments made over years and decades on these networks. The rate paid for a site ground lease, signed in 1998 in the Northern California market, ranges from a low of approximately $700 per month, to a high of approximately $1,900 per month. In 1998, there were 69.2 million cellular phone subscriptions in the U.S., in 2021 there were 361.6 million. Private landowners who lease to tower owners and site managers understand the value of their land and have full access to information on the best uses of that land. They can review the quarterly earnings reports of the cellular carriers and tower management companies, and they can receive offers on a regular basis from telecom aggregators. Landowners who host cellular sites must also withstand constant pressure from the aforementioned opposition groups who are seeking to remove their towers based on the unfounded fears previously discussed. The net result is that, in 2023, the cost of telecom ground lease renewals is increasing by a factor of four or more. These increases in leasing costs are then passed onto the wireless carriers, who in turn pass them along to subscribers, meaning you and me. As tower owners and site managers work to renew expiring ground leases that were signed between 10 to 30 years ago, expiring ground leases will require renegotiation— and some sites may require relocation. This will change the coverage of our networks, and some people will lose coverage.
U.S. carriers are also encountering state-level legislation, intended to address the housing crisis, that unintentionally threatens the operation and expansion of cellular networks. For example, in California, the state legislature passed Senate Bill 6 and Assembly Bill 2011, bills that reduced the barriers for developers to convert commercial property into housing. These laws make sense, as internet-based shopping and home delivery continue to kill off brick-
PROCEEDINGS • SPRING 2023 WWW.RADIOCLUBOFAMERICA.ORG 66
Figure 2. The County of Santa Cruz, California feels it necessary to warn you that they use Wi-Fi inside the county’s buildings.
and-mortar retail, while cities struggle to find land for housing expansion. In 2015, 15 percent of malls were 10 to 40 percent vacant—up from 5 percent in 2006—and 3.4 percent of malls—representing more than 30 million square feet—were more than 40 percent empty. The real estate term for these properties is “ghost mall”, and these numbers were bad before the 2020 global pandemic. If predictions materialize for a recession starting in late 2023, these numbers will only get worse. So how does this relate to cellular networks?

Mall rooftops often host cellular sites. In the example shown in Figure 3, three cellular carriers use a mall in Capitola, California to serve customers in the nearby commercial zones and homes in surrounding communities. The mall has already lost Sears, a major anchor tenant, and will likely lose more in the coming recession. Housing activists have already called on the city to rezone the Sears
structure as a long-term homeless shelter. Faced with compliance to California’s new SB-9 law, which requires all cities to build a state-mandated amount of new housing or face loss of local zoning control, the City of Capitola might well decide that converting parts of a half-occupied mall into housing is politically easier than approving multi-story apartments and condos in their single-family neighborhoods. But what happens if the City of Capitola succumbs to pressure from wireless opposition activists, newly emboldened by their win in Monterey just across the bay? If Capitola enacts a 150-foot residential exclusion for cellular sites, it will be impossible for the carriers to renew their mall rooftop leases. The coverage provided by those sites to the surrounding commercial zones and neighborhoods will go away. Even though the carriers may not have the budget to build replacement sites, I suspect will the wireless opposition groups (and their familiars in local government) will not make it any easier for them to build.
So, enjoy the cellular coverage you have while you have it—it might be worse in a few years.

ABOUT THE AUTHOR
David Witkowski is an author, advisor, and strategist who works at the intersection between local government and the telecommunication industry. He is a Fellow of the Radio Club of America, an IEEE Senior Member, the Founder and CEO of Oku Solutions LLC, and is the Executive Director of Civic Technologies Initiatives at Joint Venture Silicon Valley. He served in the U.S. Coast Guard and earned his B.Sc. in Electrical Engineering from the University of California, Davis. He held leadership roles for companies ranging from Fortune 500 multi-nationals to early-stage startups, and currently serves as Co-Chair of the Deployment Working Group at IEEE Future Networks, as a member of the Connected Communities Forum at the Wireless Broadband Alliance, and as an Expert Advisor to the California Emerging Technology Fund. He is the author of several books and many articles about the state of the industry.

Explore the ‘World of Wireless’
There are many different interesting facets of the wireless communications world. RCA’s ‘World of Wireless’ web page has links to multiple places, ideas, articles, and videos that may be of interest to you. Links include: Hot Topics, Fascinating Information, Interesting Articles, Short Wave Listening, Wireless Museums and more! If you know of anything that could be included here, please contact us. Learn more at www.bit.ly/RCAWorldofWireless.
PROCEEDINGS • SPRING 2023 WWW.RADIOCLUBOFAMERICA.ORG 67
Figure 3. A mall in Capitola, California hosts antennas for three U.S. cellular carriers.
PAPER COPIES OF RADIO CLUB OF AMERICA TECHNICAL PROCEEDINGS –
FREE (while they last)
Just pay shipping - or to eliminate shipping charge, come to AWA in Bloomfield, NY and pick them up

PROCEEDINGS • SPRING 2023 WWW.RADIOCLUBOFAMERICA.ORG 68 Acoustics and Microphone Placement in Broadcast Studios Part I Dreher May 1928 Acoustics and Microphone Placement in Broadcast Studios Part II Dreher June 1928 THE A-B-Cs of Amplifier Circuits Crom Sept 1928 Measurements on Broadcast Receivers Hull Oct 1928 Measurement & Design of Audio Frequency Transformers Johnson Nov 1928 High Power Output Tube Weaver Dec 1928 Characteristics of Filament Type Rectifiers Wise Jan 1929 Servicing Radio Receivers Aceves Jun 1929 Characteristics of Audio Transformers Turner Sept 1929 Grid Suppressor Circuit Harris Oct 1929 Circuit Combinations that Provide Uniform Signal Selection Uehling Nov 1929 Screen-Grid Tubes for Audio Frequency Amplifiers Glauber Feb 1930 Pentode Tube Henney Mar 1930 Practical Television System Replogle May 1930 Equipotential Indirectly Heated Cathode for Receiver Tubes Allen July 1930 Adjustable Tone Compensation Improves Audio Amplifiers Aceves Sept 1930 Broadcast Program Protection Brown Oct 1930 Proving Lab for Radio Receivers Reinken Nov 1930 The “Stenode” Robinson Dec 1930 Multicoupler Antenna System for Apartment Buildings Amy April 1931 Design & Construction of Standard Signal Generators Franks May 1931 Design of a Complete Television System Huffman July 1931 Synchronization of Westinghouse Radio Stations WBZ & WBZA Gregory Aug 1931 Continuity Testing in Radio Service Work Rider Nov 1931 Auditorium Sound Adsorption Balance Schlenker Dec 1931 Portable Speech Input Eqpt for Remote Control Broadcasting Lyon July 1932 Voice Recording for Industrial & Social Uses White Sept 1932 Short-wave Transoceanic Telephone Receiving Eqpt Polkinghorn Nov 1932 Antenna Transmission Line Systems for Transmission Reception Brigham Jan 1933 Radio Servicing Instruments from Engineering Viewpoint Miller May 1933 Correlations on Class C Radio Amplifiers Davis Nov 1933 Photronic Cell & Control Pierce Jun 1934
Continued
page.
on next
for 500 MC Amplification
Print these 2 pages and mark the desired issues. Proceedings are free, but shipping charges are the responsibility of the recipient. Shipments to a US address are $1 (for the envelope) plus $1 per Proceeding for shipping. AWA’s mailing address for your order form and check is: AWA c/o RCA Proceedings, PO Box 421, Bloomfield, NY 14469 check should be made out to AWA. Please include your mailing address on the form. Proceedings will be mailed within 2 weeks of receipt of your order & check. For international destinations, email a list of desired Proceedings (RCA-proceedings@ antiquewireless.org ) and we will reply with a US$ price for your international shipment.

PROCEEDINGS • SPRING 2023 WWW.RADIOCLUBOFAMERICA.ORG 69
Name: Email: Mailing Address:
Carrier
Transmitters Thomas Aug 1941
Ferris “ Includes
Applications Dow “ Impedance Measurements over
Frequency Range Packard Apr 1942 Wire Transmission of News Pictures Hancock Dec 1942 Taming the High Frequency Signal Generator Van Beuren Dec 1943 Cathode Ray Tube Applications Christaldi Nov 1945 Audio Distortion in Radio Reception Minter Jan 1946 Radio Detector Operating Characteristics Armstron year 1948 Saturable Reactor Considerations Shepard year 1950 Direct Drive Horizontal Scan System Thalner year 1950 Traffic Capacity of Distance-Measuring-Equipment Hirsch year 1950 RF Transmission Lines & Wave Guides Winlund year 1951 Multiplexed Transmission of FM Broadcast Signals Armstrong year 1953 Armstrong – The Hero as Inventor (Article from Harpers) Dreher Apr 1956 Teleglobe Pay-TV System Kamen Apr 1963 Reliability & Maintainability of Electronic Devices Calabro Jul 1963 New York Fire Communications Rheinhardt Nov 1963
Deviation in FM
Includes Orbital Beam Multiplier Tube
Inductive-Output Tube
a Wide
The following invited article is reprinted with permission of the author and IEEE: T. S. Rappaport, “Crucible of Communications: How Amateur Radio Launched the Information Age and Brought High Tech to Life: Part 1: The Birth and Breadth of the Ham Radio Hobby Invited Article,” in IEEE Communications Magazine, vol. 60, no. 10, pp. 6-10, October 2022, © 2022 IEEE doi: 10.1109/MCOM.2022.9928087.
COMMUNICATIONS HISTORY
CruCible of CommuniCations: How amateur radio launCHed tHe information age and brougHt HigH teCH to life
Part 1: tHe birtH and breadtH of tHe Ham radio Hobby invited artiCle
Theodore. S. Rappaport, N9NB, IEEE Fellow, Lee/Weber Chaired Professor of Electrical and Computer Engineering, Founding Director of NYU WIRELESS, New York University
AbstrAct
The hobby of amateur radio, or “ham radio” as it is commonly known among its 3 million global practitioners, has been at the vanguard of electrical and computer engineering since a young Italian inventor, Guglielmo Marconi, first demonstrated wireless at his summer home in Bologna in 1894. Ever since that fateful discovery, amateur radio has played vast and vital roles in capturing the imagination of inventors, spawning new technologies, fueling the global engineering work force, and fostering friendship and international goodwill. This three-part series of articles chronicles the historical evolution of amateur radio, and shows the astounding impact that the ham radio hobby has made on both the engineering profession and the world.
IntroductIon
Since the beginning of the 20th century, the hobby of amateur radio (or “ham radio” as it is affectionately known) has incubated a global arsenal of trained technical experts, and has served as the world’s proving ground for wireless communications technologies. The hobby has also provided a unique social melting pot for people from all walks of life — from ages 5 to 109 — to share in the passion of wireless communications and experimentation [1, 2]. The avocation of ham radio allows one to tinker with communication systems, software, electronics, and antennas, facilitating a very strong intuitive understanding of fundamental principles of science, technology, engineering, and math (STEM). At the same time, practitioners of ham radio develop social skills and self-confidence by sharing and learning their craft with others, and gain access to a global network of friends, colleagues, and mentors through their pursuits of the hobby.
Using tiny slivers of licensed radio frequency bands throughout the entire electromagnetic spectrum, amateur radio operators around the world are granted access to the airwaves through the Radio Regulations of the International Telecommunication Union — Radiocommunication Standardization Sector (ITU-R) [3]. Ham operators are licensed by their own country’s government, assigned a unique call sign identifier for communicating throughout the world, and are permitted to operate their own hobby radio stations for the purposes of two-way communications, experimentation, and enjoyment. More than a dozen shared ham bands are available and harmonized across the globe, from the lowest carrier frequency of 136 kHz (the 2200 meter band, with a 1 W power limit) to the highest band of 47 GHz in the millimeter-wave regime.
The term “ham” is believed to have originated from wireline telegraph operators who used the word to denigrate other operators who did not receive Morse code accurately, or who had poor or unintelligible sending styles (e.g., bad fists). In G.M. Dodge’s 1903 book, The Telegraph Instructor, a “ham” is described as a poor operator, a “plug.” It seems that early professional wireless operators brought that pejorative from their wireline practice to describe the non-paid hobbyists who were building their own radio stations and were causing radio interference, but the hobby embraced the label from the onset.
Hams design, build, or buy a wide range of transmitters, receivers, amplifiers, antennas, audio and radio frequency filters, comput-
er controllers, switching systems, and other gadgets in a constant quest to improve their stations or to enhance operations for a particular facet of the hobby that most intrigues them. Using their personal radio stations, which they call “rigs,” hams engage in experimentation and discovery, enjoy leisurely conversations with other hams, try out new modes of digital and analog communications, and pursue personal interests among the many varied aspects of the hobby, such as long-distance (DX) communications, contesting, emergency preparedness, moon bounce, satellite communications, model airplane remote control, and county hunting, just to name a few. Many ham operators have “the gift of gab” and enjoy the art of “rag chewing,” a good-natured term for describing an extremely long conversation with other hams over the air.
Each country provides its own licensing structure to allow citizens to gain their amateur radio license, offering different classes of license that incentivize and reward applicants to attain greater demonstrated levels of technical knowledge and operating proficiency in exchange for greater access to the amateur radio spectrum. Maximum station transmitter power is limited to about 1 kW, depending on country, the class of license, and particular frequency band. As part of the ITU spectrum allocation, there is international agreement that amateur radio frequencies are provided strictly for hobby use, and must be open for anyone to intercept and eavesdrop over the air to promote self-policing, although some modulation and coding methods make eavesdropping more technically difficult. Using ham radio to bypass commercial communication networks is prohibited [4].
Today, amateur radio uses analog transmissions such as Morse code (CW), single sideband (SSB), and frequency modulation (FM), and a wide range of digital modulations such as frequency shift keying (FSK), phase shift keying (PSK), and 8-GFSK (Gaussian FSK) for radio teletype (RTTY), amateur slow scan television (ATV or SSTV) and weak signal Joe Taylor (WSJT) applications such as meteor scatter, moon bounce, propagation sounding, or other types of weak signal work. Morse code is still a very popular communications mode in ham radio, despite the fact that most countries removed the code proficiency requirement for licensing decades ago. A computer communications mode known as FT-8 has become extremely popular in recent years and is used for DX computer communications with very modest stations or when propagation is marginal [5]. Casual over-the-air listening (e.g., tuning of the bands) quickly reveals that rig styles vary widely, from antique tube radios to ultra-modern direct conversion software defined radios (SDR) that hams build from scratch (e.g., home brew), purchase in kit form and assemble, or purchase from a wide range of international vendors. Hams design and deploy their own antennas for their rigs, and operate from a wide range of locations. Antennas run the gamut from simple indoor wire dipoles for apartment dwellers, to whip antennas on vehicles, to massive towers with rotatable yagi beams erected on large seaside lots or mountaintops. Some hams operate large stations remotely by logging in from anywhere via the Internet.
In the begInnIng
At the dawn of wireless, none of today’s modulations existed. There was only the spark gap transmitter and the coherer receiver, and only Morse code telegraphy could be used, since Prof.
PROCEEDINGS • SPRING 2023 WWW.RADIOCLUBOFAMERICA.ORG 70 IEEE Communications Magazine • October 2022 6
Reginald Fessenden had not yet stunned and amazed the world with his transmission of sound. In 1899, Prof. Jerome Green of Notre Dame published “The Apparatus for Wireless Telegraph” in the July edition of American Electrician, where he provided the reader with very modest but detailed circuitry using commonplace electronics to transmit up to two miles [6]. At that time, radios were constructed on blocks of wood with hand wound coils, crudely built capacitors (condensers), and batteries, as can be seen in Fig. 1 from Marconi’s original wireless set from 1894.
Professor Green’s paper launched the hobby of ham radio by igniting the imagination of experimenters through the magic of wireless (Fig. 2), and that magic continues to fuel the hobby to this day. As shown in this article, governments had to quickly catch up to encourage but manage the use of this new thing called “radio spectrum,” as more and more experimenters began to build transmitters to tinker with wireless communications. As discussed subsequently, the sinking of the Titanic in 1912 brought the entire world together with the realization that it was in the public’s best interest to encourage all possible development in wireless communications.
The growing fascination with and interest in amateur radio was not just due to the birth of wireless and the development of affordable electronics alone. The Wright Brothers’ first flying machine, demonstrated in 1903, followed by their successful airplane flight of 1905, further fueled intense interest in wireless. Now, hobbyists with an inclination for understanding how things worked (e.g., those interested in engineering) could simultaneously experiment with small model airplanes as well as wireless sets, and many hobbyists realized that wireless could eventually be used to control airplanes and other remote devices.
These early tinkerers, the first amateur radio enthusiasts, operated in an unregulated world without any channelized spectrum, no standards, and no licenses, just wide-open opportunities to experiment, transmit, receive, and tinker with the crude electronics of the day. Anyone was able to communicate with anyone else who happened to also be using the radio waves at the same time, despite the public’s perception that wireless telegraph was private [7]. A 1907 article in Electrician and Mechanic taught readers how their amateur stations could be expected to perform, based on the particular circuitry, antenna, and detector they chose to use (Fig. 3).
See Table 1 From 1907 Electrician and Mechanic (From: [8]).

It was also in 1907 that the U.S. Navy became particularly bothered by two teenagers, Henry C. Heim and Alfred Wolf, who listened in to the wireless telegraph transmissions between a fleet of naval vessels off the shore of Alameda, California. The boys heard messages and compiled a book of the “choicest confidences” between sailors, officers, and people on land, and then provided the most embarrassing messages to the San Francisco Examiner. The boys even went so far as to spoof an Admiral, using their clandestine transmitter to delay the departure of a naval ship [9]. These types of incidents gave early amateur operators a bad name, and created deep mistrust among naval and commercial operators while the hobby was in its infancy. However, even with such occurrences, the public’s growing interest in radio could not be squelched. The ability to create one’s own equipment to navigate the invisible airwaves fueled further interest in this fascinating hobby [10].
It was the dual and near-simultaneous discoveries of practical wireless communications and airplanes that motivated a small group of teenagers from New York City to transform their Aero Club to the Junior Wireless Club in January 1909. This group of teenaged and pre-teen boys, led by honorary president E. Lillian Todd (the world’s first woman aircraft designer) and advisor Prof. Reginald Fessenden, eventually became the Radio Club of America, the world’s oldest radio society [8]. The title of “first wireless society in the world” is sometimes contested by the Australian Institute of Wireless, founded in 1910 as the Wireless Institute of New South Wales, later becoming the Wireless Institute of Australia. The Wireless Association of America, an hon-
orary club founded in 1909 by Hugo Gernback, who published Modern Electrics (the world’s first magazine to cover strictly radio topics), was launched just weeks after the Junior Wireless Club, and boasted 10,000 members by late 1910. Local wireless clubs sprang up all over the world in the 1909–1912 timeframe, providing the hobby with enough “grass roots” to influence governments and the public about the coming age of wireless communications and the need to foster the amateur radio hobby.
As just one example of the influence of the very earliest of amateur radio enthusiasts, the Junior Wireless Club (later known as the Radio Club of America) was a driving force that caused the U.S. Congress to reject Senator Depew’s 1910 proposed legislation that would have completely prohibited amateur radio operators in favor of purely commercial and military (e.g., Navy) spectrum use. The lads went to Washington, DC to testify before a senate subcommittee to plead their case for the importance of amateur radio spectrum [11, 15], and other radio societies lobbied elected officials in force [8]. Students at universities across the world were beginning to build amateur radio sets, while naval officials, upset with the amateurs, complained at congressional hearings that “it was quite common with youths living in the bay cities to play with wireless telegraphy, having aerials and receiving apparatus by which could be read government wireless messages” [9]. It was clear that military and commercial interests were dead set on prohibiting amateur radio operators from ever accessing or listening in to the radio spectrum. Bill after bill in Congress was proposed from 1909 through 1912, only to be rejected by elected officials who were bombarded by the impassioned pleas for spectrum access by members of fledgling wireless clubs across the country.
The sinking of the Titanic on April 14, 1912 was the watershed moment for amateur radio. The Marconi telegraph was credited for saving over 700 people at sea, and all of humanity could now see the importance of wireless and the concurrent need to cultivate expertise in the field of wireless. This event drove Congress to modify their legislative approach. Instead of banning amateur operators altogether, the legislators agreed to finally set aside dedicated radio frequencies for experimentation and hobby use, knowing full well that the spectrum being allocated to the hams was far beyond the realm of usefulness for the technology used at that time. When President William Howard Taft signed the Radio Act of 1912 on August 17, amateur radio operators finally had a law to permit their operation, but they were relegated to the very upper, unexplored reaches of the radio spectrum — the wavelengths of 200 m and smaller —which had yet to be understood or harnessed for use [8, 11]. This model of free, protected radio spectrum for amateur hobbyists was first implemented in the United States, and was eventually adopted worldwide, leading to today’s ITU global allocations and protections for the amateur radio service, despite
PROCEEDINGS • SPRING 2023 WWW.RADIOCLUBOFAMERICA.ORG 71 IEEE Communications Magazine • October 2022 7
COMMUNICATIONS HISTORY
FIGURE 1. The author with Guglielmo Marconi’s original wireless set as preserved from 1894 at the Marconi museum in Villa Griffone, Balogna, Italy (photo taken in October 2013 at the Marconi Society board meeting).
overwhelming commercial and military interests in radio spectrum. This type of story, where hams have been the very early adopters — the first tinkerers and the ones to push the envelope of a new technology, often before they become adults — has played out time and time again since the dawn of wireless, and continues today. As shown in this series, from the dawn of the information age, from the early days of talking movies, through the golden age of AM and FM broadcasting, through the advent of television, satellites, cellular telephones, packet radio, and the Internet, hams have always been at the very cutting edge, and have in many cases been responsible for creating the continuing advances in communications. Given the heritage of ham radio operators as early adopters (and in many cases the inventors) of new technologies and communication modes, it should come as no surprise that vendors with pioneering ideas often target the amateur radio market before investing and growing product lines for government and commercial marketplaces. As described in this series, it is the ham radio community’s spirit of tinkering with, improving, and socializing each new communications technology that has brought high tech solutions to the world at large.


the hAm spIrIt: A globAl felloWshIp
The ham radio hobby has an incredibly strong “esprit de corps,” since licensed amateurs throughout the world realize their good fortune of having free access to the very precious resource of spectrum that is usually licensed to commercial interests to generate revenues for government coffers. From this sharing of the “radio commons,” a genuine comradery and deep respect
among fellow hams permeate the hobby, transcending language barriers, socioeconomic status, religion, level of education, profession, or country borders. Women and young people (teenagers or younger) are especially encouraged and welcomed both on the air and at local in-person monthly meetings held at the tens of thousands of community amateur radio clubs throughout the world. But the hobby realizes it must do more to bring in underrepresented citizens. In a February 2022 opinion article, David Minter, the Chief Executive of the American Radio Relay League (ARRL), one of the world’s largest national amateur radio organizations, made a call for an increased push to increase the diversity of the hobby in the face of an anemic 1 percent annual growth rate for U.S. amateur licensees [12]. Today, about 15 percent of licensed ham operators are female, and many males are aging out of the hobby. With the great need to increase access and diversity in STEM, efforts are underway worldwide to increase underrepresented groups. Within the past few years, the hobby has seen rapid growth of licensed amateur radio operators in Thailand, China, and Indonesia, which bodes well for the international growth of the hobby.
Hams are never strangers to one another — there is most often an instant bond when fellow hams meet for the first time, whether in person or on the air — and life-long friendships across the world naturally evolve through shared interests in the hobby. Ham operators who talk with each other over the radio may exchange electronic or paper QSL cards commemorating on-air contact, although most QSLing today is done through the Internet, using applications such as the Logbook of the World developed by the American Radio Relay League (ARRL).1
Hams enjoy meeting over the airwaves, but also often meet in person for technical interchanges or to simply rag chew about their stations, recent contacts, or matters entirely unrelated to ham radio. Such meetings are usually over a meal, and when such a meeting occurs in person, as opposed to over the air, it is called an “eye-ball QSO.” It is not uncommon for hams to talk with each other over the air for years, perhaps never meeting in person, or perhaps meeting their invisible ham friend in person years or decades later, at a distant club meeting or “hamfest.”2 Many life-long, deep personal and professional linkages are formed between fellow hams that typically transcend the hobby, leading to planned family vacations, job opportunities, technical innovations, and business ventures, all while creating a vast citizenry with core competencies and vital expertise that propels the entire electronics communications complex in peace time, or the military complex during war time. It is not an exaggeration to state that ham radio was the world’s first global social network.
some fAmous AmAteur rAdIo operAtors
The ranks of radio amateurs are filled with women and men who have shaped our civilization from all walks of life. While it is impossible to list the enormous number of hams who have made history, a small sampling will motivate the reader to see how the hobby involves people from many different backgrounds. For example, famed Austrian-born movie actress Hedy Lamarr (Fig. 4) invented frequency hopping spread spectrum and created underwater missile guidance systems while dabbling in amateur radio before World War II [13].

1 The international amateur radio community uses Q-signals and other abbreviations for common messages. For example. a radio contact is called a QSO, a ham’s location is called their QTH, and a station may make an open call to solicit a radio contact on any frequency by calling CQ, (abbreviation stemming from “seek you”).

2 Hamfests are large gatherings of amateur operators and non-licensed radio enthusiasts that are held over a weekend and include technical talks, social outings, swap meets, vendor exhibitions, and flea market equipment sales. The world’s largest hamfests often have more than 30,000 attendees and are held annually in Dayton, Ohio in May, Central Florida in February, Friedrichshafen, Germany in June, and Tokyo in October, with thousands of other smaller hamfests held throughout the world each year.

PROCEEDINGS • SPRING 2023 WWW.RADIOCLUBOFAMERICA.ORG 72 8 IEEE Communications Magazine • October 2022
COMMUNICATIONS HISTORY
FIGURE 3. A table from the Electrician and Mechanic in 1907 teaches readers what type of range can be expected when constructing their home brew wireless transmitter and receiver system [8].
FIGURE 2. Circuitry published by Prof. Jerome Green in the July 1899 issue of American Electrician [6]. The circuits were able to cause the coherer to ring a bell using wireless transmissions over a distance of 2 miles on the campus of Notre Dame. https://earlyradiohistory.us/1899nd.htm.
Other notables such as Rajiv Ghandi (Prime Minister of India, VU2RG), King Hussein of Jordan (JY1), King Juan Carlos of Spain (EA0JC), King of Thailand Bhumibol Adulyadej (Rama IX, HS1A), King Hassan II of Morroco (CN8MH), the Sultan of Oman, Qaboos bin Said al Said (A41AA), Carlos Saul Menem (President of Argentina, LU1SM), U.S. Senator Barry Goldwater (K7UGA), movie actor Marlon Brando (FO5GJ), Yuri Gagarin (the Russian astronaut who was the first human in space, UA1LO), Owen Garriott (first ham radio astronaut to transmit from space on the space shuttle, W5LFL), Mamoru Mohri (the first Japanese space program astronaut, 7L2NJY), Helen Sharman (the first British astronaut in space, GB1SS), Kathy Sullivan (the first NASA astronaut to walk in space and to dive to the deepest part of Earth, N5YYV), aviation magnate Howard Hughes (W5CY), Jon Sculley (former president of PepsiCo and CEO of Apple, K2HEP), Alex Comfort (the author of Joy of Sex, KA6UXR), and baseball great Joe Rudi (NK7U) are or have been licensed hams. Many famous musicians and recording artists are or were amateur operators, including Jim Croce, Burl Ives, Joe Walsh of the Eagles, teenage idol Donnie Osmond, Patty Loveless, Chet Atkins, Ronnie Milsap, Larnelle Harris, and Larry Junstrom. Even the wife of Elvis Presley, Priscilla Presley, is a ham radio operator, while the legendary country music star Johnny Cash was a highly skilled Morse code interceptor in the U.S. Air Force before he became a country music icon.
Ham radio has influenced all segments of radio and television, providing a crucible from which the personalities and technical innovations for all forms of broadcast entertainment have been hatched. Hams have ignited the world’s imagination and fascination with radio since the golden age of radio in the 1920s, from the era of silent movies through the global adoption of AM and FM broadcasting, through the black and white, and then color, television era, and through the coverage of the international space race [14–16]. Walter Cronkite (a U.S. television news anchor known as the most trusted man in America, KB2GSD), space reporter Roy Neal (K6DUE), and TV humorist and producer Jean Shephard (K2ORS) molded the way content was delivered over the commercial airwaves, while Akio Morita (JP1DPJ) and Masru Ibuka (J3BB) founded Sony Corporation, Robert Moog (K2AMH) invented the music synthesizer, Ray Dolby (F5BVY) invented cinematic sound at Dolby Labs, Leo Fender (W6DUE) created the Fender electric guitar, and Nolen Bushnell (W7DUK) founded video game pioneer Atari.
Along with the large number of high-tech entrepreneurs who used amateur radio to kindle their early love for communications and electronics, the famous science fiction writer, Sir Arthur C. Clarke, conceived the notion of geostationary satellites in 1945 [17], and had personal interest and deep connections with the amateur radio community in Sri Lanka. The famous founders of Apple, Steve Jobs and Steve Wozniak, honed their high-tech computer instincts through ham radio as young boys [18, 19], where they greatly benefitted from the Silicon Valley culture inculcated by the venerable Dean of Engineering of Stanford University, Frederick Terman, who founded Silicon Valley three decades earlier. Terman was also a ham radio operator in his youth, much younger than others practicing the hobby in his home town [20], and his early experiences interacting with adults, while he himself was a child, developed both his engineering skills and confidence to later lead large teams to form companies while also creating the classic electrical engineering education textbooks of his era that impacted the entire field of engineering. Terman’s students, Bill Hewlett and David Packard (also hams), founded Hewlett Packard in 1939, which became the global leader in test equipment manufacturing. The first Hewlett Packard audio oscillator was used for Walt Disney’s groundbreaking movie Fantasia — the first movie to be shown with stereo sound — in 1940. Today’s corporate giants Hewlett
Packard Enterprises, Aruba, Agilent, and Keysight Technologies can all trace their roots to the two amateur radio operators who studied under their Stanford professor who, too, was a ham.

Jack Kilby, also a ham operator who worked on early transistors, is known as the inventor of the microchip, the hand calculator, and the thermal printer while working at Texas Instruments. Kilby received the Nobel Prize in Physics. Before moving to Texas Instruments, however, Kilby worked at Centralab in Milwaukee where he collaborated with another ham operator, walkie-talkie inventor and citizens band pioneer Al Gross, to create a rugged circuit board capable of housing tubes for the world’s first walkie-talkies that Gross developed and sold to the public in 1938 [21–23]. More recently, Princeton astrophysicist and Nobel Prize winner Joe Taylor (K1JT) has developed open source weak signal modulation and coding software that has caught the ham radio hobby by storm over the past decade, as it enables ham operators to make QSOs around the world using many exciting propagation channels using very modest powers and antennas with a simple sound card and computer-controlled digital modulations [5].

PROCEEDINGS • SPRING 2023 WWW.RADIOCLUBOFAMERICA.ORG 73 IEEE Communications Magazine • October 2022 9
COMMUNICATIONS HISTORY
FIGURE 4. Movie star Hedy Lamarr was an avid experimenter with radio and invented frequency hopping spread spectrum (Photo from https://www.forbes.com/sites/ shivaunefield/2018/02/28/hedy-lamarr-the-incredible-mind-behind-secure-wi-fi-gps-bluetooth/?sh=4f411b1341b7.)
FIGURE 5. Al Gross, W8PAL, the father of citizens band radio, is shown with his original walkie-talkie invention that now resides in the permanent collection of Virginia Tech [22]. (Photo from: https://lemelson.mit.edu/award-winners/al-gross).
conclusIon And WhAt’s to come In thIs serIes
This article, Part 1 of a three-part series, has provided an introduction to the origins and current practice of the hobby of amateur radio. It should be clear that the hobby has had a great impact on the communications engineering profession, and offers a special comradery that exposes its practitioners to many social interactions and technical development opportunities with experts and enthusiasts from all walks of life. The ability to expand one’s technical knowledge and interest has always been at the core of the hobby. In the coming series of articles, the historic account of how amateur radio operators and the hobby played a key role in the creation of today’s information age will be chronicled.
Part 2 of this series will delve into the history of how universities facilitated amateur radio on their campuses to build up a major arsenal of technical experts who went on to develop the global radio broadcast industries, long-distance telephone, television, stereo, the walkie-talkie, and radar. The importance of amateur radio in exploring the Earth by sea, and the role of hams in World War I and World War II will also be described, as militaries relied on the skills and innovations of amateur operators to support wartime communications. A historical perspective of the growth of Silicon Valley, and other high-tech centers around the world will highlight the role that ham radio played, as these technical incubations and innovations were couched in the amateur radio spirit, with hams often being the first employees of startup companies that powered the expansion of the information age. Even during the Cold War, the history will show how amateur radio maintained international relations among ham radio enthusiasts on both sides of the Iron Curtain, even as governments were adversarial to each other.
Part 3, the final installment in this series, will offer a historical account of how amateur radio operators began learning about VHF and UHF frequencies, where they created nationwide repeater systems, often with touch-tone telephone capabilities, thereby proving the concepts and creating the global engineering talent pool needed for the fledgling cellular telephone industry. The history of the Internet would not be complete without understanding how amateur operators developed and perfected packet data communications, digital modulations, and open source circuit boards and software for nationwide computer networks that linked thousands of amateur stations across the world, decades before the Internet. The activities of pioneering ham clubs like Tucson Amateur Packet Radio (TAPR) sparked global interest in computer networking through the ham radio “packet cluster.” The “big board” computers built at ham clubs across the world in the 1970s and 1980s fueled the fledgling personal computer industry. The launch of OSCAR 1 in 1961, the world’s first amateur radio satellite, spawned deep technical expertise and technical know-how for the global satellite industry, leading to the creation of non-profits such as Radio Amateur Satellite Corporation (AMSAT), which sponsored rockets and built satellites that serve hams around the world. Hams of every nation participate in their country’s “field day,” where clubs set up stations in the wilderness over a weekend to simulate emergency communications needed in a national disaster [24]. The hobby even has its own Olympic Games. Known as the World Radiosport Team Competition (WRTC), the ham radio Olympics are held every four years around the world, and will next be hosted in 2023 by Italy in the city of Bologna (the site of Marconi’s original wireless transmissions) [25]. The use of amateur radio to explore the ionosphere in new ways, and with new radio architectures and crowd-sourcing Internet-based monitoring systems like the Reverse Beacon Network (RBN), has created new fields of research, such as “space weather” to predict the upper reaches of our planet’s protective layers. The final article in this trilogy shall delve into the fascinating role that ham radio has played in all of these modern advances that impact civilization, and shall conclude with a perspective on what lies ahead for the incredible hobby of amateur radio.
references
[1] D. Haldane, “Girl Hams It Up for the World : Ham Radio: At 5, She’s Maybe the Youngest Operator in U.S. Her Mental Skills Are Surprising,” Los Angeles Times, July 21, 1991; https://www.latimes.com/archives/la-xpm-1991-07-21-hl502-story.html.
[2] “Oldest Known US Radio Amateur, Cliff Kayhart, W4KKP, SK at 109,” QST Magzine, American Radio Relay League News, Oct. 29, 2020; http://www.arrl. org/news/oldest-known-us-radio-amateur-cliff-kayhart-w4kkp-sk-at-109
[3] “Amateur and Amateur-Satellite Services,” Radio Regulations, ITU-R , Radio Handbook , 2014; https://www.itu.int/en/publications/ITU-/pages/publications.aspx?parent=R-HDB-52-2014&media=electronic).
[4] J. Pepitone, “Is Ham Radio A Hobby, A Utility… or Both?,” IEEE Spectrum, July 8, 2019; https://spectrum.ieee.org/is-ham-radio-a-hobby-a-utilityor-both-a-battle-over-spectrum-heats-up.
[5] J. Taylor, K1JT, “WSJT Home Page by K1JT”; https://physics.princeton.edu/ pulsar/k1jt/, accessed Aug. 1, 2022.
[6] J. Green, “The Apparatus for Wireless Telegraph,” American Electrician, July 1899.
[7] A. C. Madrigal, “The Great Wireless Hack of 1903,” The Atlantic, Dec. 9, 2011; https://www.theatlantic.com/technology/archive/2011/12/the-great-wirelesshack-of-1903/250665/.
[8] C. B. DeSoto, “Two Hundred Meters and Down: The Story of Amateur Radio,” The American Radio Relay League, 1936, West Hartford, CT.
[9] Hearings Before a Congressional Subcommittee of the Committee on Naval Affairs of the House of Representatives on H.J. Resolution 95, A Bill to Regulate and Control the Use of Wireless Telegraphy and Wireless Telephony, Government Printing Office, 1910, Washington, DC.
[10] R. A. Bartlett, The World of Ham Radio, 1901–1950: A Social History, MacFarland and Co., 2007.
[11] W.E.D. Stokes, Jr. “The Radio Club of America,” Proc. Radio Club of America (1BCG Commemorative Issue), Oct. 1950, pp. 66–67; https://worldradiohistory.com/Archive-Radio-Club-of-America/Radio-Club-of-America-1950-10.pdf.
[12] D. A. Minster, NA2AA, “Diversity and Inclusion: Driving Amateur Radio’s Growth,” QST Mag., Feb. 2022, p. 9.
[13] D. Khan, “Cryptology and the Origins of Spread Spectrum: Engineers During World War II Developed an Unbreakable Scrambler to Guarantee Secure Communications Between Allied Leaders; Actress Hedy Lamarr Played A Role in the Technology,” IEEE Spectrum , vol. 21, no. 9, pp. 70–80; https://ieeexplore.ieee.org/document/6370466.
[14] S. J. Douglas, Listening In: Radio and the American Imagination , Times Books, 1999.
[15] Proceedings of the Radio Club of America, Diamond Jubilee issue, 75th Anniversary of the Radio Club of America, 1984.
[16] T. Lewis, Empire of the Air: The Men Who Made Radio, Harper Collins, 1991.
[17] A. C. Clarke, “V2 for Ionospheric Research?,” Letters to the Editor, Wireless World, Feb. 1945, p. 58.
[18] Razvan, “Steve Jobs Influenced by Ham Radio, “Nov. 27, 2013, based on Smithsonian Institute/Computerworld Information Technology Awards History Project, April 20, 1995; https://qrpblog.com/2013/11/steve-jobs-influencedby-ham-radio/ (also find the Oral Histories at Smithsonian shown on this webpage for better cite).
[19] W. Isaacson, Steve Jobs, Simon & Schuster, 2012.
[20] San Jose History Project, Frederick Terman with amateur radio equipment, 1917; https://historysanjose.pastperfectonline.com/photo/AF0C3384-3C1444E2-BFED-154452200970; also see https://calisphere.org/item/208eedb7acabd2b9f3e6f85b1ebd0729/
[21], “In Memorium: Alfred J. Gross, Wireless Radio Systems Pioneer,” IEEE AESS Systems Mag. , Mar. 2001, pp. 43–44; https://ieeexplore.ieee.org/stamp/ stamp.jsp?arnumber=911321.
[22] A Guide to the Al Gross papers, 1909–2000, Virginia Tech Library, A Collection in Special Collections, Collection Number Ms2001-011; https://ead.lib. virginia.edu/vivaxtf/view?docId=vt/viblbv00043.xml.
[23] Correspondence with Al Gross, from Jack S. Kilby Papers, 1878–2003, U.S. Library of Congress; https://www.loc.gov/item/mm2006085317/.
[24], “The Uncertain Future of Amateur Radio,” IEEE Spectrum , July 10, 2020; https://spectrum.ieee.org/ham-radio.
[25] J. K. George, “Contact Sport: A Story of Champions, Airwaves, and a OneDay Race around the World, “ c. 2016.
bIogrAphy
Theodore. S. rappaporT (tsr@nyu.edu) is the David Lee/Ernst Weber Professor at New York University (NYU). He founded the NYU WIRELESS research center and the wireless research centers at the University of Texas Austin (WNCG) and Virginia Tech (MPRG). His work has provided fundamental knowledge of wireless channels used to create the IEEE 802.11 standard, the first U.S. digital TDMA and CDMA standards, the first public Wi-Fi hotspots, and recently proved the viability of mmwave and sub-THz frequencies for 5G, 6G, and beyond. He founded two businesses that were sold to publicly traded companies – TSR Technologies, Inc. and Wireless Valley Communications, Inc., and was an advisor to Straight Path Communications which sold 5G mmWave spectrum to Verizon. He is a licensed Professional Engineer and is in the Wireless Hall of Fame, a member of the National Academy of Engineering, a Fellow of the National Academy of Inventors, and a life member of the American Radio Relay League. His ham radio call sign is N9NB.
PROCEEDINGS • SPRING 2023 WWW.RADIOCLUBOFAMERICA.ORG 74 10 IEEE Communications Magazine • October 2022
COMMUNICATIONS HISTORY

LAWSUIT FILED OVER PRESERVING BELL LABORATORIES’ HOLMDEL HORN ANTENNA
By David Bart
Crawford Hill in Holmdel, New Jersey is the site of a large microwave horn antenna (the “Horn Antenna”) that was used as a satellite communication antenna and radio telescope during the 1960s. Constructed by Bell Telephone Laboratories in Holmdel Township, New Jersey, the antenna sits atop the highest peak in Monmouth County. It was used in Project Echo (a satellite balloon or ‘satelloon’ experiment acting as a passive reflector of microwave signals in 1960) and in Project Telstar (an interactive relay satellite in 1962). It was also for radio related astronomical research.
THE HORN ANTENNA’S MASER SYSTEM

The Horn Antenna’s system depended upon an amplification concept that would eventually be used to develop laser technology, called the maser. Charles H. Townes, James P. Gordon, and Herbert J. Zeiger at Columbia University devised the first maser, achieving microwave amplification by stimulated emission of radiation. The maser generates electromagnetic waves at microwave frequencies through amplification using the process of stimulated emission; when atoms amplify radiation after being induced into an excited state. These excitations were achieved at extremely low temperatures of approximately 2 Kelvin in liquid helium.
Reception of the weak satellite signals from Project Echo and later Project Telstar using a giant horn antenna depended upon amplifying the signals with a maser placed at the apex of the horn. The horn focused the circularity of the weak carrier signals into the waveguide assembly, which converted and then separated the waveguide channels. The two channels were preamplified using the maser. The signals were then heterodyned to an intermediate frequency (IF), further amplified in the IF network, and transmitted to the “output end” of the receiver. (for more discussion about the horn and its design, see Bart, 2023)
The National Historic Landmark Registration form stated that Holmdel Horn Antenna was “extremely broad band, has calculable aperture efficiency, and the back and side lobes are so minimal that scarcely any thermal energy is picked up from the ground.” It was considered an ideal radio telescope for accurate reception of Telstar signals and would later be used to measure low levels of weak, cosmic background radiation. A plastic clapboarded utility shed with dimensions of 10 x 20 feet with two windows and a double door stood next to the horn antenna, housing equipment and controls. When not in use, the antenna azimuth sprocket drive could be disengaged, permitting the structure to be positions so it would experience minimum wind resistance. The antenna was designed to withstand

PROCEEDINGS • SPRING 2023 WWW.RADIOCLUBOFAMERICA.ORG 76
The Holmdel Horn Antenna was 50 feet in length, and the entire structure weighed about 18 tons. It was composed of aluminum with a steel base. Photo circa 1962. (Courtesy NASA)
FEATURE
Cover of Electronics World, Nov. 1960, featuring the Holmdel Horn Antenna and its maser system. (Authors’ collection)
winds of 100 miles per hour and the entire structure weighed 18 tons.
Bell Labs described in detail many of the technical aspects of the Horn Antenna’s design and performance in its publication The Bell System Technical Journal. Bell Labs released numerous scientific and engineering articles and materials regarding Project Echo and Project Telstar, many of which were also re-published by NASA.
COSMIC MICROWAVE BACKGROUND RADIATION
In 1965 while using the Horn Antenna for Telstar related research on radio signals and receiver interference, two radio astronomers, Dr. Arno Penzias and Dr. Robert W. Wilson, discovered that cosmic microwave background radiation permeates the universe.


Penzias and Wilson removed the effects of radar and radio broadcasting and effectively suppressed interference from the heart of the receiver. This was accomplished by cooling it with liquid helium to -269 °C, only 4 °C above absolute zero, and relying on the maser.
Their discovery provided evidence that confirmed George Gamow’s and Georges Lemaître’s Big Bang Theory about the creation of the universe. Penzias and Wilson made further modifications to the Horn Antenna, and the dish antennas that were also located at Holmdel, in 1966 and 1968. These modifications enabled them to make additional measurements that further confirmed the galactic center of the universe.

Penzias and Wilson received the 1978 Nobel Prize in Physics for their discoveries. Wilson explained the importance of the Holmdel Antenna in his Nobel Prize acceptance speech, stating: “Traveling-wave maser amplifiers were available for use with the 20-foot hornreflector, which meant that for large diameter sources (those subtending angles larger than the antenna beamwidth), this would be the world’s most sensitive radio telescope.”
LANDMARK STATUS
In 1989, the Horn Antenna was designated a National Historic Landmark because of its association with the Penzias and Wilson discoveries. The site was placed on the New Jersey Register of Historic Places in 1993.
SALE OF THE SITE
Following the breakup of AT&T and later sale of Bell Laboratories, Nokia of America Corporation eventually became the owner of the 43-acre site. Nokia sold the research building along with the land for approximately $3.6 million in early 2021.
Holmdel Township officials have continued to seek assurances that if the land is developed, the Horn Antenna will be preserved. The current owner, Crawford Hill Holding LLC, the contract purchaser, Burke Contracting LLC, and the seller, Nokia, have not clarified the questions about ownership of the Horn Antenna and rights to develop the land.
PROCEEDINGS • SPRING 2023 WWW.RADIOCLUBOFAMERICA.ORG 77
Model of the Bell Laboratories’ Holdmel Horn Antenna with a replica of the graph from Arno Penzias’ and Robert W. Wilson’s 1964 measurements of cosmic background radiation, on display at Nokia Bell Labs Museum at Murray Hill in 2019. (Author’s photo)
Robert W. Wilson (l) and Arno Penzias (r) standing in front of the Horn Antenna on Crawford Hill circa 1978. (Courtesy Associated Press)
Robert W. Wilson’s 1978 Nobel Prize Lecture, “The Cosmic Microwave Background Radiation.” (Author’s collection)
The sales contract purportedly states that Nokia retains certain rights to the Horn Antenna. The sales contract specifies that the Horn Antenna should remain at the site, and it should remain open to the public. Further, if Crawford Hill Holding sought to remove the antenna, Nokia has first rights to remove and relocate it.
HOLMDEL TOWNSHIP’S LAWSUIT
Holmdel Township has filed a lawsuit to determine who owns the Horn Antenna and the hilltop, and the rights of the parties. This is part of a strategy to determine whether the township can acquire it through eminent domain. Holmdel Mayor D. J. Luccarelli stated, “The Township is not in a position to negotiate the future of Crawford Hill until we determine the ownership of the Horn Antenna.”
The Holmdel council initially authorized the planning board in November 2022 to conduct a study regarding whether the property at 791 Holmdel Road can be designated an area in need of redevelopment for non-condemnation purposes under New Jersey’s Local Redevelopment and Housing Law. Then, in March 2023, the council passed a resolution to do a study to see if it can be designated an area in need of redevelopment for condemnation purposes. The change in designation would allow town officials to negotiate directly with the property’s owner to acquire it. Luccarelli stated, “As mayor, I remain steadfast in my commitment to use every possible legal avenue to protect Holmdel’s legacy.”
The two-count complaint asks for declaratory judgement on the ownership of the Horn Antenna and on whether eminent domain can be applied to it.


• The complaint argues that the sale contract states: “In the event buyer intends to relocate the Horn Antenna, buyer shall notify seller of such new location.” The contract further states, “Buyer understands and agrees that relocating the Horn Antenna from the current designated site would require a new application to have the new site designated as a historical site. In addition, if
buyer makes a determination that it no longer wants the Horn Antenna, buyer shall contact seller and give seller the first right to remove and relocate the Horn Antenna.”
• The complaint also states, “Crawford Hill Holding and Burke have never provided the township with any definitive information concerning the ownership and control of the Horn Antenna, nor have they provided any information other than the clause within the sale contract.”
Township attorney Mike Collins explained that in addition to determining the ownership of the antenna, “the township is asking the court to determine if it may potentially exercise eminent domain powers as it pertains to the Horn Antenna.” Collins stated the township believes the Horn Antenna “is fixed to the property,” and Crawford Hill Holding and Burke Contracting have indicated that Nokia of America Corp. have a contractual right to relocate the Horn Antenna. Collins said a judgment could take months to a year.
A PETITION TO SAVE THE HORN
The Horn Antenna still stands along with several other nonoperating satellite dishes and old support buildings atop Crawford Hill, which is accessible to the general public. All of the equipment from inside the antenna and the nearby building that housed the controls has been removed. More than 7,700 people have signed a petition to save the Horn Antenna. Citizens for Informed Land Use (CILU), Friends of Holmdel Open Space (FOHOS) and Preserve Holmdel (PH) seek to block developing the property and removing or destroying the Horn Antenna. The petition seeks to preserve the Horn Antenna and its grounds in perpetuity as a public historic landmark and park. Stay tuned for more developments. In the meantime, a proposal to recognize the achievements reached at the site and at other locations with an IEEE Milestone designation is currently pending. The topics potentially covered by the proposed milestone include Project Echo, Project Telstar, and the 1964 Discovery of the Cosmic Background
PROCEEDINGS • SPRING 2023 WWW.RADIOCLUBOFAMERICA.ORG 78
Two views of the Bell Laboratories Holmdel Horn Antenna and its supporting utility building in 2019. (Author’s photo)
Radiation of the Formation of the Universe, the Big Bang, 1959 – 1965. The location of the milestone plaque may be offsite at another AT&T Labs location, but the events occurring at Crawford Hill are the basis of the claims. That debate and the milestone approval process are likely to require several months, extending into late 2023. You can be certain that there will be more news to come.
SOURCES
D. Bart and J. Bart, “Giant Horn Antennas in Space Communications,” AWA Review, Antique Wireless Association, 2023, Vol. 36.
H. Butowsky, “Holmdel Horn Antenna,” National Register of Historic Places Registration Form dated May 1, 1989, National Register of Historic Places Inventory-Nomination. National Park Service, https://npgallery.nps.gov/NRHP/ GetAsset/NHLS/89002457_text
C. Q. Choi, “Saving the Big Bang (Antenna),” IEEE Spectrum, Feb. 10, 2023.
L. Faltz, “The Holmdel Horn That ‘Heard’ The Big Bang Is At Risk,” Sky & Telescope, Dec. 9, 2022, https:// skyandtelescope.org/astronomy-news/holmdel-horn-whichheard-evidence-of-the-big-bang-is-at-risk/.

O. Liu, “Holmdel Can’t Save Big Bang Theory’s Horn Antenna Unless It Solves Mystery of Who Owns It,” Asbury Park Press, April 14, 2023, https://www.app.com/story/ news/history/2023/04/14/homdel-sues-determine-ownerbig-bang-theory-horn-antenna/70111089007/
S. Millman ed., A History of Engineering and Science in the Bell System: Physical Sciences 1925–1980, (Indianapolis: AT&T Bell Labs, 1983) pp. 271–275.
“The Nobel Prize in Physics 1978,” press release dated Oct. 17, 1978. NobelPrize.org, https://www.nobelprize.org/ prizes/physics/1978/press-release/
E. A. Ohm, “Receiving System,” The Bell System Technical Journal, July 1961, Vol. 40, No. 4, pp. 1066–1069, 1079–1080.
A. A. Penzias, R. W. Wilson, “A Measurement of Excess Antenna Temperature at 4080 Mc/s,” Astrophysical Journal, American Astronomical Society, July 1965, Vol. 142, No. 1, pp. 419–421.
A. Pries, “N. J. Town Files Lawsuit in Effort to Preserve Its Historic Big Bang Antenna,” NJ Advance Media for NJ.com, Apr. 14, 2023, https://www.nj.com/news/2023/04/nj-townfiles-lawsuit-in-effort-to-preserve-its-historic-big-bangantenna.html?outputType=amp
“Save Holmdel’s Horn Antenna,” Action Network Petition, https://actionnetwork.org/petitions/save-big-bang-antenna/
C. H. Townes, “Production of Coherent Radiation by Atoms and Molecules – Nobel Lecture”, The Nobel Prize, Dec. 11, 1964, https://www.nobelprize.org/uploads/2018/06/towneslecture.pdf
R. W. Wilson, “The Cosmic Microwave Background Radiation,” Nobel Lecture, Dec. 8, 1978, pp. 464–484, https://www.nobelprize.org/uploads/2018/06/wilsonlecture-1.pdf
ABOUT THE AUTHOR
David Bart is the current President of the Radio Club of America, Editor of the RCA Proceedings, and a Fellow. He has received numerous awards for his work involving the history of communications and is currently Treasurer of the IEEE History Committee and a Director and Fellow of the Antique Wireless Association. He is the National Director of Restructuring and Complex Litigation at Baker Tilly US LLP. He has an MBA (Finance and Accounting) and BA (Anthropology and Statistics) from the University of Chicago, and numerous professional certifications.
RCA Mentorship Program
The new RCA Mentorship Program is designed to pair RCA members together, providing opportunities for young professionals to learn and emulate the experience of more seasoned RCA members. Several mentoring pairs have already been formed and more are being formed. Learn more on the RCA website.
radioclubofamerica.org/mentor-program

PROCEEDINGS • SPRING 2023 WWW.RADIOCLUBOFAMERICA.ORG 79
A way to share your knowledge and experience, or learn from the best!
AMSAT RECRUITING ENGINEERING VOLUNTEERS
AMSAT is seeking an electrical engineer with RF experience to join its FOX-PLUS team. The team will be a collaboration of up to 10 electrical, mechanical, software, and systems engineer volunteers.
There will also be an opportunity to design and build the RF communications subsystems for a series of low-Earth orbit 1U - 3U CubeSats to support AMSAT’s educational and engineering objectives.
Candidates should have working knowledge of analog and digital communications protocols (e.g., FM, PSK, and FSK) to provide digitally synthesized audio for FM modulated VHF/UHF/SHF voice and telemetry channels. Development opportunities can begin with modification of previous FOX designs and/or with an original design.
Mechanical engineers are also needed to join AMSAT’s FOX and GOLF CubeSat teams. There will be a collaboration with an all-volunteer team of up to 12 electrical, mechanical, software, and systems engineers. The positions entail an opportunity to use structural design and analysis skills to develop a series of low-Earth orbit and highly elliptical orbit 1U - 3U CubeSats.
Contributions may include:
• The development of the space frame and deployable solar panel subsystem
• The analysis of the thermal characteristics of the CubeSat and the design of the thermal management system
• Preparation and oversight of the environmental testing procedure
• Management of documentation of the CubeSat’s adherence to the launch provider’s and space vehicle owner’s specifications
• AMSAT volunteers typically spend 5 hours per week on their projects and attend a weekly meeting online. An amateur radio license and CubeSat experience are helpful, but not necessary. US citizenship or proof of permanent residency is required.

Interested persons should send an email with their resume/ curriculum vitae to volunteer@amsat.org
SOURCES
AMSAT Assistant VP, Engineering Jonathan Brandenburg, KF5IDY and The ARRL Letter, Mar. 2, 2023.
PROCEEDINGS • SPRING 2023 WWW.RADIOCLUBOFAMERICA.ORG 80
INDUSTRY
IT’S TIME TO SECURE YOUR 2023 SPONSORSHIP RCA values our many sponsors! Contact us today to be part of our 2023 Sponsor Program. Our organization grows and encourages innovation because of your support. Thank you! Contact Karen Clark, Sponsor Committee Chair at kjclark33@comcast.net for more information.
UPDATES
CONGRESSIONAL BILLS ADDRESS AMATEUR RADIO IN THE 2023-2024 SESSION
The U.S. House of Representatives will have at least two proposals related to Amateur Radio to review in the 20232024 session. The bills introduced focus on improving antenna restrictions and HF digital operations.
BILL TO REPLACE SYMBOL RATE LIMIT WITH BANDWIDTH LIMIT
Arizona Congresswoman Debbie Lesko (AZ-08) introduced the Amateur Radio Communications Improvement Act in December 2022 to eliminate the current Symbol Rate Limit set by the Federal Communications Commission (FCC) and replace it with a 2.8 kilohertz (kHz) bandwidth limit. The bill brings regulations up to speed with modern technology advances in amateur radio.
“With advances in our modern technology, increased amounts of data can be put on the spectrum, so there is less of a need for a regulatory limit on symbol rates,” said Congresswoman Lesko. “I am pleased to introduce this important piece of legislation to update the FCC’s rules to support the critical role amateur radio operators play and better reflect the capabilities of our modern radio technology.”
This legislation eliminates the Symbol Rate Limit in 47 CFR part 97 and replaces it with the 2.8kHz bandwidth limit. 2.8kHz is already used to set the maximum bandwidth of an amateur station in the 60-meter band.
After being petitioned by ARRL, The National Association for Amateur Radio®, in 2013 (RM-11708) for the same relief, in 2016 the Commission issued a Notice of Proposed Rulemaking (WT Docket No. 16-239) in which it agreed that the HF symbol rate limit was outmoded, served no purpose, and hampered experimentation. But the Commission questioned whether any bandwidth limit was needed in its place. Most amateurs, including the ARRL, objected to there being no signal bandwidth limit in the crowded HF bands given the possibility that unreasonably wide bandwidth digital protocols could be developed, and since 2016 there has been no further FCC action.
ARRL President Rick Roderick, K5UR, hailed introduction of the bill. Roderick stated that “the FCC’s delay in removing this outdated restriction has been incomprehensible, given that the biggest effect of the delay is to require totally inefficient spectrum use on the alreadycrowded amateur HF bands. I hope that the Commission
will act to remove this harmful limitation without waiting for the bill to be passed.”
ARRL Legislative Committee Chairman John Robert Stratton, N5AUS, added that “the symbol rate limit hampers experimentation and development of more efficient HF data protocols by U.S. amateurs. For all practical purposes the field has been ceded to amateurs outside the U.S., where there is no comparable limit. Removing the restriction not only will allow U.S. amateurs to use the most efficient data protocol suitable for their purpose, but it also will promote and incentivize U.S. amateurs to experiment with and develop even more efficient protocols.”
Bill To Reduce Land Use Restrictions and Covenants
In January 2023, Ohio Congressman Bill Johnson sponsored HR-9670, the “Amateur Radio Emergency Preparedness Act.” The bill attempts to take on private land use restrictions and covenants. The bill’s intro reads, “…amateur stations have been shown to be frequently and increasingly precluded” by these unreasonable rules.
Changes included in HR-9670 include allowing antennas shorter than 1 meter, antennas part of a flagpole, and wire antennas.
If you support these changes, consider letting your congressional representative know. You can find contact information at https://www.congress.gov/members.
SOURCES
U.S. House of Representatives, D. Lesko Press Release, Lesko Introduces Bill To Protect Amateur Radio, Dec. 21, 2022, https://lesko.house.gov/news/documentsingle. aspx?DocumentID=2763#:~:text=This%20legislation%20 eliminates%20the%20Symbol,in%20the%20 60%2Dmeter%20band.
Rep. Lesko Introduces Bill to Replace Symbol Rate Limit, ARRL News, Dec. 22, 2022, http://www.arrl.org/news/ rep-lesko-introduces-bill-to-replace-symbol-rate-limit-withbandwidth-limit.
Congress Introduces Two Bills to Enhance Ham Radio
Experience, Ham Radio Prep, Jan. 7, 2023, https:// hamradioprep.com/congress-introduces-two-bills-toenhance-ham-radio-experience
PROCEEDINGS • SPRING 2023 WWW.RADIOCLUBOFAMERICA.ORG 81
INDUSTRY UPDATES
RESEARCHERS SUCCESSFULLY GROW ELECTRODES IN LIVING TISSUES
Reviewed By Emily Henderson, B.Sc., Feb 24 2023
The boundaries between biology and technology are becoming blurred. Researchers at Linköping, Lund, and Gothenburg universities in Sweden have successfully grown electrodes in living tissue using the body’s molecules as triggers. The result, published in the journal Science, paves the way for the formation of fully integrated electronic circuits in living organisms.
“FOR SEVERAL DECADES, WE HAVE TRIED TO CREATE ELECTRONICS THAT MIMIC BIOLOGY. NOW WE LET BIOLOGY CREATE THE ELECTRONICS FOR US.” -- PROFESSOR MAGNUS BERGGREN AT THE LABORATORY FOR ORGANIC ELECTRONICS, LOE, LINKÖPING UNIVERSITY.
Linking electronics to biological tissue is important to understand complex biological functions, combat diseases in the brain, and develop future interfaces between man and machine. However, conventional bioelectronics, developed in parallel with the semiconductor industry, have a fixed and static design that is difficult, if not impossible, to combine with living biological signal systems.
To bridge this gap between biology and technology, researchers have developed a method for creating soft, substrate-free, electronically conductive materials in living tissue. By injecting a gel containing enzymes as the “assembly molecules”, the researchers were able to grow electrodes in the tissue of zebrafish and medicinal leeches.
“Contact with the body’s substances changes the structure of the gel and makes it electrically conductive, which it isn’t before injection. Depending on the tissue, we can also adjust the composition of the gel to get the electrical process going,” says Xenofon Strakosas, researcher at LOE and Lund University and one of the study’s main authors. The body’s endogenous molecules are enough to trigger the formation of electrodes. There is no need for genetic modification or external signals, such as light or electrical energy, which has been necessary in previous experiments. The Swedish researchers are the first in the world to succeed in this.
Their study paves the way for a new paradigm in bioelectronics. Where it previously took implanted physical objects to start electronic processes in the body, injection of a viscous gel will be enough in the future.
In their study, the researchers further show that the method can target the electronically conducting material
to specific biological substructures and thereby create suitable interfaces for nerve stimulation. In the long term, the fabrication of fully integrated electronic circuits in living organisms may be possible.
In experiments conducted at Lund University, the team successfully achieved electrode formation in the brain, heart, and tail fins of zebrafish and around the nervous tissue of medicinal leeches. The animals were not harmed by the injected gel and were otherwise not affected by the electrode formation. One of the many challenges in these trials was to take the animals’ immune system into account. “By making smart changes to the chemistry, we were able to develop electrodes that were accepted by the brain tissue and immune system. The zebrafish is an excellent model for the study of organic electrodes in brains,” says Professor Roger Olsson at the Medical Faculty at Lund University, who also has a chemistry laboratory at the University of Gothenburg.
It was Professor Roger Olsson who took the initiative for the study, after he read about the electronic rose developed by researchers at Linköping University in 2015. One research problem, and an important difference between plants and animals, was the difference in cell structure. Whereas plants have rigid cell walls which allow for the formation of electrodes, animal cells are more like a soft mass. Creating a gel with enough structure and the right combination of substances to form electrodes in such surroundings was a challenge that took many years to solve.
“Our results open up for completely new ways of thinking about biology and electronics. We still have a range of problems to solve, but this study is a good starting point for future research,” says Hanne Biesmans, PhD student at LOE and one of the main authors.
SOURCES
News: Medical Life Sciences, https://www.news-medical. net/news/20230224/Researchers-successfully-growelectrodes-in-living-tissues.aspx
Linköping University
Journal reference: Strakosas, X., et al. (2023) Metaboliteinduced in vivo fabrication of substrate-free organic bioelectronics. Science doi.org/10.1126/science.adc9998
PROCEEDINGS • SPRING 2023 WWW.RADIOCLUBOFAMERICA.ORG 82
INDUSTRY UPDATES
NASA AND HAARP CONCLUDE ASTEROID EXPERIMENT
By Rod Boyce, University of Alaska Fairbanks, Dec. 30, 2022
A powerful transmitter in remote Alaska sent long wavelength radio signals into space Jan. 3, 2023 with the purpose of bouncing them off an asteroid to learn about its interior.
The asteroid, 2010 XC15, is estimated to be about 500 feet across and is passing by Earth at two lunar distances, which is twice the distance between the Earth and the moon.
Results of the experiment at the High-frequency Active Auroral Research Program (HAARP) research facility at Gakona could aid efforts to defend Earth from larger asteroids that could cause significant damage.

“We will be analyzing the data over the next few weeks and hope to publish the results in the coming months,” said Mark Haynes, lead investigator on the project and a radar systems engineer at NASA’s Jet Propulsion Laboratory
in Southern California. “This experiment was the first time an asteroid observation was attempted at such low frequencies.
“This shows the value of HAARP as a potential future research tool for the study of near-Earth objects,” he said. Several programs exist to quickly detect asteroids, determine their orbit and shape and image their surface, either with optical telescopes or the planetary radar of the Deep Space Network, NASA’s network of large and highly sensitive radio antennas in California, Spain and Australia. Those radar-imaging programs don’t provide information about an asteroid’s interior, however. They use signals of short wavelengths, which bounce off the surface and provide high-quality external images but don’t penetrate an object.
PROCEEDINGS • SPRING 2023 WWW.RADIOCLUBOFAMERICA.ORG 83
INDUSTRY UPDATES
A frosty landscape surrounds antennas at the High-frequency Active Auroral Research Program site in Gakona, Alaska, on Dec. 20, 2022. Credit: JR Ancheta, UAF/GI
Long wavelength radio signals can reveal the interior of objects.
HAARP, using three powerful generators, began transmitting chirping signals of long wavelength at 2 a.m. Tuesday, Jan. 3 and continued sending them uninterrupted until the scheduled end of the 12-hour experiment.
The University of New Mexico Long Wavelength Array near Socorro, New Mexico, and the Owens Valley Radio Observatory Long Wavelength Array near Bishop, California, are also involved in the experiment.

Data analysis is expected to take several weeks.
The experiment also served as a test for probing an asteroid larger than 2010 XC15.
Asteroid Apophis, discovered in 2004, will make its closest approach to Earth on April 13, 2029. It will come within about 20,000 miles of Earth, closer than the many geostationary satellites orbiting the planet.
Apophis, which NASA estimated to be about 1,100 feet across, was initially thought to pose a risk to Earth in 2068, but its orbit has since been better projected by researchers and is now not a risk to the planet for at least a century.
This experiment follows tests in January and October 2022 in which scientists bounced long-wavelength signals off the moon in preparation for the January 3, 2023 experiment.
Haynes said understanding the makeup of an asteroid’s interior, especially of an asteroid large enough to cause major damage on Earth, can increase the chances of an effective defense. Knowing the distribution of mass within a dangerous asteroid could help scientists target devices designed to deflect an asteroid away from Earth.
Amateur scientists from around the world reported receiving the outgoing transmission, said Jessica Matthews, HAARP’s program manager. The reports will help infer the conditions of the ionosphere during the experiment.
“Our collaboration with JPL is not only an opportunity to do great science but also involves the global community of citizen scientists,” she said. “So far we have received over 300 reception reports from the amateur radio and radio astronomy communities from six continents who confirmed the HAARP transmission.”


The University of Alaska Fairbanks (UAF) operates HAARP under an agreement with the Air Force, which developed and owned HAARP but transferred the research instruments to UAF in August 2015.
SOURCES
Phys.org and University of Alaska Fairbank, https://phys. org/news/2022-12-nasa-haarp-asteroid.html
PROCEEDINGS • SPRING 2023 WWW.RADIOCLUBOFAMERICA.ORG 84
Showcasing Sparks of Genius in Communications Technology” 200 years of Electronic Communication Technologies History: For Future Generations • Preserving • Historical Research • Sharing • Education Visit the world renowned Antique Wireless Museum in Bloomfield, NY near Rochester AWA cordially invites RCA members to join AWA: save with an affinity membership at www.antiquewireless.org/joinrenew www.facebook.com/antiquewirelessmuseum AWA Twitter handle is @antiquewireless AWA YouTube Channel: https://www.youtube.com/channel/UCX55peBhzeX1qps_VYXdLBA
“
MILLIMETER WAVE RADAR SYSTEM KEEPS
DRIVERS SAFE
ON
THE
ROAD –THIS STARTUP’S SENSOR CHECKS VITAL SIGNS TO DETECT IMPAIRED DRIVING
By Joanna Goodrich, Mar. 23, 2023
[This article is reprinted courtesy of IEEE, an RCA Partner Organization]
A new sensor could help reduce the number of accidents caused by impaired driving and could protect children left in hot cars. The Wireless Intelligent Sensing millimeterwave radar system, developed by startup Pontosense, monitors vehicle occupants’ vital signs, and it can detect the presence of passengers in the vehicle and where they are seated.
The WISe system measures the driver’s vital signs including heart rate and breathing to detect fatigue and possible medical emergencies. WISe sends out signals with wavelengths short enough to measure the tiny adjustments in a person’s body from breathing and pulse. The signal echo is then analyzed by an artificial intelligence (AI) algorithm.

“There is an urgent need for this kind of technology,” says cofounder Alex S. Qi, the startup’s CEO. A recent study on the causes of motor vehicle accidents found that fatigue and medical emergencies were the top reasons.
WISe is the first in-market millimeter-wave wireless sensor used for that purpose in the automotive industry, Qi says. The system is expected to be installed in several vehicle models in the near future, he says.
MONITORING DRIVERS TO MAKE ROADS SAFER
Current in-car driver-monitoring systems require either cameras or contact sensors, but WISe works wirelessly. The system uses RF sensing to capture echos of the micromovements made by the driver’s or passenger’s body caused by heartbeats and breaths. WISe detects changes in the reflected signal’s phase—the relationship between radio signals that share the same space and frequency—to read the micromovements and vital signs.
“Think of the sensor as bouncing waves off of something, like how whales and bats use sonar and echolocation to gauge where objects are located around them. That’s the basis of our technology,” Qi says.
The sensor transmits millimeter waves from an antenna designed by cofounder and CTO Yihong Qi (Alex and Yihong are related). When the waves are reflected back to the sensor, the received echo allows WISe to “see” the small movements and gather data about the person’s health status.
The system checks heart rate variability and respiration rate. WISe takes the driver’s readings daily to discern what the person’s normal range is and displays the data on the car’s infotainment screen. The information is also stored in a microcomputer in the vehicle as well as external servers so it can be accessed later. The system is encrypted to protect the driver’s personal data from hackers.
The sensors can be installed in different locations in the vehicle, including behind the rearview mirror, behind the instrument panel, and between the driver and passenger seats. The device—about the size of a coin, with a 40-millimeter diameter—uses less than 10 milliwatts of power.
The antenna Yihong designed is 10 millimeters to keep the sensor small and flexible, he says. It can transmit millimeter
PROCEEDINGS • SPRING 2023 WWW.RADIOCLUBOFAMERICA.ORG 85
INDUSTRY UPDATES
The WISe system measures the driver’s vital signs including heart rate and breathing to detect fatigue and possible medical emergencies. The readings are displayed on the car’s infotainment screen. (Courtesy PONTOSENSE)
waves at 24, 60, or 77 gigahertz, depending on the vehicle.
“The wavelength at a higher frequency is very short,” Yihong says, “so the sensor is able to more accurately read the driver’s movements.”
The biggest challenge during the sensor’s development, Yihong says, was figuring out how to filter out external noise to ensure accurate readings.
“Take heart rate variability, for example,” he says. “In the hospital, when a patient is having their heart rate measured, sensors are directly attached to them for an accurate reading. But a contactless wireless sensor needs extra help because noises in the environment—such as seatbelts, the car’s engine, and even breathing—are affecting the sensor’s ability to differentiate between the person’s heart rate and irrelevant noise.”
To filter out the noise, Yihong developed signal processing software that uses AI to analyze the data. Algorithms clean up the data, generating a clear radar image for biometrics and communicating with the vehicle and the infotainment system if it suspects an issue with the driver or a passenger. The company says it takes 5 to 10 seconds for WISe to detect a change in the driver, such as an irregular heartbeat, and notify the vehicle.
Each car manufacturer will use a different system for alerting the driver if the measurements deviate from the norm, Alex says. It could involve setting off an alarm, slowing down the car or, for autonomous cars, safely pulling over to the side of the road.
The driver can override the system, the company says, if the alert is incorrect or unnecessary.
PROTECTING AGAINST ACCIDENTAL DEATHS
The current way to count the number of passengers in a car is through pressure sensors installed under each seat. But sometimes a sensor is inaccurate because it was triggered by a heavy object such as luggage. Pressure sensors also can fail to count children weighing less than 29 kilograms, according to a 2020 article published in IEEE Access.
Compared with a pressure sensor, WISe can more accurately differentiate whether a passenger is an adult, child, or pet through vital signs and size.
Determining a passenger’s size also matters for airbag deployment. After a crash, airbags eject out of the steering wheel, dashboard, or another location at about 27 kilometers per hour, according to the Insurance Institute for Highway Safety. People who weigh less than 68 kg or are shorter than 1.5 meters can be killed or severely injured because of the airbag’s deployment speed, Alex says. But WISe can communicate to the car to slow down the bag’s deployment by notifying the vehicle that a passenger doesn’t meet the minimum requirements.
The system can also warn whether children or pets have been left in the rear seat by reading their vitals. That could prevent heat stroke or death for those left behind in a hot vehicle. WISe can tell the vehicle to open windows or turn on an alarm to notify those in the area of a forgotten child or pet while the car is not running.
“In-cabin sensing will enable personalized, humancentered enhanced in-car experiences,” Yihong says.

DEVELOPING A HYPERINTELLIGENT WIRELESS SENSOR
The idea for Pontosense came about while Yihong and Alex were walking the showroom floor at the 2019 Consumer Electronics Show in Las Vegas.
“We saw many companies showcasing devices that could measure vital signs, but all needed two or more sensors to work, were invasive, and were not user-friendly,” Alex says. “They also relied on Wi-Fi.”
“The sensors used low-frequency bandwidth, which couldn’t make accurate readings,” Yihong adds. “They only detected a person if they walked one meter out in front of the sensor, and they couldn’t differentiate between multiple people in a group.”
Yihong’s work in antenna development, radio frequency and electromagnetic compatibility measurement, and digital signal processing algorithms spans decades. An IEEE Fellow, he holds more than 500 patents in China and the United States.
He started to think about how to make a more accurate, more user-friendly, wireless intelligent sensing device. By the time the trade show ended, he already had several ideas. The two decided to team up and develop a technology to be used in cars.
“Both of us have experienced driving while tired, and we thought a sensor would be a great tool to help decrease the number of accidents caused by impaired driving,” Alex says. He adds that they also wanted to reduce the number of deaths caused when people accidently leave a young child behind in a car on a hot day.
PROCEEDINGS • SPRING 2023 WWW.RADIOCLUBOFAMERICA.ORG 86
WISe can detect the presence of passengers in the vehicle and where they are seated. (Courtesy PONTOSENSE)
They succeeded in creating the wireless sensor in 2021 and founded Pontosense that year to bring the system to market. The startup, based in Toronto, employs more than 120 people, 25 of whom are on its research and development team.

Pontosense received an IEEE Hyper-Intelligence Technical Committee Award for Excellence in Hyper-Intelligence last year for “contributions on wireless intelligent sensing systems for human safety in automobiles,” in the industrial impact category.
Hyperintelligence uses interdisciplinary technologies that work together to accomplish complex tasks. The award is sponsored by the IEEE Sensors Council
BENEFITING FROM OTHER TECHNOLOGY STARTUPS
Pontosense participated in VentureLab’s capital investment program in 2021. The program helps participants write pitches, connect with investors, and develop long-term capital strategies. But raising funds wasn’t difficult, Alex says, as Pontosense isn’t his or Yihong’s first company. They’ve founded several other startups, which helped pave the way for the development and manufacturing of the
sensors. Their companies include wireless communication device manufacturers Mercku and General Test Systems
“We have the privilege to be able to mass-produce WISe with our network of companies,” Alex says. “Pontosense can produce hundreds of thousands of modules a month. Our goal for this year is to get the device in as many vehicles as possible so we can save as many lives as possible.”
AUTHOR
Joanna Goodrich is the associate editor of The Institute, covering the work and accomplishments of IEEE members and IEEE and technology-related events.

SOURCE
IEEE Spectrum, The Institute, Mar, 23, 2023, https:// spectrum.ieee.org/millimeter-wave-radar-system-cars
PROCEEDINGS • SPRING 2023 WWW.RADIOCLUBOFAMERICA.ORG 87
Save the Date! 2023 Technical Symposium and 114th Awards Banquet SATURDAY, NOVEMBER 18, 2023 | DENVER, COLORADO
SOUND WAVES PROPAGATING IN ONE DIRECTION BREAK LIGHT TRANSMISSION RECIPROCITY
By Sally Cole Johnson
Max Planck Institute for the Science of Light researchers in Germany created a light-driven optical vortex isolator—with potential for selective manipulation of vortex modes solely by light and sound waves.

A team of Max Planck researchers, led by Xinglin Zeng, Philip Russell, and Birgit Stiller, built an optical vortex insulator using sound waves that propagate only in one direction to break the light transmission reciprocity for chosen vortex modes.

This advance significantly boosts the signal quality and purity of optical vortices—signals transmitted in optical communications—and has potential applications in optical systems such as mode-division-multiplexed communications, optical tweezers, vortex lasers, or quantum manipulation systems.
“Information can be encoded in different properties of light, such as the wavelength, in phase and amplitude, but also in polarization and orbital angular momentum (OAM),” says Stiller, who leads the Quantum Optoacoustics Research Group (see Fig. 1). “The latter two can be studied very conveniently in chiral optical fibers. We’re interested in how light with different polarization and orbital angular momentum interacts with sound waves and how this interaction can be leveraged.”
OPTICAL COMMUNICATIONS OF THE FUTURE
Optical communications can be improved by increasing the amount of optical information transmitted. And this can be accomplished via multiplexed channels, such as using many optical wavelengths, different polarization states, or multiple time slots.
During the past decade, optical spatial modes—eigenfields in the waveguides—were widely exploited to further improve the communication capacity, thanks to little crosstalk between orthogonal spatial modes.
For classical and quantum communications, the use of vortex modes in multiplexing methods is advantageous. This special mode set possesses a helical optical phase distribution, which provides an additional degree of freedom for multiplexing optical signals.
OUTMANEUVERING RECIPROCITY
When developing their device, the team had to work around a fundamental principle of optics: reciprocity. This requires a symmetrical response of a transmission control channel when the source and observation points are interchanged. The team’s device is by design nonreciprocal—it’s based on light-sound interactions within a spiral optical
PROCEEDINGS • SPRING 2023 WWW.RADIOCLUBOFAMERICA.ORG 88
INDUSTRY UPDATES
Fig. 1. Bergit Stiller and Xinglin Zeng in the lab.
Fig. 2. Fiber coupling system for nonreciprocal light-sound interactions
fiber to naturally break the reciprocity of the light waves propagating forth and back (see Fig. 2).
The team taps into a nonlinear interaction, Brillouin scattering, which describes light scattering from traveling acoustic waves. “As the sound waves travel in one direction, they naturally enable nonreciprocal behavior,” she says. “We studied this property for OAM modes in optical fibers and it led us to the first nonreciprocal device for OAM modes.”
While OAM research has been ongoing for about three decades, Stiller points out there aren’t many approaches that can achieve nonreciprocal propagation for OAM modes—especially not ones to selectively act on a certain set of fiber modes.
“Research in Brillouin scattering is also quite old, but so far optoacoustic interactions with OAM modes haven’t been studied and used for applications,” she says. “In our work, we combined them and were able to show light-sound interactions for OAM modes and demonstrate
a nonreciprocal device acting as an isolator or one-way amplifier.”
The first nonreciprocal system for vortex modes “opens up a new perspective in nonreciprocal optics—the same physical effect can happen not only on the fundamental modes, but also on higher-order modes,” says Zeng, a postdoctoral researcher.
Now, the team is exploring “more exotic sound waves with an unusual structure and we want to study their interaction with light in chiral optical fibers,” says Stiller.
SOURCES
Laserfocus World, Fiber Optics, Dec. 12, 2022, https:// www.laserfocusworld.com/fiber-optics/article/14286781/ sound-waves-propagating-in-one-direction-break-lighttransmission-reciprocity
X. Zeng et al., Sci. Adv., 8, 42 (2022); doi:10.1126/sciadv. abq6064.
TESTING FOR COEXISTENCE IN CROWDED AND CONTESTED RF ENVIRONMENTS
[EDITOR’S NOTE: In 2017, Dr. Ulrich Rohde, N1UL, received the Radio Club of America’s Lifetime Achievement Award for significant achievements and a major body of work accomplished over a lifetime that has advanced the art and science of radio and wireless technology. Dr. Rohde is a partner in Rohde & Schwarz.]
In April 2023, Rohde and Schwarz released a White Paper presenting some of the key research, development, test and evaluation (RDT&E) challenges that arise when developing and deploying systems that need to operate in congested and/or contested RF environments.

The authors, Tim Fountain and Darren McCarthey, review some of the key research, development, test and evaluation (RDT&E) challenges that arise when developing and deploying systems that need to operate in congested and/or contested RF environments.
They discuss the key issues facing coexistence, such as a contested and congested spectrum, spectral sensing, spectrum sharing and dynamic spectrum allocation. They review some real-world examples of coexistence challenges such as C band 5G LTE with aircraft radar altimeters and GPS interference with spectrally co-located satellite-based communications.
The White Paper concludes with an overview of the characteristics and architectures of test systems that are
used to create realistic RF environments for testing systems under real-world operational conditions in a controlled laboratory environment.
SOURCE
Rohde & Schwarz White Paper, Version 01.00, Tim Fountain and Darren McCarthey, https://www.rfglobalnet. com/doc/testing-for-coexistence-in-crowded-and-contestedrf-environments-0001
PROCEEDINGS • SPRING 2023 WWW.RADIOCLUBOFAMERICA.ORG 89
ROHDE & SCHWARZ RELEASES WHITE PAPER:
PHYSICISTS PERFORM FIRST MEASUREMENT OF ‘TIME REFLECTION’ IN MICROWAVES
By Edwin Cartlidge
Physicists in the U.S. have observed an effect known as time reflection in an electromagnetic wave for the first time. They detected the phenomenon – the temporal counterpart of familiar spatial reflection – by rapidly switching a series of capacitors in a novel type of metamaterial. They say the result could improve wireless communication and ultimately help bring about long-sought-after optical computing. Everyday reflection involves the transformation of a wavepacket when it meets an interface in a distinct region of space. The process preserves temporal ordering, so that the leading part of the incident wave remains ahead after reflection. This means that objects further from a mirror look more distant in the reflection, while sounds in an echo arrive back in the same order they were emitted. Time reflection instead involves a wavepacket being transformed as a result of an abrupt change in time that applies equally throughout the medium it is traversing. In other words, the material in question experiences a sudden shift in its properties. This causes the wave to switch direction such that its trailing edge prior to reflection is now at the front. Objects nearer a mirror in the real world would look further away in the reflection, while for an echo the last sound emitted would become the first to arrive back.
The two processes conserve different quantities. A wave bouncing off an object transfers momentum to that object while its frequency is conserved. In contrast, a wave reflected in time must preserve momentum, causing a change in the speed with which it oscillates (its frequency). In other words, the reflected wave maintains its shape but is stretched out in time.
To date, scientists have only observed such temporal reflections in water waves. Seeing the same thing in electromagnetic radiation is complicated by the high frequency of the waves. The trick involves being able to switch a material’s refractive index uniformly at a high enough speed – taking much less time than the wave period – and with a great enough contrast so as to generate a measurable effect.
TIME TO REFLECT
Andrea Alù and colleagues at the City University of New York have now succeeded in doing that by devising a new kind of metamaterial. Metamaterials have striking
electromagnetic properties, thanks to their large numbers of tiny, precisely arranged engineered structures.
The material in question consists of a 6 m-long strip of metal serving as a microwave waveguide that snakes back and forth 20 times to form a device some 30 cm2. Thirty capacitive circuits are positioned at regular intervals along the length of the strip but separated from it by switches. The idea is to inject a train of microwave pulses and then switch all the circuits on or off at the same time while the pulses are in transit along the strip – causing a sudden change in the metamaterial’s effective refractive index and impedance. That sudden change temporally reflects the microwave signal.
Alù and colleagues were able to double (or halve) the refractive index in far less time than it took the wave to complete a single oscillation, thanks to their switching circuitry taking a short cut across the snaking waveguide. Injecting a signal consisting of two unequally strong peaks and then connecting the capacitive circuits, they found that a part of the signal arrived back at the input port with the peaks in reverse order and stretched out in time – just as would be expected for a time-reflected wave. The rest of the signal instead returned to the port with the two peaks in their original order, having spatially reflected off the far end of the metamaterial.

PROCEEDINGS • SPRING 2023 WWW.RADIOCLUBOFAMERICA.ORG 90
INDUSTRY UPDATES
On reflection: illustration of the experimental platform used to realize time reflections. (Courtesy: Andrea Alù)
According to Alù, the analogue nature of this time reversal mechanism could lead to a number of applications. For example, he says, it might be used to combat distortion in a wireless data channel. Such distortion is often estimated by a receiver station sending back known signals to the transmitter with their temporal profiles reversed. But this usually involves digitising the signals. With time reflections being instead entirely analogue, he says that their use could save time, energy and memory.
“RADIO ENGINEERS MAY SAY THAT THEY HAVE A NEW INSTRUMENT IN THEIR TOOLBOX.” - SIMONE ZANOTTO
In the longer term, he says, the scheme might find use in a new generation of analogue optical computers. As he points out, time and energy are sacrificed in current computers as a result of having to convert analogue electrical signals to and from the digital domain. But it turns out that one type of analogue operation that is particularly useful for signal processing and computing is phase conjugation – the transformation that takes place when waves undergo time reflection.
Before this can happen, Alù and his colleagues will try and shrink their metamaterial as far as possible. He says they are currently working on a chip-scale version that would operate at much higher frequencies – in the tens of gigahertz range, rather than the hundreds of megahertz of their current device. They might conceivably get to terahertz and beyond, he says, although at that point they would have to use laser pulses rather than electrical switches.
Chen Shen of Rowan University in the US, who was not involved with the work, reckons that the ability to control the spectra of radio waves could enable applications such as time-reversal medical imaging, temporal cloaking (a counterpart to spatial cloaking) and better estimating channel numbers in wireless communication. “These demonstrations show that time modulation can be added as a new ingredient for wave manipulation,” he says.
Simone Zanotto of the Scuola Normale Superiore in Pisa, Italy, agrees. “Radio engineers may say that they have a new instrument in their toolbox,” he says. “An instrument whose operating principle is well understood and probably further tuneable upon their needs.”
The research is published in Nature Physics.
SOURCE
PhysicsWorld.org, Mar. 17, 2023, https://physicsworld. com/a/physicists-perform-first-ever-measurement-of-timereflection-in-microwaves/#:~:text=Physicists%20in%20 the%20US%20have,a%20novel%20type%20of%20 metamaterial
DONOR GIFT: COMMEMORATIVE CODE PRACTICE OSCILLATOR
We all know that students today are often more interested in computers than wireless. As a result, the future of wireless depends on getting more youth interestesd in wireless.
Here is a great opportunity to support our RCA Youth Program under Director Carole Perry and obtain a free gift as a result. Carole has been driving our Youth Program for 30 years this year! As a surprise to her, Director Charles Kirmuss commissioned a CW Morse code practice oscillator that was the same design Carole used years before with her early amateur radio classes with middle school and high school.
If you donate at least $30 to Carole's RCA Youth Program, you will receive a commemorative code practice oscillator. Your donation will be used to assist with costs like awards to the children, donation materials for school radio clubs, travel expenses for youth presenters to the Technical Symposium, and more.

In addition, if you renew your RCA membership for three years, you will also receive a code practice oscillator.
If you have interest in donating to the Youth Program, please email Director Carole Perry directly (wb2mgp@gmail.com) and she will provide instructions as to how to send a check.
If you wish to renew your membership for three years, contact Amy Beckham (Amy@radioclubofAmerica.org) for details on getting the code practice oscillator.
PROCEEDINGS • SPRING 2023 WWW.RADIOCLUBOFAMERICA.ORG 91
Radio Club of America Recognizes Women of Achievement in the Wireless Industry
Join this webinar series and meet women leading the way and breaking glass ceilings in the wireless industry. This series, along with occasional live activities, provides an opportunity to learn from these innovative women who pioneered the profession and who are paving the way for those to come. The wireless industry has long been a male-dominated field, but that doesn’t mean that women haven’t made significant contributions to it. Women have made remarkable strides in this field, and it’s essential to celebrate their achievements.
RCA PROMOTES WOMEN’S ACCOMPLISHMENTS
The wireless industry has grown rapidly in recent years, with new advancements in technology and innovation. It’s been an exciting time for everyone involved in the industry, and women have been at the forefront of many of these advancements. They work tirelessly to make a difference in the wireless world, and their efforts do not go unnoticed. RCA has long recognized and promoted women’s achievements in wireless. We are fortunate to have had many strong women on our board in addition to those who served as officers and as president of RCA. We are proud of our association with these accomplished women, and we celebrate their achievements as we also encourage the future leaders of this industry.
• One of RCA’s primary founders was E. Lillian Todd, a selftaught inventor known for her early aero plane research at the dawn of the 20th century. She sponsored and mentored a group of teenage boys to learn about science, experimentation, and wireless. Those boys founded the Junior Aeronautical Club in 1909 that was renamed as RCA in 1911.
• Mercy Contreras, a widely known leader in wireless media publications and RCA Fellow, was the first female officer in RCA and later served as RCA’s first female president.
• Former RCA president and Fellow Vivian Carr was a pioneer who broke the glass ceilings at Bell Laboratories, AT&T, and IEEE serving as the first female president of the New York Section. She is the namesake of RCA’s award for female leadership in the industry, the Vivian Carr Award.
RCA is proud to feature a roster of notable women who are contributing their talents to the wireless industry on our website as Women of Achievement, including:
• Dr. Maha Achour – founder, CEO, and CTO of Metawave
• Emily Calandrelli – known as The Space Gal, host and producer of Wonderlab on Netflix, former host, and producer of Xploration Station, a correspondent on Bill Nye Saves the World, and recipient of RCA’s Vivian A. Carr Award
• Anne Chow – President, AT&T Business
• Mercy Contreras – widely known leader in wireless media publications, an RCA Fellow, the first female officer in RCA, and RCA’s first female president, and recipient of RCA’s Vivian A. Carr Award
• Mary Cotton – CEO of FT iDirect
• Kay Craigie, N3KN – former ARRL President
• Dr. Katherine J. Duncan – 2021 President of IEEE-USA
• Limor Fried, AC2SN – founder of Adafruit
• Dr. Andrea Goldsmith – Stanford professor, the first woman to win the Marconi Prize since its inauguration in 1975
• Jenean Hampton, K5EIB – Lieutenant Governor of Kentucky and a licensed radio amateur
• Arlene Joy Harris – known as the “First Lady of Wireless,” a serial entrepreneur, inventor, investor, and policy advocate, a Fellow and the first recipient of RCA’s Wireless Innovation Award
• Paulla Nelson-Shira – founder, owner, and group publisher of RadioResource Media Group and an RCA Fellow
• Ellen O’Hara – former president and COO, EF Johnson, and president, Zetron, and recipient of the 2022 RCA Special Services Award for her dedication to volunteering with RCA.
• Daniela Perdomo – co-founder and CEO of goTenna
• Dr. Ada Poon – associate professor of electrical engineering at Stanford University
• Dr. Maryam Rofougaran – holds more than 250 patents and is the co-CEO and founder of Movandi Corporation
• Martine Rothblatt – co-founder of Sirius Satellite Radio
• Kate Scott – the first woman to ever call a regular-season NBA game
• Susan Stamberg – NPR news broadcaster, the first woman to ever anchor a nightly news program
• Susan Swenson – chair of the FirstNet board of directors
PROCEEDINGS • SPRING 2023 WWW.RADIOCLUBOFAMERICA.ORG 92
RCA NEWS
• Dr. Gladys West – the woman who made GPS possible
• Dr. Mary Ann Weitnauer – senior associate chair at Georgia Tech’s School of Electrical and Computer Engineering (ECE), and an RCA Fellow and recipient of RCA’s Vivian A. Carr Award

• Kathy Winter – general manager at Intel
FIRST YEAR PROGRAMS
The inaugural Women in Wireless program featured Ellen O’Hara as facilitator. It was an impressive group of women who gathered for the first session of Women in Wireless. Time was spent talking about the hopes and plans for this new series, and introductions were made by everyone. What a diverse cross-section of professional women! Everyone walked away with a positive outlook for the future of this program.
The two following sessions saw engagement on many levels. It was inspiring to hear from those with career aspirations, asking for advice and guidance from more seasoned women in the group. The recognition that this is the future of the industry right in this group, and that support, mentorship, and connections as well as laughter, newfound friendships, and future plans all coalesced to form the groundwork of an ongoing initiative is truly incredible.
APRIL 2023’S PROGRAM – CHERYL GIGGETTS
2023 marks the second year of RCA’s Women in Wireless sessions. This year we plan to bring inspiring women to you on a quarterly basis. In April, we hosted RCA Fellow Cheryl Giggetts. Cheryl has 37 years of experience in management, and 33 years of experience in the Wireless Telecommunications Industry, specializing in Public Safety Communications and E-911 Services for local, state, and federal government.
After working over 15 years in national A&E practice and 10 years in global A&E practice, she founded CTA Consultants where she serves as Principal Consultant on city/county systems, multi-jurisdictional regional systems, and statewide systems across the United States.
CTA’s primary mission is Communications Technology Advancement in public safety and Science, Technology, Engineering, and Mathematics (STEM) education. CTA team members execute this mission by giving their time personally and professionally to the public safety community and
STEM initiatives. CTA corporately executes this mission by investing 100% of our net profits, over the life of the firm, to first responder essential training and STEM education initiatives that encourage future innovation.
Cheryl generously gives her time to many organizations, and RCA is also pleased to have her participation as a Mentor in the new Mentorship program that was launched in 2022. During our April 26 session, Cheryl shared the challenges and successes of starting her own business, and viewers learned about her corporate ethos of giving back and paying it forward. Very inspiring for all!
PLANS FOR 2023 AND BEYOND
RCA’s Women in Wireless program is one of our most active programs, and the interview series has blossomed into live events, networking, and other activities. All are welcome to attend these programs, but the focus is on women. RCA welcomes ideas and suggestions for the program.
Activities for 2023 are still being organized, but some plans include three more sessions with fascinating industry leaders, opportunities for connection at APCO in August, as well as a presence at MTUG, and more opportunities to include WISPALOOZA in October.
RCA is fortunate to participate in a collaborative of organizations with the aim of supporting and empowering women in wireless, and would like to thank for the following organization representatives for their support:

• Julie McDillon, Motorola
• Montana Watts, AT&T FirstNet
• Elliott Linke, Ford County KS Emergency Communications
• Jennifer Lisaius, WISPA
• Scott Wright, CT Department of Emergency Services
If you or woman in your organization is interested in participating, have them email Amy Beckham to be put on the outreach list at Amy@radioclubofamerica.org.
ABOUT THE AUTHOR
Amy Beckham is the Administrative Director of the Radio Club of America. She is President / CEO of The Sapphyre Group, LLC an association management and event planning organization that works with trade and professional associations nationwide.

PROCEEDINGS • SPRING 2023 WWW.RADIOCLUBOFAMERICA.ORG 93
Cheryl Giggetts, presenter at RCA’s April Women in Wireless program.
2023 Hamvention Technical Achievement Award Will Be Made to RCA Fellow, Dr. James Breakall
The 2023 Hamvention Technical Achievement Award recipient is Dr. James Breakall, WA3FET, whose work has been instrumental in amateur radio antenna technology for decades. He has teamed with many experts in the field to develop state-of-the-art advancements with a wide range of applications, including the Numerical Electromagnetics Code (NEC). As a professor of electrical engineering at Penn State University from 1989 to 2022, Dr. Breakall developed cutting-edge antenna technology and mentored his students in amateur radio, resulting in 700 new licensees. Now a retired Professor Emeritus, he serves as a consultant to the U.S. Army, Air Force, and Navy on many antenna-related projects.
Nittany Scientific, a company initiated with his students, developed some of the first optimization methods applied to NEC in a package called NECOPT, a design he called Optimized Wideband Antenna (OWA) Yagi. The goals of the optimization were minimum peak SWR in a band, maximizing the lowest gain in a band, and maximizing the minimum front-to-back ratio in a band. These OWA Yagi designs have been used in numerous contest and DX stations around the world. Because Breakall wanted this technology to be readily available worldwide, he has never pursued patent licensing. He was also the first to use helicopter measurements and Geometrical Theory of Diffraction (GTD) techniques for antennas in terrain at HF that led to software such as TA and HFTA.
In 2010, Dr. Breakall collaborated with Dr. Joe Taylor, K1JT, Angel Vazquez, WP3R, and Pedro Piza, Jr., NP4A, to use the Arecibo Observatory’s 1000-foot dish for EME for Moonbounce communication. He worked on many antenna designs at Arecibo Observatory in Puerto Rico and at the High-frequency Active Auroral Research Program (HAARP) facility in Alaska.
Dr. Breakall has frequently presented at Hamvention forums to share his expertise on antenna design and enthusiasm for amateur radio. As an avid amateur radio contester, Dr. Breakall has built contest stations in Pennsylvania and Puerto Rico, and he has participated in more than 100 contests; he has also won a fair amount of them. Dr. Breakall has authored numerous peer-reviewed scientific articles and books. The Technical Achievement Award will be presented at Hamvention, May 19-21, 2023.
Dr. Breakall has been a member of RCA since 2015 and is a Fellow. Since 2016, he has served on RCA’s Board of Directors. He also serves as chair of the RCA Technical Symposium and on the RCA Education and Scholarship Committee. He was previously honored as one of RCA’s Wireless Pioneers, which recognizes “giants in the industry” and their accomplishments.

PROCEEDINGS • SPRING 2023 WWW.RADIOCLUBOFAMERICA.ORG 94
RCA NEWS
Dr. Jim Breakall from PennState University.
TMA Honors RCA Member Louis T. Fiore’s Lifetime Contribution with Everlasting Scholarship

On Dec. 7, 2022, The Monitoring Association’s (TMA) President Morgan Hertel announced the establishment of the Louis T. Fiore Electronic Communications Scholarship. The new scholarship was established on Oct. 31 during TMA’s Annual General Business Meeting. The scholarship honors Mr. Fiore’s enduring contribution to the alarm industry and the Alarm Industry Communications Committee (AICC), and it is intended to promote careers in electronic communications.
“How do you recognize someone who’s given his heart and soul for more than 30 years to an organization?” asked President Hertel when introducing the new scholarship.
“Lou has served the alarm industry in many capacities. We wanted to honor his immeasurable contributions in an everlasting manner to make certain he and his work is never forgotten.” The room rose with a standing ovation as Fiore approached the stage to accept a small token of recognition from President Hertel.
“I am honored. As chair of the AICC for 30 years, I worked hard to make certain the Committee and its members thrived. The work was very close to my heart. Thank you very much. This is incredible,” stated Fiore in his acceptance comments.
The scholarship is open to anyone studying electrical engineering, specifically electronic communications, or software development related to electronic communications, regardless of financial need. Students at any nationally accredited educational institution, including vocational schools, two-year colleges, or other institutions of higher learning are eligible. For more information on this scholarship, including donating, please visit TMA’s website Louis Fiore is a long-time member and Fellow of the Radio Club of America. He has more than 45 years of experience in the industry and is a pioneer in alarm communications. He is the former president of Central Station Alarm Association (CSAA) and the former chairman of Security Industry Association (SIA) Standards Committee. He has been active on numerous National Fire Protection Association (NFPA) committees for many years. He is a member of International Association of Chiefs of Police (IACP) and served on the Communications and Technology Committee and numerous UL Standards Technical Panels (STPs). He has received numerous awards for his contributions to the industry.
The Monitoring Association (TMA), formerly the Central Station Alarm Association (CSAA), is an internationally recognized non-profit trade association that represents professional monitoring companies, security systems integrators, and providers of products and services to the industry. Incorporated in 1950, TMA is legally entitled to represent its members before Congress and regulatory agencies on the local, state and federal levels, and other authorities having jurisdiction (AHJs) over the industry. Learn more online at https://tma.us/about-tma/. Additional information can be obtained from: Leigh A. McGuire, Director of Marketing and Communications, TMA, lmcguire@ tma.us, +1.703.660.4916.

RADIO CLUB OF AMERICA
INTERVIEW SERIES
RCA president emeritus John Facella hosts, and each interview runs approximately 1 hour. The interviews are alternated with online RCA networking sessions. Past guests have included a range of notables:
Discussions center on careers in wireless, life-long passion for radio, views on industry trends and outlooks for technology, and on the current work the guests are undertaking as well as their history with RCA. If you missed any of these interviews, they are available on the RCA Youtube page at https://bit. ly/3tjFooc.
RCA plans many more of these exciting virtual activities. Please see https://bit.ly/3tmrJgb for further announcements.
PROCEEDINGS • SPRING 2023 WWW.RADIOCLUBOFAMERICA.ORG 95
RCA NEWS
Radio Club of America (RCA) Announces New Carole Perry RCA Young Professional Award
On Dec. 14, 2022, the Radio Club of America announced at its annual Awards Banquet in Atlanta a major new award: The Carole Perry RCA Young Professional Award.
This award is for those students, previously in middle or high school, who became Carole Perry RCA Young Achievers and who presented at RCA’s annual Technical Symposium. If they then go on to college, or go into the wireless industry, and subsequently present again at an RCA Technical Symposium, they will be nominated to receive this award.
Former RCA President John Facella said “The objective of this award is to encourage middle and high school students to go on to study wireless related subjects, and then work in the wireless industry. It is well known that there is a major shortage of qualified people to work in the wireless industry. This is one way to help alleviate that shortage.”
Current RCA President David Bart said “RCA Director and Fellow Carole Perry for over 30 years has been a consistent
positive force within RCA to get middle and high school students interested in STEM (science, technology, engineering, math) and wireless subjects. This award in her name will properly commemorate all of Carole’s work and provide an incentive for these students to stay in wireless.”

Nominations for awardees to these and all the other RCA awards can be made in the spring of 2023. A list of all the wireless industry awards and the nomination forms can be found at https://www.radioclubofamerica.org/AwardsFellows.
For additional information, contact Amy Beckham at 612.405.2012, amy@radioclubofamerica.org.
RCA Releases Video Interview with Dr. Martin Cooper on the 50th Anniversary of his Historical Cell Phone Call

On April 3, 2023, the Radio Club of America released its interview with Dr. Marty Cooper, which was recorded on March 14, 2023.
Dr. Cooper is an American engineer and a pioneer in the wireless communications industry, especially in radio spectrum management. He holds eleven patents. On April 3, 1973, he publicly demonstrated the first mobile telephone call from a handheld portable phone while working with Motorola. He is considered to be the father of the handheld cell phone.
Dr. Cooper is the recipient of the 2010 RCA Lifetime Achievement Award, 1996 RCA Fred M. Link Award, and was elevated to RCA Fellow in 1981. He has received the Marconi Prize and numerous other recognitions for his accomplishments.
RCA President David Bart says “We are thrilled to present this recorded conversation with Dr. Cooper! He is truly a legend in the wireless industry. His invention of the mobile phone changed the world by altering the personal electronic communication paradigm from being associated with fixed positions to convenient mobile telephony. We are grateful for the World’s First Handheld Portable Phone Call.”
The video interview can be found on the RCA YouTube Channel. An edited transcript of the interview appears in the spring 2023 issue of the RCA Proceedings.
PROCEEDINGS • SPRING 2023 WWW.RADIOCLUBOFAMERICA.ORG 96
RCA NEWS
OF AMERICA
RADIO CLUB
Dr. Marty Cooper.
Update On Youth Activities
HAMCATION 2023 EDUCATOR OF THE YEAR AWARD
On February 9, 2019, the Orlando Hamcation hosted a ceremony for its presentation of the first Carole Perry Educator of the Year Award. The award was named in honor of longtime Radio Club of America educator, Carole Perry, in recognition of her leadership and outreach to youth using Amateur Radio as an educational and inspirational tool. The award is given out annually to someone who is dedicated to educating and advancing today’s youth about Amateur Radio.

The 2023 Educator of the Year Award was presented to Jim Storms, AB8YK, Chairman of the 2023 Hamvention. Jim is a member of RCA, a long time educator of technical youth groups, and one of the co-founders of the David Kalter YDXA, a group that brings young hams along with a parent to a “DX adventure” for training and operating from a distant location each summer.
Congratulations to Jim Storms on his accomplishments and for his generosity in working with the leaders of tomorrow, today’s youth.
SILENT AUCTION DONATIONS NEEDED!
HAMCATION 2023 RCA YOUNG ACHIEVERS
In February of this year, two RCA Young Achievers were presenters at the Hamcation Youth Forum in Orlando, Florida. The forum was moderated by Carole Perry, WB2MGP, RCA Director and Chairperson of RCA Youth Activities.

Katie Campbell, KE8GTT, spoke excitedly about “The ABC’s of a YL in STEM, School Amateur Radio Clubs, and Code Coaching.” Katie is a great role model for young ladies (YLs) in amateur radio.
Seamus Bonte KE8GTT gave a great presentation about “Getting Young Hams Involved in the Hobby.” Seamus has spoken at several of Carole’s Youth Forums around the country and hopes to pursue a technical career choice in college.
The purpose of RCA’s Youth Activities Program is to foster school aged youth interest in wireless communication technology, and encourage their future career in wireless. To pique the interest of youth, RCA’s Youth Activities Program uses amateur radio as a vehicle to introduce wireless concepts. For more information, please visit the RCA website
The RCA banquet Silent Auction returns in 2023! The Silent Auction historically offered a wide range of unusual donations, the sale of which benefited RCA. Absent for some time, this favorite activity has returned. To date, we have received notice that some unusual and rare historical items will be available. Other non-wireless items will also be available. We encourage all attendees to consider bringing a donation, and we ask everyone to participate in helping to raise funds for RCA.
Please send your donation information to info@radioclcubofamerica.org.
PROCEEDINGS • SPRING 2023 WWW.RADIOCLUBOFAMERICA.ORG 97
RCA NEWS
Jim Storms (l) and Carole Perry (r).
Katie Campbell (l) and Carole Perry (r).
Dr. Ulrich Rohde Receives the 2023 IEEE Communications Society Distinguished Industry Leader Award
Dr. Ulrich L. Rohde is the recipient of the 2023 IEEE Communications Society Distinguished Industry Leader Award for contributions and leadership in radios and electronic test-measurement equipment that has supported the design of modern communication systems and their industrial implementations. Dr. Rohde is a member and Fellow of the Radio Club of America and received RCA’s Lifetime Achievement Award in 2017.
IEEE AND THE AWARD
The Institute of Electrical and Electronics Engineers (IEEE) Communications Society (Comsoc) recognizes an industry executive whose leadership has resulted in major and outstanding advances and new directions in the information and communications business.
The award recognizes an information or communications industry executive who has played a major leadership role in research or development and the introduction of systems, devices, applications or services that have significantly impacted the communications and information markets on a global basis.

Recipients have substantially advanced the use of information and communication technologies in industry, commerce, and society by providing executive leadership resulting in major advances and new directions in the information and communications business area. Considerations in selecting award recipients include the global acceptance of products and services, financial success and growth of the business, ubiquity of the products and services, emulation of the contributions by the competition, and the degree of the candidate’s global recognition. Other considerations include time of service, impact, and specific innovations.
DR. ULRICH ROHDE

Dr. Rohde is a Partner of Rohde & Schwarz, Munich Germany; Chairman of Synergy Microwave Corp., Paterson, New Jersey; President of Communications Consulting Corporation; serving as an honorary member of the Senate of the University of the Armed Forces Munich, Germany honorary member of the Senate of the Brandenburg University of Technology Cottbus–Senftenberg, Germany.
Dr. Rohde is serving as a full Professor of Radio and Microwave Theory and Techniques at the University of Oradea and several other universities worldwide, including Honorary Professor IIT-Delhi, Honorary Chair Professor
IIT-Jammu, Professor at the University or Oradea for microwave technology, a honorary professor at the BTU CottbusSenftenberg University of Technology, and professor at the German Armed Forces University Munich (Technical Informatics).
Dr. Rohde has published more than 400 scientific papers, co-authored more than a dozen books, with John Wiley and Springer, and holds over four dozen patents. He has received numerous awards, including the 2022 IEEE Photonics Society Engineering Achievement Award, 2021 Cross of Merit of the Federal Republic of Germany, 2020 IEEE Region 1 Technological Innovation Award, 2019 IETE Fellow Award, 2019 IEEE CAS Industrial Pioneer Award; 2017 RCA Lifetime Achievement Award, 2017 IEEE-Cady Award, 2017 IEEE AP-S Distinguish Achievement Award, 2017 Wireless Innovation Forum Leadership Award, 2016 IEEE MTT-S Applications Award, 2015 IEEE-Rabi Award, 2015 IEEE Region-1 Award, and 2014 IEEE-Sawyer Award.
In December 2022, the Indian National Academy of Engineering (INAE) inducted Dr. Rohde as a fellow during ceremonies for “outstanding contributions to engineering and also your dynamic leadership in engineering domain, which have immensely contributed for the faster development of the country.” Dr. Rohde is only the third foreign fellow elected by the INAE, preceded by Dr. Jeffrey Wineland, who won a Nobel Prize in Physics.
PROCEEDINGS • SPRING 2023 WWW.RADIOCLUBOFAMERICA.ORG 98
RCA NEWS
Dr. Ulrich Rohde

PROCEEDINGS • SPRING 2023 WWW.RADIOCLUBOFAMERICA.ORG 99 Save the Date! 2023 Technical Symposium and 114th Awards Banquet SATURDAY, NOVEMBER 18, 2023 DENVER, COLORADO
Wireless Infrastructure Association (WIA) and Radio Club of America (RCA) Announce New Partnership

On Nov. 28, 2022, The Wireless Infrastructure Association (WIA) and the Radio Club of America (RCA) announced a new partnership designed to further the goals of both organizations through RCA’s participation in WIA’s annual Connect (X) trade show and through utilization of WIA’s dynamic online learning program, the Telecommunications Education Center (TEC).

PARTNERSHIP
“WIA, through its Connect (X) trade show, brings together the major infrastructure ecosystem players that make 21st Century ubiquitous wireless connectivity available to all,” said WIA’s Vice President of Partnerships and Development, Jason Nelson. “RCA’s strategic initiatives in investing in youth and women, wireless education, and mentoring assistance to those starting wireless careers align exactly with WIA’s strategic goals, and we are thrilled to have them at this year’s Connect (X) in New Orleans (May 8-10, 2023). We look forward to working with RCA on these and other initiatives in the future.”
Former RCA President John Facella said, “WIA is an excellent partner for RCA, because WIA represents the important future of wireless in 5G and 6G technologies. RCA has always been at the forefront of developments in wireless, and our partnership with WIA will help to continue that. WIA has a wonderful wireless training library in their Telecommunications Education Center (TEC), which will be available to RCA members. This will help facilitate RCA’s important initiatives in education, mentoring, and career development. RCA welcomes WIA as a new partner.”
WIA AND CONNECT (X)
WIA represents businesses that build, develop, own, and operate the nation’s wireless infrastructure. WIA advocates for the widespread, responsible deployment of wireless infrastructure to enable mobile broadband for communities everywhere.

Connect (X) is the only business technology event in North America that unites the industry stakeholders who deliver infrastructure solutions for ubiquitous connectivity. As the connectivity industry continues to develop and devices evolve with more computing power, the focus shifts to the infrastructure to support 5G. The next wave of deployment will require an expanded community of network infrastructure – public and private – to usher in a new era of universal broadband applications and services to anyone, anywhere, in real-time.
For additional information about the partnership, contact Amy Beckham at RCA: 612.405.2012, amy@radioclubofamerica.org or WIA: Marshall Miller 717.951.0795, marshall.miller@wia.org.
PROCEEDINGS • SPRING 2023 WWW.RADIOCLUBOFAMERICA.ORG 100
RCA NEWS The RCA website is the go-to place for RCA news and events. TROUBLE LOGGING IN? Please email Amy@radioclubofamerica.org if you need a new password or have difficulty logging in. RADIOCLUBOFAMERICA.ORG FRESH CONTENT – ON THE –RCA WEBSITE
Radio Club of America Focusses on Marketing in 2023




The Radio Club of America is revamping its look and sharpening its message. RCA is focusing on getting the message out about our networking opportunities and the quality of our membership. In the first four months 2023, we have:
• Drafted and issued new marketing brochures
• Created business cards with QR codes and contact information
• Drafted new media kits that should be ready in early May 2023
• Increased our presence at trade shows
• Updated the look of our website, especially the opening pages; more work will be done on the website in the summer
• Linked our internal accounting functions to membership services to streamline our member’s contact points with RCA
Our new message is straightforward: we are focusing on the quality of our members. You are our value!! RCA brings together professionals and non-professionals from every segment of the wireless industry. RCA promotes the exchange of ideas across boundaries by providing a stimulating intellectual and social environment for our members. We bring together the best in wireless; free from commercial constraints, academic and professional limitations, and industry or association politics. We are not an advocacy organization, although many of our members have created new wireless industries and regulations. With a vision focused on the future while honoring the past, RCA strives to encourage, educate, and engage students of all ages and professionals in a myriad of wireless careers. Look for many more updates and new initiatives in 2023!! We hope to have a new store available by late summer, just in time for fall holiday purchases!


The RCA board undertook this effort beginning in 2022 under then president John Facella, producing a new logo and a commitment to modernize the marketing concept for RCA. Current President David Bart is focusing on developing new messaging and redefining our presence in the marketplace.
Throughout 2023, we will be evaluating our trade show performance. Certain shows will be dropped in 2024, and new ones added. This review process began in late 2023; however, we did not feel 2023 was a good year to reach decisions after emerging from the Covid pandemic. We added Connect (X) in 2023. We are interested in adding more shows for 2024. If you are interested in having RCA attend a new show, please contact Amy Beckham at amy@ radioclubofamerica.org or David Bart at jbart1964@gmail. com to discuss opportunities and sponsorship of RCA’s costs.


PROCEEDINGS • SPRING 2023 WWW.RADIOCLUBOFAMERICA.ORG 101
RCA NEWS RADIO
AMERICA
Amy Beckham Administrative Director amy@radioclubofamerica.org 7042 East Fish Lake Road Maple Grove, MN 55311 Phone: 612.405.2012 Fax: 612.430.6995 RCA’S MISSION: The Radio Club of America promotes the cooperation of those interested in scientific investigation in the art of Radio Communication. With a vision focused on the Future while honoring the Past, RCA strives to encourage, educate, and engage students of all ages and professionals in a myriad of wireless careers. NETWORKING RECOGNITION EDUCATION YOUTH PROGRAMS RADIO CLUB OF AMERICA VALUE FOR OUR MEMBERS www.radioclubofamerica.org www.radioclubofamerica.org www.radioclubofamerica.org RCA promotes the exchange of ideas across boundaries by providing a stimulating intellectual and social environment for our members. We bring together the best in wireless; free from commercial constraints, academic and professional limitations, and industry or association politics. We are not an advocacy organization, although many of our members have created new wireless industries and regulations. RCA brings together professionals and non-professionals from every segment of the wireless industry www.radioclubofamerica.org NETWORKING • RECOGNITION • EDUCATION • YOUTH PROGRAMS RADIO CLUB OF AMERICA Two new brochures focus on RCA’s value offering: trifold (left) and booklet (right). If you would like copies for use at trade shows or for marketing, please contact Amy Beckham. HAS YOUR CONTACT INFORMATION CHANGED? If you have recently changed your address, email, or phone number, please login to your membership page on our website to update your information, email amy@radioclubofamerica.org or call (612) 405-2012.
CLUB OF
RCA brings together professionals and non-professionals from every segment of the wireless industry
Radio Club of America Has a New Look and Attends Numerous Spring 2023 Shows
The Radio Club of America is sporting a new look and new energy at industry trade shows. In spring 2023, RCA participated in Hamcation, NATE, IWCE, Connect(X), Hamvention, and UTC. We are also in the process of coordinating a fall lineup of shows for 2023, especially WCA and APCO.

Our sharper presence was noted, and we experienced a significant uptick in visitor traffic at our booths. We thank all our volunteers, and we welcome our new members, both individual and corporate.
Our fresh look includes new marketing brochures, bright colors, and slide shows with video, and uniform shirts featuring our new logo. We experienced active traffic, and IWCE was our best showing in many years, bringing in two new corporate members and many new individual memberships.
The IWCE breakfast program had 60 people, our largest in many years. RCA presented an update on its activities
with all RCA board and committee members and former presidents participating.
Our themes are focusing on RCA’s networking opportunities and the quality of our membership. RCA brings together professionals and non-professionals from every segment of the wireless industry. RCA promotes the exchange of ideas across boundaries by providing a stimulating intellectual and social environment for our members. We bring together the best in wireless; free from commercial constraints, academic and professional limitations, and industry or association politics. We are not an advocacy organization, although many of our members have created new wireless industries and regulations.
With a vision focused on the future while honoring the past, RCA strives to encourage, educate, and engage students of all ages and professionals in a myriad of wireless careers.
PROCEEDINGS • SPRING 2023 WWW.RADIOCLUBOFAMERICA.ORG 102
RCA
NEWS
RCA’s new booth and volunteers at IWCE: (Standing L-R) Ernie Blair, Charles Kirmus; (Seated L-R) David Bart, Stan Rubenstein, Amy Beckham.
Candids from IWCE











PROCEEDINGS • SPRING 2023 WWW.RADIOCLUBOFAMERICA.ORG 103
RCA NEWS
Radio Club of America Announces New Free Training Module “Introduction







On Dec. 20, 2022, the Radio Club of America released, free to the public, its new training module: “Introduction to Wireless.” This training module, which is a PowerPoint™ slide deck, provides basic information about the wireless industry, the jobs available in the industry, education needed for those jobs, and some website references that list wireless jobs.

Former RCA President John Facella said “Wireless is a ubiquitous technology upon which modern life is dependent. Yet many take wireless for granted, and don’t consider it as an exciting career possibility. One purpose of this training module is to explain to high school and college students, their parents, and guidance counselors, what this industry is all about, and how someone might get into the industry.”
RCA President David Bart said “There is a major shortage of qualified people to work in the wireless industry. However, not all jobs are just for engineers or technicians. There are many other jobs in sales, marketing, manufacturing,





















education, legal, real estate, all of which impact wireless. This training module explains that, and the basic requirements needed to qualify for these jobs. We hope that this training will help people to consider joining our industry.”


The slides can be found on the RCA website by going to: https://www.radioclubofamerica.org/Careers and then clicking on the red bar “Introduction to Wireless”. In the future, the slides will also be available (at no cost) as a series of short videos.

PROCEEDINGS • SPRING 2023 WWW.RADIOCLUBOFAMERICA.ORG 104
to Wireless” RCA NEWS New RCA Training Program. Join a global network of 29,000+ communications technology professionals! www.comsoc.org/membership RADIO CLUB OF AMERICA Please remember Radio Club of America in your wills and trusts. Call us at 612-405-2012 or visit radioclubofamerica.org to learn more about legacy giving and bequests. www.radioclubofamerica.org Follow us! Radio Club of America, 13570 Grove Dr. #302, Maple Grove, MN 55311 612-430-6995 HELP US ENSURE RCA’S WORK FOR FUTURE GENERATIONS
Our Commitment To Education For All Ages
The AWA is actively engaged in education for all age groups. For over 70 years, we have preserved and shared the history of technologies used to communicate from the first telegraph message to today’s wireless text messaging. AWA is now committed to educational outreach leveraging our world renowned collection of artifacts and papers, the Antique Wireless Museum, the AWA publications, and the incredible knowledge base of our members, Museum Staff, and friends.
ANTIQUE WIRELESS MUSEUM
The Museum welcomes 2000 guests annually to tour the 8400 square feet of exhibits displaying the 200 year history of communication technologies. The educational experience for the general public is enhanced by Museum Historian led tours where the stories associated with the artifacts bring Bakelite and brass and wood alive. These visitors range in age from busloads of primary students to busloads of seniors. Young or senior, the visit to the Museum is always an educational experience.

AWA “STEM” CLASSES
Radio Fab Lab (the AWA Science Technology Engineering Mathematics classes) were developed to introduce students age 8 to 13 to a wide range of science including communication technologies by leveraging the Museum Staff’s technical knowledge base and various exhibits in the Museum. We ask that an adult (parent, grandparent, aunt, uncle, etc) attend the classes with the student. That was to support/reinforce the learning process, to afford them “quality” time with the student, and to afford them an education opportunity as well. We had a grandmother come for one class
with her grandson and she had a super time. She was the star of the group.
The nine, two-hour classes conducted in the Museum were generally structured with a presentation of history/theory/concepts that was reinforced by a practical student construction of a related project that the students took home or used as a demonstration. AWA provided all the materials necessary for the projects including a modest tool kit that was the student’s to keep.
To date, we have had almost 100 students attend the RFL Classes, the last being in early 2020 before COVID. We will be restarting those classes soon.
AWA IN THE PUBLIC SCHOOL CLASSROOM
Based on a meeting with the Superintendent at Bloomfield CSD, AWA was invited to teach “Waves” to the 3 fourth grade classes at BCSD. The New York standard curriculum had added a waves segment. I taught the 3 classes (60 students) at school and then the classes were bused to the Museum for a segment of building a code practice oscillator (CPO) and learning four letters of Morse Code. They were given the CPO to take home with them.
AWA received two grants to develop a mobile amateur radio station based in a cargo trailer that allow AWA to go the schools rather than depend on the schools being able to bring the students to the Museum. Our plan is to make the “mobile unit” multifunctional to be used in support of a variety of STEM related topics. This mobile unit would support outreach to rural school systems that lack resources or the availability for opportunities of larger school systems. For a rural school, travel time to the
Museum could be one hour, one hour at the Museum and one hour back to school means a commitment of a whole afternoon. If AWA goes to the school, it means the AWA special class only takes one school period for the students. We are now “rolling out” the Educational Amateur Radio Station Program.
LEARN IT, BUILD IT, FIX IT CLASSES
There are currently three topics in this series for adults - Tube Based Guitar Amplifiers, Tube Based Audio Amplifiers and Tube Based Radio Repair. During 24 hours of theory and practical construction/repair projects in the classes, students can build a tube based kit or repair a project of their choosing. The classes are small by design and the students are assisted by the instructors as they work on and complete their projects. To date, 53 students have attended LIBIFI classes.
SHARING COMMUNICATION HISTORY AND TECHNOLOGY AS EDUCATION
For over 70 years, AWA has a done a remarkable job of preserving and sharing history and we will always continue that all important role. If history is lost, it is lost forever. In addition to our important commitment as a responsible steward of history, AWA is also committed to leveraging our knowledge base and skills, our collections, our talents to try to provide a “spark” to a student or a visitor that leads them to a STEM related career or to carry on the torch of stewards of communication technologies.
Robert Hobday N2EVG AWA President and Chairman of the Board
PROCEEDINGS • SPRING 2023 WWW.RADIOCLUBOFAMERICA.ORG 105
www.antqiuewireless.org
RCA NEWS
RADIO CLUB OF AMERICA INTERVIEW SERIES
TUESDAY 13 JUNE, 9-20 PM EDT
Engineering Personnel from WWV and WWVH
The interview will be with two experts from the NIST stations: Matt Deutch and Glenn Nelson.
As many know, the National Institute of Standards and Technology (NIST) run by the U.S. Government includes a number of standard time and frequency transmitting stations. NIST is an agency of the U.S. Department of Commerce. These stations include WWV, WWVL (20 kHz) and WWVB (60 kHz) in Boulder and Ft. Collins CO, and WWVH in Hawaii. The system began regular transmissions in 1923 in the Washington DC area, and has had a long history of improvements and relocations. During the interview, we will delve into the history, how the stations are configured, and how accurate the standards are that are used. For those that are interested, attached is a detailed 31 page history of the stations that was written by Glenn Nelson, which may answer many questions.
Matt Deutch, is an electrical engineer working at WWV and WWVB since 1989. Matt graduated from Colorado State University. He received further electronics training in the US Coast Guard. Matt is also a licensed radio amateur N0RGT.

Glenn K. Nelson has been an electronics technician at WWV and WWVB since 1997. He has worked in military and government broadcasting for 38 years. Glenn is an expert on the history of the stations. He is also a licensed radio amateur, AE0GF

Save the Date!
2023 Technical Symposium and 114th Awards Banquet
SATURDAY, NOVEMBER 18, 2023 | DENVER, COLORADO

PROCEEDINGS • SPRING 2023 WWW.RADIOCLUBOFAMERICA.ORG 106
REGISTER NOW!
SILENT KEYS
Silent key is a term of respect for a deceased amateur radio operator. The key in the term refers to a telegraph key, the instrument that all early amateur radio operators, as well as many contemporary amateur radio operators, used to send Morse code. The term SK is used in telegraphy to indicate an end of transmission. Today, the term is commonly used within the radio community as a sign of respect and condolence, regardless of whether the deceased was an amateur radio operator.
CHARLES REARDON BEJCEK
Charles Reardon Bejcek, 83, of Carrollton, Texas, passed away on December 19, 2022 in Plano. Chuck was born in 1939 in Phoenix and was the first of three boys. The family moved to San Gabriel, California in 1944 where he graduated high school in 1957. After the family moved to San Francisco, Chuck attended Menlo College, studying International Relations, until the family moved to Dallas in 1959. He served in the U.S. Airforce from 1960 to 1963, who sent him to Yale University to learn Mandarin and become an interpreter for the USAF. He later joined the ROTC after being honorably discharged from the USAF and resigned his commission with the ROTC program in 1968. Chuck worked in the communications industry at Motorola until 1976. He then became an independent representative for Gentry Marketing until starting his own communications company, Comquip, with his father in 1981. Chuck joined Carroll Hollingsworth, a close friend, at DH Marketing and remained with them until his passing.

THOMAS R. POOR
Thomas R. Poor, RCA Fellow 1990, passed away on Dec. 8, 2022. He was born in 1925 and had just turned 97. Tom was a World War II U.S. Navy Veteran and served on the Command Ship USS MT Olympus for the Japanese Surrender in Tokyo Harbor. Tom worked for Pacific Telephone in 1949 and was a technician on the Route 99 experimental mobile phone system for PT&T. Tom Started Bakersfield Electronics (later named Communication Enterprises “CEI”) in 1951 to serve the mobile communication needs of the San Joaquin Central valley. Tom worked on such radios as Link, RCA, Midland, and became a GE manufacture representative and dealer in 1955. Between 1972 and 1986, CEI was a GE top-10 national dealer for 13 out of the 14 years. Tom is survived by his wife of 73 years Alberta, 4 daughters, and 2 sons. All of his children at one time were in the wireless communication business in some form. CEI is still run by his youngest son Paul, an RCA member.


OLIN GLENN SHULER
Olin Glenn Shuler, age 92, of Quincy, Illinois, passed away Dec. 21, 2022, in Quincy. He was born in 1930 near Hettick, Illinois. As a longtime member of Radio Club of America, he recieved the Fred M Link Award related to his contributions toward the first production of the first Motorola FM automobile radio. Olin worked at Motorola for 40 years in the consumer products division and tested the first transistor OEM radios supplied to Ford, Chrysler, and American Motors. He worked on designing the first Motorola FM automobile radio and first eight-track-tape player for aftermarket sales. He was a registered Professional Quality Engineer and a Fellow of the American Society for Quality. He held both amateur and commercial FCC radio operator licenses. He was president of Antique Radio Club of Illinois between 2011-2014, president of the local Quinsippi Section – ASQ and a Member of ARRL. He was a member of the Silver Dollars Square Dance Club, Great River Genealogical Society, Great River Jazz Preservation Society, Antique Radio Club of Illinois, Mid-America Antique Radio Club, Antique Wireless Association, and Radio Club of America.
Donald Whitney passed away Dec. 28, 2022. Don enjoyed a long tenure in public safety. He joined Motorola in 1973 in public safety communications, eventually working in many markets for the next 34 years. He was active in APCO including service on the board of directors. He was honored by APCO in 2015 for a lifetime of APCO services as a recipient of the Jack Daniel Award of Distinction. Don was a long-time member of the Radio Club of America, where he was elevated to Fellow in November 2021.


PROCEEDINGS • SPRING 2023 WWW.RADIOCLUBOFAMERICA.ORG 107
DONALD WHITNEY
OPPORTUNITIES TO SUPPORT RCA
The Radio Club of America provides many opportunities to support the organization and its activities. Sponsors can make specific requests or provide funding for general operations.
INDIVIDUAL SUSTAINING DONATIONS
Make a difference in how quickly we progress with our many initiatives for young people, young wireless professionals and those in established careers. We encourage any member who is impressed with the operations of the club to make a tax-deductible donation earmarked to sustaining operations. Donations to support our day-to-day operations are critical to our future as an organization. You can also select RCA as your full or partial beneficiary on an IRA, so funds are tax-free to RCA, or set up a monthly donation through a credit card or ACH withdrawal.
CORPORATE SPONSORSHIPS AT SPECIFIC EVENTS
Networking is a key reason many of our members get involved and stay active with RCA. Breakfasts, cocktail parties and other social events can be underwritten by sponsors who receive promotional considerations for their donations and heightened visibility to the membership.
3 YEAR SUSTAINING CORPORATE SPONSORS
There is a unique set of advantages to corporate sponsors who participate in our three-year program. See our summary of benefits by level of sponsorship.
SCHOLARSHIPS
Donate to an existing scholarship fund or create your own and you will be supporting university students pursuing wireless communications as a career.

YOUTH ACTIVITIES
The Youth Activities program brings the excitement of learning about amateur radio and vivid lessons in science, math and electronics to middle and high school children in this unique and innovative program sponsored by RCA.
HOW YOU CAN APPLY YOUR DONATIONS
A variety of funds are available to support specific goals of the initial donors and RCA operations. Please contact RCA for more information on these opportunities.
• General Club Operations (unrestricted)
• Archive Preservation
• Barone-DiBlasi-Facella
• Biggs
• Brownson
• DeMello Award
• Continuing Education
• Dettra, Finch
• General Grants in Aid
• Goldwater
• Grebe
• Gunther
• Legacy Fund
• Link
• Meyer
• Meyerson
• Poppele
• Tom Sorley Memorial Fund to RCA
• Youth Activities
• Richard G. Somers Youth Edu Fund
RCA is classified as a 501(c)(3) organization under IRS rules. Contributions may be tax deductible in the United States depending on a person’s individual tax situation.
HOW TO SPONSOR/DONATE
The RCA donations form is on the website. Please contact our Executive Secretary, Amy Beckham, for more information on any of these opportunities. She can be reached at 612.405.2012 or amy@radioclubofamerica.org
PROCEEDINGS • SPRING 2023 WWW.RADIOCLUBOFAMERICA.ORG 108
CALL FOR PAPERS & EDITORIAL COMMENTS
The Proceedings of the Radio Club of America is known for bringing you a wide mix of papers, ranging from sophisticated technical material to historical surveys of subjects related to electronic communications. RCA also is known for fostering discussion and sharing the viewpoints of its members. RCA is therefore issuing a call for papers and editorial comments for publication in upcoming issues of the Proceedings
The Proceedings is published semi-annually, and has been issued since 1914. The Proceedings is considered to be the first publication geared to promoting and sharing the intellectual development of all aspects of radio and wireless communications. Coverage has expanded to include relevant articles encompassing science, technology development, marketing and regulatory topics. We seek articles from knowledgeable engineers, professionals, academics and amateurs who are participating in building future applications, as well as those who want to document the history of relevant technologies.
As a fellow reader of the Proceedings, we would like you to author an article or editorial for publication. We welcome “early work,” even if it is still in the process of being drafted. RCA offers a unique opportunity for you to get an early reaction to important work now underway in wireless communications. It is also a unique opportunity to air your views, inviting commentary and response from the membership.
We seek interesting or important technical articles, editorials and discussion pieces in any of the following areas:
• Antennas and supporting structures (i.e., towers)
• Broadband communications
• Broadcast
• Cellular telephony
• FirstNet
• Ham (amateur) radio
• Land mobile radio
• Long-Term Evolution (LTE)
• Military communications
• Regulatory topics
• Robotics
• Satellites
• 4G/5G Cellular
• Semiconductors, LED or other devices supporting wireless communications

• Any other wireless/radio technologies
Please submit an abstract (1-3 paragraphs) including the title, author(s) and contact information, a synopsis of the material to be published, and a note as to why you think the subject is interesting or important to the wireless industry. Authors of papers selected for publication in the Proceedings may be given an opportunity to present at one of the RCA’s upcoming events, such as the annual Technical Symposium. (Note: participants are responsible for their own travel expenses to RCA events.)
Please send abstracts for articles and editorials to be published in the Proceedings to: John Facella at pantherpinesconsulting@gmail.com with copies to David Bart at jbart1964@gmail.com.
Please send abstracts for potential presentation topics at RCA events to: John Facella at TechSymp2018@radioclubofamerica.org.
For general questions about RCA, an article idea or submission, please contact Amy Beckham at Amy@radioclubofAmerica.org.
PROCEEDINGS • SPRING 2023 WWW.RADIOCLUBOFAMERICA.ORG 109
RADIO CLUB OF AMERICA
READY TO INVEST IN THE FUTURE?
Thanks to our sleek new RCA website, opportunities to host innovative virtual programs and more new ways to connect with RCA members, being an RCA sponsor is a better-than-ever investment in the future.

Details are coming soon. If you can’t wait, contact Karen Clark, Sponsor Committee Chair at kjclark33@comcast.net to get a sneak peek!
The Annual RCA Awards Banquet is the premier industry event to honor exceptional achievements by those who devote themselves to wireless communications. The event also showcases the achievements of middle and high school students involved in the RCA Youth Activities Program. Through your sponsorship your Company will receive: Recognition, Logo Visibility, Opportunity to reach a targeted market of Technical Executives, not to mention…your Sponsorship makes it possible for us to keep this event affordable for attendees and shows your support for our industry’s finest performers—both established and up-and-coming— whose invention, ingenuity and dedication benefit us all.
Logos on event banners at Tech Symposium and Banquet
Logo on Banquet PowerPoint
Logo in commemorative Banquet program
Logo and URL on RCA website
Full page ad in Aerogram and Proceedings (full membership distribution)
Company logo on signage supporting Young Achievers
Company logo in Proceedings
Inclusion in all commerials and soundbites during Symposium
Branding on all Symposium videos on RCA YouTube channel
Half page ad in Proceedings, logo in Aerogram
Lanyard with logo
Quarter page ad in Proceedings
logo in Aerogram
Table signage
6 tickets to Tech Symposium
Logo on speaker podium
Event signage
Exclusive networking opportunity
Logo on cocktail napkins
VIP cocktail named after you
7’ x 7’ step and repeat backdrop
featuring your logo and RCA logo
2 Banquet and Tech Symposium tickets
Social media branding
The RCA is offering a variety of new sponsorships in 2021 which can give your company recognition and business opportunities. We can also create a custom sponsorship that meets your needs. Radio Club of America is a 501 (c) 3 non-profit organization, therefore, your sponsorship can qualify for a tax-deduction. Please consult with your tax advisor for specific information.
COMPANY NAME (as you would like it to appear in promotional materials):
YOUR NAME ADDRESS
PHONE EMAIL WEBSITE
Special pre- and post event recognition You can pay online at www.radioclubofamerica.org or call Jane Winter @ 781-795-2476 or jwinter@eaa.org for more information, to pay by check or for the specifications for your company logo.
PROCEEDINGS • SPRING 2023 WWW.RADIOCLUBOFAMERICA.ORG 110
SPONSORSHIP BENEFITS GOLD SPONSOR $1,200 SILVER SPONSOR $1,000 BRONZE SPONSOR $500 TECHNICAL SYMPOSIUM LIVESTREAM SPONSOR $2,500 TECHNICAL SYMPOSIUM LANYARD SPONSOR $1,500 MASTER TITANIUM SPONSOR $6.000 NETWORKING LUNCH TITANIUM SPONSOR $6,000 COCKTAIL RECEPTION TITANIUM SPONSOR $6,000 RECEPTION APPETIZER SPONSOR $6,000 PHOTO WALL TITANIUM SPONSOR $6,000 BANQUET WINE SPONSOR $3,000 HYBRID EVENT SPONSOR $5,500
BUSINESS & PROFESSIONAL DIRECTORY
ADVANCED WIRELESS MARKETING
Jack Armstrong, President 200 Warren Road
Cockeysville, MD, 21030
PHONE: (443) 823-5100
jack@advancedwirelessmarketing.com
www.advancedwirelessmarketing.com

Manufacturer’s Representative
ANDERSON-INTELLI-SMART BATTERY DIVISION
KIRMUSS & ASSOCIATES, LLC
Charles Kirmuss, Founder, Principal 51 West 84th Ave., Suite 301 Denver, CO 80260
PHONE: (303) 263-6353
ckirmuss@frontier.net
www.anderson-intellismartbattery.com
Manufacturer of OE and replacement batteries for the two way radio industry. iNTELLi Smart Battery™ technology at lower cost than traditional OE standard batteries.

BLUE WING
Andy Maxymillian, PMP, Principal Consultant
235 Summer Hill Drive Gilbertsville, PA 19525
PHONE: (610) 473-2171
CELL: (610) 316-2660
FAX: (610) 473-2536
andrew.maxymillian@bluewing.com www.bluewing.com
Consultant Services
CAPITAL AREA COMMUNICATIONS

Stephen J. Shaver, Project Manager 4120 Swatara Drive Harrisburg, PA, 17113 PHONE: (717) 561-0800
CELL: (717) 645-0086
FAX: (717) 561-9805
steves@cacradio.com
www.cacradio.com
Wireless Communication Systems Solutions Provider
Would you like to be listed in the next issue of the Proceedings? Contact RCA at (612) 405-2012 or Amy@radioclubofamerica.org to reserve space.
ANTIQUE WIRELESS ASSOCIATION

Robert Hobday, Director
David Bart, Board of Directors
PO Box 421 Bloomfield, NY 14469
PHONE: (847) 542-9873
jbart1964@gmail.com
www.antiquewireless.org

Preserving the Past for Posterity
INFINITY ADVANCED TECHNOLOGIES/WORLDWIDE TECHNOLOGIES DIRECT

A DIV. OF KIRMUSS & ASSOCIATES, LLC, SINCE 1979
Charles Kirmuss, Founder, Principal 51 West 84th Ave., Suite 301 Denver, Co. 80260
PHONE: (303) 263-6353
ckirmuss@frontier.net
www.wwtechnologiesdirect.com
Radio pioneer, Director of RCA and Rampart Search & Rescue: Custom solutions & products for the Public Safety, Search & Rescue and Military markets. Proud supporter & sponsor of RCA’s Youth Program.
KIRMUSSAUDIO DIV OF KIRMUSS & ASSOCIATES, LLC

Charles Kirmuss, Founder, Principal 51 West 84th Ave., Suite 301 Denver, Co. 80260
PHONE: (303) 263-6353
FAX: (303) 862-7170
ckirmuss@frontier.net
www.kirmussaudio.com
LEONARDO
William P. Fredrickson 11300 W. 89th Street
Overland Park, KS 66214
PHONE: (913) 495-2614
CELL: (913) 909-4492
Bill.fredrickson@ leonardocompany-us.com
www.leonardocc.com
Land Mobile Radio Manufacturer: DMR, P25, Tetra
PANTHER PINES CONSULTING
John Facella, P.E., BSEE, MBA, Principal
PHONE: (978) 799-8900
pantherpinesconsulting@gmail.com
www.pantherpinesconsulting.com
Communications & Management Consulting
PROCEEDINGS • SPRING 2023 WWW.RADIOCLUBOFAMERICA.ORG 111
BUSINESS & PROFESSIONAL DIRECTORY

RADIORESOURCE MEDIA GROUP
Paula A. Nelson-Shira, Owner 7108 S. Alton Way, Building H Centennial, CO, 80112
PHONE: (330) 792-2390 x112
FAX: (330) 792-2391
pnelson-shira@RRMediaGroup.com
RRMediaGroup.com
Information leader on wireless communications since 1984.
RFI AMERICAS
Sean Johnson, President 2023 Case Pkwy Twinsburg, OH, 44087
PHONE: (330) 486-0706 x302
CELL: (330) 541-6585
FAX: (330) 486-0705
sean.johnson@rfi.com.au www.rfiamericas.com
Manufacturer of antennas and RF conditioning equipment for LMR
ROYAL COMMUNICATIONS INTERNATIONAL, INC.


Maggie Lynch, President 3135 Coachman Ct. Oceanside, CA 92056
PHONE: (760) 529-9518
sales@royal-communications.com royalcominc.com

Specializing in the sales and service of Barrett High Frequency, Single Sideband transceivers that are dependable and easy to use.
TOWER INNOVATIONS, INC.

Bruce R. McIntyre, President 107 Dunbar Ave., Suite E Oldsmar, FL 34677
PHONE: (813) 818-8766
CELL: (727) 439-3683
FAX: (813) 925-0999 bruce@towerinnovationsinc.com www.towerinnovactionsinc.com
Wireless consulting, Communications structures
RLA COMMUNICATIONS ENGINEERING, LLC

Robert A. Lopez, P.E., President 8305 Bergenline Avenue #9 North Bergen, NJ 07047
PHONE: (973) 449-5249
rlopez@rlacommunications.com
www.rlacommunications.com
A communications engineering consulting company serving public safety and commercial wireless industries.
TSR CONSULTING ®
Dr. Theodore S. Rappaport, P.E., Ph.D PO BOX 888
Riner, VA 24149
Technical consulting, engineering and design services in the field of wired and wireless communications systems, equipment and devices.
MASSIVELY BROADBAND ®
TWR
Lauren Libby, International President
300 Greyson Drive Cary NC 27511
PHONE: (719) 331-7051
llibby@twr.org
www.twr.org

RF and Digital Content to 190 Countries in 230 languages every day
UTILITY TELECOM CONSULTING

GROUP
George R. Stoll, President 9850 S. Maryland Pkwy Las Vegas, NV, 89183
PHONE: (303) 840-2878
CELL: (303) 475-0414
FAX: (303) 840-1129 george.stoll@utcg.com
www.utcg.com
Consulting Engineers
WIRELESS TOWERS, INC.
Larry Shaefer, President
115 N. Walker St. Angleton, TX 77515
PHONE: (713) 522-7000
CELL: (713) 526-8000
Lshaefer@sbcglobal.net
www.wireless-towers.com
Texas Tower Site Leasing
PROCEEDINGS • SPRING 2023 WWW.RADIOCLUBOFAMERICA.ORG 112
RCA CALENDAR EVENTS
CALENDAR
Visit the event calendar on the RCA website for the most up-to-date event information.
RCA EVENTS
INDUSTRY EVENTS
CONNECTIVITY EXPO


May 8–10, 2023 New Orleans, LA
2023 RCA BANQUET AND TECHNICAL SYMPOSIUM
November 18, 2023
Denver, CO
DAYTON HAMVENTION
May 19–20, 2023
Dayton, OH
Do you want to see RCA at more shows? Please drop us a line and help organize an RCA booth. We are ready to come to you!!
UTC TELECOM & TECHNOLOGY

June 5–9, 2023
Fort Lauderdale, FL visit us at booth 827
APCO INTERNATIONAL

August 6–9, 2023
Nashville, TN
SOCIETY OF WOMEN ENGINEERS
October 26–28, 2023 Dayton, OH

DO YOU KNOW SOMEONE WHO WOULD BE A GREAT FIT FOR RCA?

With our new online membership application it’s easier than ever to get involved!
RCA members include inventors, scientists, industry professionals, members of the press, the FCC, government agencies, and world class amateur operators. We were there at the dawn of radio history and are committed to keeping our members up to date on the latest in wireless technology. RCA believes in the future of the industry and your membership will help us with the important work of encouraging the next generation of wireless pioneers and entrepreneurs.
Help spread the word about why you belong, and direct potential members to www.radioclubofamerica.org/join to learn more about the benefits of membership!
PROCEEDINGS • SPRING 2023 WWW.RADIOCLUBOFAMERICA.ORG 113
SHARE YOUR RCA STORY
We had a record number of new members last year help us continue this momentum by spreading the word about why you belong to the oldest, most prestigious group of wireless professionals in the world! Direct potential members to the Why RCA? page of the website to learn what sets us apart.

Signing up for RCA Membership has never been easier! Use the new online membership application to submit your information in a matter of minutes.
SHOP AMAZON & HELP RCA
Amazon has a program called Amazon Smile, through which Amazon will donate .5% of a qualified purchase to a charitable organization of your choice. To designate proceeds towards RCA, go to smile.amazon.com and use your Amazon login. You will be asked to select a charitable organization (Radio Club of America) and start shopping. It is an easy way to help the Radio Club and at the same time get a great deal on amazon.com. If you are an Amazon Prime member, you will continue to receive the benefits of your Prime membership.
HAS YOUR CONTACT INFORMATION CHANGED?
If you have recently changed your address, email, or phone number, please login to your membership page on our website to update your information, email amy@radioclubofamerica.org or call (612) 405-2012.
HEADQUARTERS OFFICE
ADDRESS: 7042 E. Fish Lake Rd Maple Grove MN 55311
PHONE: (612) 405-2012
EMAIL: amy@radioclubofamerica.org
WEBSITE: www.radioclubofamerica.org
PROCEEDINGS • SPRING 2023 WWW.RADIOCLUBOFAMERICA.ORG 114